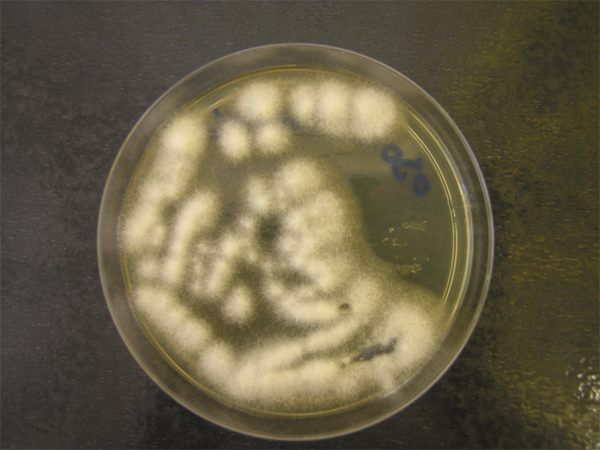
image

Infections de la surface oculaire
T Bourcier, A. Sauer, M. Saleh, A. Dory, G. Prevost, M. Labetoulle
Les kératites bactériennes sont définies par la survenue d’un infiltrat cornéen sous-jacent à un ulcère épithélial au niveau desquels une(des) bactérie(s) est(sont) identifiée(s) par analyse microbiologique et/ou guérit(issent) sous traitement antibiotique adapté. Ces infections correspondent donc à une prolifération de micro-organismes dans la cornée, mais elles comportent également une importante composante inflammatoire qui entraîne une destruction tissulaire. Le principal facteur de risque est le port de lentilles de contact. Une kératite bactérienne, ne présentant ni critère de gravité (règle des « 1-2-3 ») ni signe évocateur d’une co-infection fongique ou amibienne, peut être traitée par une antibiothérapie locale probabiliste dans le cadre d’un suivi ambulatoire rapproché. Dans le cas contraire (présence de critères de gravité et/ou de signes évocateurs d’une co-infection), un grattage cornéen pour examen microbiologique (bactériologique, mycologique, virologique, parasitologique) est à effectuer préalablement à un traitement anti-infectieux renforcé dans le cadre d’une prise en charge multidisciplinaire hospitalière.
Les kératites bactériennes (KB) sont définies par la survenue d’un infiltrat cornéen sous-jacent à un ulcère épithélial d’origine infectieuse avec une atteinte tissulaire résultant de l’inflammation secondaire [1]. Constituant de véritables urgences infectieuses, leur prise en charge rapide est nécessaire afin d’éviter la survenue de complications graves et de séquelles cornéennes parfois synonymes de baisse d’acuité visuelle définitive [2]. L’utilisation très largement répandue des lentilles de contact explique la grande fréquence des KB [3].
Un grand nombre de bactéries aérobies et anaérobies peuvent provoquer une infection de la cornée (tableau 6-1). Cependant, quatre groupes prédominent très largement puisqu’ils sont à l’origine de 90 % des cas de kératites bactériennes : les staphylocoques, les streptocoques, les Pseudomonas et les entérobactéries [4]. Dans la plupart des pays industrialisés, la tendance actuelle est à l’augmentation du pourcentage des bactéries à Gram positif (cocci et bacilles) qui sont isolées dans 70 à 87 % des cas [5–11]. Cependant, les bactéries à Gram négatif sont relativement fréquentes notamment parmi les abcès sous lentilles de contact pris en charge en milieu hospitalier : de 30 à 60 % selon les séries [12–15]. Les KB sont plus rarement polybactériennes (2 à 19 % des cas) [5, 6]. En revanche, les bactéries peuvent être associées à d’autres agents infectieux tels que des amibes ou des champignons notamment chez les patients porteurs de lentilles de contact. Rappelons cependant qu’un abcès de cornée ou une kératite d’allure infectieuse sont bactériens jusqu’à preuve du contraire. Les bactéries sont en effet responsables de plus de 90 à 95 % des ulcères et kératites infectieuses non virales recensés dans les pays industrialisés [16].
Tableau 6-1 Principales bactéries isolées dans les kératites.
La plupart des bactéries impliquées sont des germes de la flore bactérienne conjonctivale, palpébrale, cutanée, nasale (majoritairement à Gram positif), oropharyngée ou digestive (majoritairement à Gram négatif). Les infections post-traumatiques ou postopératoires peuvent être dues à des bactéries d’origine exogène, provenant d’un corps étranger ou de l’environnement. Pour qu’une bactérie puisse se développer dans la cornée, il est nécessaire qu’un ou plusieurs de ses systèmes de défense soient altérés : altération du clignement des paupières, diminution de la sensibilité cornéenne, anomalie du film lacrymal contenant de nombreuses protéines antibactériennes (lysozyme, lactoperoxydase, lactoferrine, bêta-lysine, bêta-défensines, immunoglobulines A sécrétoires, complément), qui inhibent normalement l’adhésivité et la prolifération bactérienne. La présence d’un épithélium cornéen altéré est une condition quasi obligatoire au développement du processus infectieux. Les bactéries adhèrent en effet à la surface épithéliale lésée au niveau des récepteurs aux glycoprotéines par l’intermédiaire d’adhésines non filamenteuses ou de pilis. L’attachement peut se faire également de façon non spécifique par le glycocalix bactérien [4]. Certaines bactéries, comme Staphylococcus aureus, Streptococcus pneumoniae ou Pseudomonas aeruginosa ont de meilleures capacités d’adhésion ce qui explique leur fréquence élevée dans les séries de KB. Les bactéries se multiplient dans l’épithélium avant de pénétrer le stroma cornéen grâce aux toxines et enzymes protéolytiques qu’elles sécrètent. L’augmentation de la population bactérienne est majeure dans les 48 premières heures. En l’absence de traitement, les bactéries progressent jusqu’au stroma profond en élargissant l’ulcère. Les bactéries vivantes sont plus volontiers retrouvées sur les berges et dans le fond de l’ulcère. Les bactéries à Gram négatif sont souvent plus virulentes que celles à Gram positif et sont responsables de lésions cliniques plus importantes [6]. Il semble en outre que les souches et facteurs de virulence des Pseudomonas (sérotypes, profils de protéases, exotoxines, phénotype de formation du biofilm, résistances aux antibiotiques) diffèrent selon que la bactérie est isolée chez un porteur ou un non-porteur de lentilles de contact [17]. L’invasion bactérienne induit une réponse inflammatoire de l’hôte à la fois cellulaire (cellules de Langerhans, lymphocytes, polynucléaires) et humorale. La libération de nombreux facteurs pro-inflammatoires, comme l’interleukine-1 (IL-1) ou le tumor necrosis factor alpha (TNF-α), provoque une vasodilatation et une perméabilisation des vaisseaux conjonctivaux et limbiques suivies d’une extravasation des cellules inflammatoires vers la cornée et les larmes. La voie de signalisation inflammatoire Th17 (IL-17, IL-6) pourrait également être impliquée dans les kératites à staphylocoques et Pseudomonas [18]. Cette réaction inflammatoire débute dès les premières heures de l’inoculation bactérienne. Elle peut être délétère en soi en provoquant une fonte stromale et une nécrose tissulaire.
Certaines bactéries peuvent exceptionnellement infecter la cornée malgré un épithélium intact : Neisseria, Corynebacterium diphteriae, Haemophilus influenzae biogroupe aegyptius, Shigella, Listeria. Elles utilisent pour se faire certaines protéases qui permettent une pénétration intracellulaire.
Leur distribution varie de façon bimodale avec l’âge du patient. Chez le sujet jeune, les lentilles de contact et les traumatismes cornéens, avec ou sans corps étranger, sont le plus souvent en cause. Chez le sujet âgé, les pathologies chroniques de surface oculaire (œil sec, dystrophie bulleuse, trachome, conjonctivites fibrosantes, kératites neurotrophiques, neuroparalytiques, insuffisance en cellules souches limbiques) et les anomalies palpébrales (blépharite, entropion, ectropion, lagophtalmie) sont souvent incriminés [19, 20]. D’autres facteurs de risque peuvent être retrouvés à tout âge : chirurgie cornéenne (greffe de cornée, chirurgie réfractive), immunodépression (diabète, corticothérapie, virus de l’immunodéficience humaine ou VIH, alcoolisme, dénutrition), automédication ou prescription prolongée de collyres (corticoïdes, antibiotiques au long cours). Cependant, le port de lentilles de contact constitue, dans la plupart des séries, le premier facteur de risque [6, 21, 22]. Aucun type de lentilles ne protège des infections. Le risque est majoré en cas de port nocturne ou prolongé, en cas de mauvaise hygiène des mains ou du boîtier, en cas de pathologie cornéenne sous-jacente [23, 24].
L’intensité des signes fonctionnels et cliniques dépend de la virulence de la bactérie et de l’état préexistant de la cornée infectée.
L’interrogatoire du patient retrouve les symptômes d’une atteinte cornéenne : œil rouge douloureux accompagné de larmoiement, photophobie voire blépharospasme. Leur apparition est souvent brutale, parfois progressive sur un œil dont la surface oculaire est déjà pathologique. La baisse d’acuité visuelle dépend de la situation du foyer infectieux par rapport à l’axe optique, de l’inflammation intraoculaire induite, de la présence de sécrétions, et du larmoiement réflexe. L’examen clinique initial peut objectiver un œdème palpébral, une hyperhémie conjonctivale avec cercle périkératique, une ulcération épithéliale prenant la fluorescéine accompagnée d’un infiltrat stromal diffus (kératite) ou localisé (abcès). Le diagnostic de kératite bactérienne est le plus souvent aisé. L’identification du processus est parfois plus difficile en cas d’infection survenant sur cornée pathologique ou en cas de traitement antibiotique préalable. L’examen biomicroscopique apprécie la gravité des lésions cornéennes et l’existence de complications. Il précise ainsi : la localisation ; les dimensions ; la forme ; la profondeur de l’infiltrat ; la régularité des limites ; le nombre d’abcès ; l’épaisseur cornéenne ; la présence d’œdème, d’opacités anciennes, de néovaisseaux actifs ou non, de sécrétions ; les signes d’inflammation du segment antérieur, d’une sclérite, d’une endophtalmie. Tous ces éléments sont consignés sur un schéma détaillé afin de préciser l’existence de critères de gravité (tableau 6-2) lors de la prise en charge initiale et de suivre l’évolution de l’infection sous traitement [4, 25, 26]. L’imagerie OCT (optical coherence tomography) du segment antérieur, en quantifiant l’infiltration stromale (zone hyperréflective), l’épaisseur cornéenne résiduelle, et en détaillant la chambre antérieure, peut constituer une aide à l’évaluation des KB [27].
Dès ce stade, la présence de certaines caractéristiques cliniques et/ou certains facteurs de risque associés permet d’évoquer la bactérie en cause.
Un abcès rond ou ovale, blanc gris, central, à bords nets est évocateur d’infection à cocci à Gram positif (fig. 6-1). Parmi ceux-ci, on retrouve les staphylocoques, présents dans la flore bactérienne normale, qui entraînent des kératites principalement sur des cornées pathologiques (herpès, dystrophies bulleuses, rosacée, sécheresse, allergie) ou dans le cadre du port de lentilles de contact. Les facteurs de risque généraux sont le diabète et l’âge supérieur à 50 ans. Staphylococcus aureus provoque une infiltration à progression rapide avec inflammation modérée de chambre antérieure. Autre cocci à Gram positif, le pneumocoque (Streptococcus pneumoniae) apparaît plus volontiers après un traumatisme cornéen, une dacryocystite ou une chirurgie filtrante. L’abcès est alors rapidement progressif, atteignant le stroma profond, avec hypopion, plis descemétiques radiaires, dépôt endothélial de fibrine (fig. 6-2).
Un infiltrat diffus entouré d’un œdème stromal périlésionnel important qui s’étend très rapidement, en quelques heures, à toute l’épaisseur de la cornée et se complique de segmentite antérieure est évocateur de bacilles à Gram négatif. Pseudomonas aeruginosa (bacille « pyocyanique ») est le plus fréquent d’entre eux (fig. 6-3 et 6-4), notamment chez les porteurs de lentilles de contact. Les autres caractéristiques cliniques de ce germe sont les suivantes : sécrétions mucopurulentes jaune-vert adhérentes à la surface d’un ulcère central grisâtre, « crémeux », rapidement nécrotique ; anneau immunitaire possible vers 72 à 96 heures d’évolution ; hypopion ; fonte stromale ; descemétocèle ; perforation survenant après 3 à 5 jours en l’absence de traitement adapté. Des formes multifocales épithéliales ont été décrites chez les porteurs de lentilles souples hydrophiles [3]. On retrouve également cette bactérie lors des infections nosocomiales (unités de soins intensifs, grands brûlés, coma avec exposition cornéenne, assistance respiratoire, humidificateurs, matériel d’anesthésie). Les Serratia et autres entérobactéries entraînent le même tableau clinique chez des patients généralement porteurs de lentilles de contact.
La kératopathie microcristalline représente une entité clinique à part au sein des kératites bactériennes. L’examen à la lampe à fente retrouve une infiltration stromale blanche à bords cristallins, spiculés (fig. 6-5). L’évolution de cette infection est chronique. Les germes en cause sont nombreux, Streptococcus le plus souvent (S. viridans, S. mitis, S. sanguis, S. salivarius, S. pneumoniae), mais aussi Staphylococcus epidermidis, Peptostreptococcus, Haemophilus aphrophilus, Pseudomonas aeruginosa, Stenotrophomonas maltophilia, Citrobacter, Acinetobacter, Propionibacterium acnes, Mycobacterium fortuitum ou certains champignons comme le Candida. Les bactéries se multiplient dans les espaces interlamellaires sans provoquer de réaction inflammatoire majeure, ce qui permet le développement de cette forme clinique très particulière. La greffe de cornée, l’herpès cornéen, le port de lentilles de contact et les traitements corticoïdes au long cours en sont les principaux facteurs de risque.
Une kératite à mycobactérie atypique survient volontiers à distance d’un traumatisme cornéen et peut prendre différents aspects : zébrure, anneau immunitaire, lésions satellites, kératopathie cristalline.
Une kératite à Nocardia peut survenir après traumatisme cornéen ou chirurgie réfractive. D’évolution lente, l’infection se caractérise par des infiltrats stromaux antérieurs blanc-jaune en tête d’épingle disposés en couronne. Une sclérite accompagne souvent la kératite [28].
Cependant la plupart des signes cliniques de KB sont peu spécifiques, l’observation clinique ne peut en aucun cas se substituer à la réalisation, pour les cas les plus sévères, d’un diagnostic microbiologique au laboratoire. La capacité des ophtalmologistes à prédire les résultats du diagnostic microbiologique (grattage cornéen), en cas de kératite infectieuse présumée, a été estimée à seulement 65 % pour Pseudomonas et 48 % pour les autres bactéries [29].
Tableau 6-2 Critères de gravité d’une kératite bactérienne*.

Fig. 6-1 Abcès à Staphylococcus aureus chez une porteuse de lentilles de contact.
Abcès de petite dimension mais situé dans l’axe optique, hypopion réactionnel.

Fig. 6-2 Abcès à Streptococcus pneumoniae après traumatisme cornéen.

Fig. 6-3 Abcès à Pseudomonas aeruginosa chez une porteuse de lentilles de contact.
Ulcération épithéliale, infiltration stromale, hypopion réactionnel.

Fig. 6-4 Abcès pancornéen à Pseudomonas aeruginosa chez un sujet âgé, ulcère de jambe à Pseudomonas concomitant.

Fig. 6-5 Kératite microcristalline à Streptococcus mitis.
Un examen microbiologique doit être effectué en cas de kératite présumée bactérienne comportant un ou plusieurs critères locaux de gravité et/ou en cas de suspicion de kératite amibienne ou fongique associée. Il permet d’identifier et de tester la sensibilité aux antibiotiques de la ou des bactéries responsables de l’infection. En pratique, les prélèvements microbiologiques devront être réalisés en urgence.
Le grattage cornéen est le prélèvement de référence. Il est effectué par un ophtalmologiste, à la lampe à fente ou au bloc sous microscope opératoire après anesthésie topique par collyre unidose sans conservateur. Le port de gants stériles sans talc est obligatoire en cas d’utilisation concomitante de techniques de biologie moléculaire : polymerase chain reaction (PCR) Acanthamœba, recherche de virus. L’utilisation d’un kit de prélèvement standardisé permet un examen microbiologique complet du produit de grattage cornéen (fig. 6-6). Les prélèvements doivent si possible être effectués avant tout traitement anti-infectieux local ou après fenêtre thérapeutique. Le grattage concerne la base et les berges de l’abcès après élimination des débris nécrotiques et fibrineux. Ce débridement mécanique de l’abcès constitue en outre le premier temps thérapeutique puisqu’il permet de diminuer la charge bactérienne et d’augmenter la pénétration des antibiotiques. L’ensemencement doit être réalisé, dans la mesure du possible, par l’ophtalmologiste lui-même. Un premier prélèvement est fait sur une lame porte-objet pour examen direct suivi de l’ensemencement de milieux de culture utilisés pour la recherche de bactéries (gélose chocolat PolyViteX®, milieu Portagerm®, milieu PGY, selon les centres) [3]. Les prélèvements cornéens, ainsi que les éventuels boîtiers, lentilles de contact et flacons de collyres usagés récupérés doivent être apportés dans l’heure au laboratoire de microbiologie. L’examen direct après coloration au May-Grünwald-Giemsa (MGG) lent ou de Gram permet une réponse rapide : présence ou absence de bactéries, cocci ou bacilles à Gram positif ou négatif. L’étude cytologique des cellules inflammatoires du grattage peut donner une orientation diagnostique en montrant des polynucléaires neutrophiles en cas d’infection bactérienne [3]. La présence de bactéries en culture est décelée dans les 24 à 72 heures suivant le prélèvement, sauf en cas d’organismes à croissance particulièrement lente (Propionibacterium acnes, certaines corynébactéries, mycobactéries, bactéries déficientes) ou lorsqu’un traitement antibiotique a déjà été effectué. Un antibiogramme adapté au(x) germe(s) identifié(s) est délivré dans les 48 à 72 heures. Il permet de tester in vitro la sensibilité de la bactérie aux antibiotiques (fig. 6-7). L’interprétation des concentrations minimales inhibitrices (CMI), catégorisées « sensible », « intermédiaire » ou « résistant », est toutefois peu pertinente s’agissant de traitements antibiotiques topiques par collyres, car les concentrations circulantes d’antibiotiques obtenues après administration systémique, servant de base à l’interprétation des CMI, sont bien inférieures. L’antibiogramme permet cependant de guider le choix thérapeutique en évitant des antibiotiques dont les CMI sont élevées pour la souche isolée [3]. Le grattage cornéen permet d’identifier la ou les bactéries en cause dans 56 à 83 % des cas [5, 6, 9, 12, 13, 15, 30–32]. Le taux de grattages « positifs » est de 41 à 58 % en cas de traitement antibiotique préalable [6, 15] et est également diminué de façon sensible lorsque l’anesthésiant local est insuffisamment rincé avant grattage [33].
Les cultures effectuées à partir des lentilles ou des boîtiers sont positives dans 70 à 85 % des cas mais le germe retrouvé, majoritairement bacille à Gram négatif (Serratia, Pseudomonas, Klebsiella, Enterobacter), n’est pas toujours celui responsable de l’infection cornéenne [3, 6, 34].
Le soulèvement du capot est nécessaire pour réaliser l’examen microbiologique en cas d’infection survenant après Lasik (laser in situ keratomileusis).
La mise en culture d’un fil de suture cornéen infecté peut être contributive.
Le frottis conjonctival n’a pas d’intérêt diagnostique sauf en cas de sécrétions importantes et de conjonctivite associée (Neisseriae, Haemophilus, Pneumococcus).
La ponction de chambre antérieure est contre-indiquée car l’hypopion est le plus souvent stérile, « réactionnel », lorsque la membrane de Descemet est intacte. Un tel geste risque en outre d’inoculer le germe cornéen en chambre antérieure.
Une biopsie de cornée doit être envisagée en cas d’infiltration stromale profonde inaccessible au grattage cornéen (kératopathie cristalline, suspicion d’infection à mycobactéries atypiques).
Enfin, le diagnostic microbiologique peut également être réalisé sur bouton cornéen, en cas de greffe à chaud.
Les techniques de biologie moléculaire (real time PCR ou PCR cinétique) devraient contribuer dans les années à venir à améliorer la sensibilité du diagnostic. L’étude des facteurs de virulence des Pseudomonas résistants (gélatinase, élastase, protéase alcaline) par PCR-ERIC (polymerase chain reaction-enterobacterial repetitive intergenic consensus primers) pourrait fournir des informations intéressantes du point de vue thérapeutique et épidémiologique [35].

Fig. 6-6 Kit de grattage cornéen contenant l’ensemble du matériel nécessaire.
Il permet de réaliser un diagnostic microbiologique d’abcès de cornée avec examen direct (lames porte-objets), milieux de culture pour diagnostic bactériologique (gélose chocolat, milieu PGY), diagnostic mycologique (gélose de Sabouraud), recherche d’amibes (gélose enrichie à E. Coli, tube Eppendorf® pour PCR Acanthamœba) et de virus (milieu de transport viral).

Fig. 6-7 Antibiogramme d’un isolat cornéen de Staphylococcus aureus.
Une kératite bactérienne constitue une urgence. L’hospitalisation est nécessaire si un(des) critère(s) de gravité est(sont) présent(s). Les lentilles de contact doivent bien évidemment être enlevées immédiatement même si elles ont un léger effet antalgique au début de l’infection.
Le traitement antibiotique par voie topique est débuté en urgence dès les prélèvements effectués, il est adapté à la gravité des lésions, à l’orientation clinique et si possible aux résultats de l’examen direct [36].
De nombreux collyres antibiotiques sont disponibles en officine ou auprès des pharmacies hospitalières (collyres renforcés) (tableau 6-3). Les collyres renforcés permettent d’obtenir de fortes concentrations cornéennes d’antibiotiques et sont indispensables dans le traitement des kératites bactériennes sévères [37]. Cependant, leur toxicité locale non négligeable (pH acide, hyperosmolarité relative) induit très souvent un réflexe de larmoiement lors de l’instillation, qui a pour effet de diminuer la concentration de principe actif [38]. Ces collyres ne peuvent être délivrés que sur prescription d’un médecin hospitalier. Leur conservation est de courte durée au réfrigérateur (quelques jours à + 4 °C) et plus longue (quelques mois) au congélateur [39].
À l’inverse, les collyres vendus en officine sont, de fait de leur fabrication industrielle, immédiatement disponibles, moins toxiques et tout aussi efficaces pour les abcès de cornée peu sévères [40]. L’utilisation de fluoroquinolones en monothérapie a reçu l’agrément aux États-Unis de la Food and Drug Administration (FDA) et est proposée par de nombreux auteurs [41–44], les études comparatives n’ayant pas montré de différence statistiquement significative avec les collyres renforcés concernant les kératites bactériennes peu sévères. Cependant, il existe un risque d’échec pour les quinolones en monothérapie en raison de phénomènes de résistances bactériennes [3, 10, 45, 46].
Quel que soit l’antibiotique prescrit, renforcé ou non, une « dose de charge » (instillations répétées toutes les 5 à 10 minutes la première heure de traitement) permet d’obtenir rapidement des concentrations cornéennes satisfaisantes. En cas de bi- ou trithérapie, le respect d’un intervalle de 5 minutes entre chaque instillation de collyre est nécessaire. Les collyres sont ensuite prescrits à la posologie d’une goutte par heure pendant 48 heures. Une injection sous-conjonctivale d’antibiotique peut être utile dans les infections évolutives malgré un traitement topique ou en cas de mauvaise observance des collyres. L’utilisation de pommades antibiotiques est à éviter à la phase aiguë de l’infection pour ne pas diminuer la pénétration des collyres. Néanmoins, cette forme galénique a pour avantage d’augmenter le temps de contact cornéen et est particulièrement indiquée chez l’enfant ou en application nocturne, une fois l’infection contrôlée.
Les antibiotiques systémiques (voie intraveineuse ou orale) sont indiqués en cas de perforation, sclérite ou endophtalmie associées.
Il n’existe pas de consensus international concernant les collyres antibiotiques à utiliser dans les KB. Le traitement initial dépend de l’orientation clinique (caractéristiques de l’infection, facteurs de risque associés) et de la gravité des lésions. Les protocoles suivants sont donnés à titre d’exemple.
Pour les kératites bactériennes menaçant la vision (critères de gravité locaux de la règle des « 1-2-3 » présents) :
-
association ticarcilline (6,6 mg/ml) + gentamycine (15 mg/ml) + vancomycine (50 mg/ml) ;
-
ceftazidime (20 mg/ml) + vancomycine (50 mg/ml) ;
-
céfazoline (50 mg/ml) + tobramycine (20 mg/ml) ;
-
céfazoline (50 mg/ml) + ciprofloxacine.
Pour les kératites bactériennes ne menaçant pas immédiatement la vision (critères de la règle des « 1-2-3 » absents) : quinolone ± aminoside ou rifamycine.
En raison de sécrétions parfois abondantes, les lavages oculaires pluriquotidiens au sérum physiologique avec utilisation de compresses stériles sont préconisés. Le lavage quotidien du visage au savon, des mains avec une solution hydro-alcoolique est nécessaire avant l’instillation des collyres. D’autres types de collyres peuvent être administrés selon les besoins : collyres cycloplégiques (en l’absence de contre-indication) à visée antalgique en association avec des antalgiques oraux ; collyres hypotonisants. Le pansement oculaire est à éviter à la phase aiguë de l’infection. Le port de lentilles est contre-indiqué et le traitement d’une pathologie cornéenne ou palpébrale sous-jacente est nécessaire, dans le même temps si possible.
L’antibiothérapie initiale (nature des produits, fréquence d’installation) est ensuite modifiée en fonction de l’évolution clinique, des résultats de l’examen direct, de la culture et de l’antibiogramme. Il est souhaitable de conserver au moins deux antibiotiques actifs sur la bactérie identifiée. La fréquence d’instillation des antibiotiques est généralement diminuée après 48 heures en raison de leur mauvaise tolérance locale et de l’apparition de phénomènes de toxicité. La durée du traitement antibiotique est d’environ 2 semaines pour les kératites bactériennes peu sévères, 4 semaines voire plus pour les kératites plus sévères.
Tableau 6-3 Principaux antibiotiques locaux non associés disponibles en France et utilisés pour le traitement des kératites bactériennes*.
Elle est fondée sur la surveillance de trois processus évoluant de façon parallèle : infection, inflammation, cicatrisation cornéenne. Les paramètres cliniques à évaluer de façon quotidienne ou biquotidienne sont l’acuité visuelle, l’intensité des signes fonctionnels (douleurs), l’infiltrat (taille, profondeur), l’état de l’épithélium et le degré d’inflammation (de surface, intraoculaire).
En cas de sensibilité du germe au traitement, une amélioration doit survenir dans les 24 à 48 heures. On observe alors : une réépithélialisation de la surface de l’infiltrat dont la densité, la profondeur et la surface diminuent ; une régression de l’inflammation conjonctivale et de la chambre antérieure ; des signes fonctionnels. L’évolution dépend de la virulence de la bactérie, de la précocité du traitement mais aussi des moyens de défense du patient. Pour des kératites à Staphylococcus epidermidis, une amélioration clinique survient dans les 24 à 48 heures qui suivent le début du traitement. La guérison est généralement obtenue en 5 à 7 jours. Une kératite causée par une bactérie à Gram positif plus virulente de type Staphylococcus aureus ou Streptococcus peut ne pas s’améliorer pendant 1 ou 2 jours puis guérir rapidement en 10 à 12 jours. L’évolution est plus lente et le pronostic visuel plus mauvais pour les bactéries à Gram négatif. Une tendance à l’aggravation des lésions cornéennes est même possible pendant les 48 premières heures malgré un traitement antibiotique efficace dans les infections à Pseudomonas, qui guérissent beaucoup plus lentement (plusieurs semaines).
Les corticoïdes sont prescrits secondairement une fois la bactérie identifiée, après s’être assuré de l’absence d’infection mycotique ou amibienne associée et sous stricte surveillance en raison du risque de réactivation infectieuse et de possibles retards de cicatrisation épithéliale [47]. L’étude SCUT (steroids for corneal ulcers trial) publiée en 2012 est un essai randomisé en double aveugle, comparant, versus placebo, l’effet des corticoïdes topiques dans la prise en charge des KB. Les 500 patients inclus étaient traités par collyre moxifloxacine (quinolone de 4e génération) pendant 2 jours avant d’être randomisés dans le groupe corticoïdes (prednisolone phosphate 1 %, 4 fois/jour) ou placebo. Staphylococcus, streptococcus et Pseudomonas étaient les principales bactéries isolées. Il n’a été retrouvé aucune différence significative, entre les deux groupes, en termes : de meilleure acuité visuelle corrigée à 3 mois d’évolution ; de taille de l’infiltrat ou de la cicatrice cornéenne ; de délai de réépithélialisation ; de survenue de perforation cornéenne. Cependant, les patients qui avaient une acuité visuelle initiale inférieure ou égale à compter les doigts au moment de la prise en charge, retrouvaient une meilleure acuité à 3 mois dans le groupe prednisolone que dans le groupe placebo [48–51]. Une étude connexe a montré que le profil de virulence (invasivité, cytotoxicité) des Pseudomonas isolés dans SCUT serait un facteur modulateur de l’effet du traitement corticoïde : l’effet bénéfique des corticoïdes serait plus important en termes d’acuité visuelle sur les Pseudomonas du sous-groupe invasif par rapport aux Pseudomonas du sous-groupe cytotoxique [52].
Ainsi, les corticoïdes permettent de limiter la réponse inflammatoire de l’hôte qui engendre la destruction du tissu cornéen [53]. Dans notre pratique, le traitement est débuté après 48 heures en cas de bactérie à Gram positif identifiée, après 72 à 96 heures en cas de bactérie à Gram négatif. Les corticoïdes ne sont pas prescrits en cas de risque perforatif important ou en cas de doute sur la présence d’une infection mycotique associée.
En l’absence d’amélioration (persistance, progression centrifuge et en profondeur de l’infiltration stromale, aggravation de l’ulcère épithélial, progression de l’amincissement cornéen, atteinte ou majoration de l’inflammation de chambre antérieure, persistance/augmentation des signes fonctionnels), trois possibilités sont à envisager :
-
l’agent infectieux initial, ou un autre agent responsable de co-infection (autre bactérie, virus, champignon, amibe), persiste malgré le traitement antibiotique et il n’y a pas de problème de compliance au traitement. Une fenêtre thérapeutique de 12 à 24 heures est alors programmée et les prélèvements sont à nouveau effectués avec si besoin ensemencement de milieux spéciaux pour la recherche d’agents pathogènes non bactériens ou de bactéries atypiques (milieu de Sabouraud, bouillon Schaedler avec extrait globulaire, gélose chocolat PolyViteX® en anaérobie, milieu de transport viral). Une biopsie de cornée peut être envisagée en cas d’atteinte chronique du stroma profond. Le traitement anti-infectieux est ensuite adapté en fonction des résultats des nouveaux prélèvements ;
-
les collyres renforcés provoquent une toxicité locale qui entraîne un retard de cicatrisation cornéenne. Plusieurs solutions sont envisageables : réduire la posologie des collyres renforcés, les remplacer par des collyres d’officine (après vérification de l’antibiogramme) ou utiliser des collyres mouillants ;
-
l’inflammation évolue pour son propre compte et est responsable de la persistance des signes. L’introduction des collyres corticoïdes ou l’augmentation de leur fréquence d’instillation est alors souhaitable.
Il est parfois nécessaire de réaliser une greffe de cornée « à chaud » lorsque l’intégrité du globe est menacée : infection sévère et évolutive malgré le traitement médical, perforation cornéenne avérée ou imminente. Les techniques de kératoplastie lamellaire profonde (KLP) ou de kératoplastie transfixiante (KT) peuvent être employées à titre thérapeutique. Les taux de succès thérapeutique (absence de récurrence infectieuse) des deux techniques étaient respectivement de 84 et 88 % dans une étude récente [54]. En revanche, une meilleure acuité visuelle corrigée supérieure ou égale à 6,3/10e était observée chez 50 % des patients traités par greffe lamellaire contre 20 % de ceux ayant bénéficié d’une greffe transfixiante (p=0,01). Le gain d’acuité visuelle était en moyenne de 7,27 lignes pour les KLP contre 4,76 dans le groupe KT (p=0,01) et le taux de survie à 1 an du greffon était meilleur pour les KLP par rapport aux KT (90 % contre 78 %) [54]. Cependant le pronostic des kératoplasties est mauvais sur un œil infecté et inflammatoire et l’on tentera dans la mesure du possible de le différer et d’attendre au moins 9 à 12 mois après résolution de l’épisode infectieux [55].
En cas de perforation de petit diamètre, de la colle cyanoacrylate ou une greffe-bouchon sont à envisager.
Combinée avec le traitement médical, une greffe de membrane amniotique peut s’avérer utile à la phase aiguë des kératites bactériennes sévères, notamment en cas de surface oculaire préalablement pathologique, en favorisant le processus de cicatrisation cornéenne [56]. Un effet antalgique et anti-inflammatoire de la membrane amniotique a également été démontré [57, 58].
Quelques cas de fontes stromales septiques résistantes au traitement antinfectieux ont été traités par crosslinking cornéen, permettant de différer des kératoplasties à chaud [59, 60].
Les injections intrastromales d’antibiotiques sont également en cours d’évaluation [61].
Le pronostic général des kératites bactériennes s’améliore depuis quelques décennies grâce aux progrès thérapeutiques qui permettent un meilleur contrôle de l’infection et de l’inflammation. Les facteurs de mauvais pronostic sont liés à la gravité initiale de l’atteinte locale (taille et profondeur de l’infiltrat, présence d’une inflammation de chambre antérieure, présence de néovaisseaux cornéens) et à l’importance de la perte de vision. Le port de lentilles de contact, pourtant facteur de risque principal des séries de KB sévères nécessitant l’hospitalisation, n’est pas à considérer comme un facteur de mauvais pronostic [12, 21]. En revanche, l’âge avancé, la présence d’antécédents d’immunodépression systémique ou d’une pathologie chronique de la surface oculaire le sont [12, 15]. Le pronostic visuel est plus mauvais pour les infections à bactéries à Gram négatif que celles à Gram positif. Une publication récente a montré que la CMI des antibiotiques administrés (moxifloxacine de l’étude SCUT) vis-à-vis de la bactérie responsable de l’infection était corrélée à la taille de la cicatrice cornéenne observée à 3 mois ou à l’acuité visuelle finale (une ligne de moins pour une CMI multipliée par 32) [62]. En pratique, 92 à 98 % des kératites bactériennes prises en charge en milieu hospitalier (considérées comme les cas les plus graves) évoluent vers la guérison sous traitement médical [6, 8, 30, 53, 63] et 60 à 85 % des patients recouvrent une acuité visuelle supérieure à l’acuité visuelle initiale [6, 12], 35 % perdent entre une et trois lignes de meilleure acuité visuelle corrigée, et 5 % perdent plus de quatre lignes [6, 12]. Dans la série rétrospective du King Khaled Eye Specialist Hospital, 29 % des patients hospitalisés pour KB en 2005 récupéraient une meilleure acuité visuelle supérieure ou égale à 5/10e contre 10 % en 1995 [53]. Les cas défavorables sont aujourd’hui relativement rares, estimés à moins de 2 % [31]. Ils concernent surtout certaines infections à Staphylococcus aureus (notamment en cas de polyarthrite rhumatoïde ou de sécheresse sévère), à Pseudomonas aeruginosa chez les porteurs de lentilles traités d’emblée par corticoïdes, ou certaines infections à Neisseria dans le cadre d’infections sexuellement transmissibles. La perforation de la cornée peut alors survenir rapidement et un traitement chirurgical urgent est nécessaire.
La majorité des kératites bactériennes sont résolutives sous traitement médical à condition de détecter l’infection rapidement et de la traiter sans délai. L’incidence de ces infections, essentiellement par le port de lentilles de contact, doit inciter les ophtalmologistes à une grande vigilance. L’éducation et l’information du patient porteur de lentilles de contact tiennent une place essentielle dans la prévention.
[1] Seal D, Pleyer U. Ocular infection. 2nd ed. Informa healthcare ; 2007.
[2] Sharma N. Corneal ulcers. Diagnosis and management. New Delhi : Jaypee ; 2008.
[3] Chaumeil C, Malet F. Complications infectieuses. In : Rapport SFO. Les lentilles de contact. Issy-les-Moulineaux : Masson ; 2009, p. 873-932.
[4] Bourcier T, Chaumeil C. Kératites bactériennes. In : Bourcier T, Chaumeil C, Borderie V et al. Infections cornéennes. Diagnostic et traitement. Paris : Elsevier ; 2004, p. 39-63.
[5] Afshari NA, Ma JJ, Duncan SM, et al. Trends in resistance to ciprofloxacin, cefazolin, and gentamicin in the treatment of bacterial keratitis. J Ocul Pharmacol Ther 2008 ; 24 : 217-23.
[6] Bourcier T, Thomas F, Borderie V, et al. Bacterial keratitis : predisposing factors, clinical and microbiological review of 300 cases. Br J Ophthalmol 2003 ; 87 : 834-8.
[7] Ovodenko B, Seedor JA, Ritterband DC, et al. The prevalence and pathogenicity of Propionibacterium acnes keratitis. Cornea 2009 ; 28 : 36-9.
[8] Schaefer F, Bruttin O, Zografos L, Guex-Crosier Y. Bacterial keratitis : a prospective clinical and microbiological study. Br J Ophthalmol 2001 ; 85 : 842-7.
[9] Yeh DL, Stinnett SS, Afshari NA. Analysis of bacterial cultures in infectious keratitis, 1997 to 2004. Am J Ophthalmol 2006 ; 142 : 1066-8.
[10] Lichtinger A, Yeung SN, Kim P, et al. Shifting trends in bacterial keratitis in Toronto : an 11-year review. Ophthalmology 2012 ; 119 : 1785-90.
[11] Kaliamurthy J, Kalavathy CM, Parmar P, et al. Spectrum of bacterial keratitis at a tertiary eye care centre in India. Biomed Res Int 2013 ; 2013 : 181564.
[12] Ancele E, Lequeux L, Fournie P, et al. Severe bacterial keratitis. A clinical, epidemiologic, and microbiologic study. J Fr Ophtalmol 2009 ; 32 : 558-65.
[13] Green M, Apel A, Stapleton F. Risk factors and causative organisms in microbial keratitis. Cornea 2008 ; 27 : 22-7.
[14] Mesplie N, Kerautret J, Leoni S, et al. Severe bacterial keratitis and activity of fluoroquinolones. J Fr Ophtalmol 2009 ; 32 : 273-6.
[15] Van der Meulen IJ, Van Rooij J, Nieuwendaal CP, et al. Age-related risk factors, culture outcomes, and prognosis in patients admitted with infectious keratitis to two Dutch tertiary referral centers. Cornea 2008 ; 27 : 539-44.
[16] Shah A, Sachdev A, Coggon D, Hossain P. Geographic variations in microbial keratitis : an analysis of the peer-reviewed literature. Br J Ophthalmol 2011 ; 95 : 762-7.
[17] Choy MH, Stapleton F, Willcox MD, Zhu H. Comparison of virulence factors in Pseudomonas aeruginosa strains isolated from contact lens- and non-contact lens-related keratitis. J Med Microbiol 2008 ; 57 : 1539-46.
[18] Arranz-Valsero I, Schulze U, Contreras-Ruiz L, et al. Involvement of corneal epithelial cells in the Th17 response in an in vitro bacterial inflammation model. Mol Vis 2013 : 19 : 85-99.
[19] Jhanji V, Constantinou M, Taylor HR, Vajpayee RB. Microbiological and clinical profile of patients with microbial keratitis residing in nursing homes. Br J Ophthalmol 2009 ; 93 : 1639-42.
[20] Sandali O, Gaujoux T, Goldschmidt P, et al. Infectious keratitis in severe limbal stem cell deficiency : characteristics and risk factors. Ocul Immunol Inflamm 2012 ; 20 : 182-9.
[21] Dethorey G, Daruich A, Hay A, et al. Severe bacterial keratitis referred to ophthalmology emergency departments : a retrospective study of 268 cases. J Fr Ophtalmol 2013 ; 36 : 129-37.
[22] Yildiz EH, Airiani S, Hammersmith KM, et al. Trends in contact lens-related corneal ulcers at a tertiary referral center. Cornea 2012 ; 31 : 1097-102.
[23] Stapleton F, Edwards K, Keay L, et al. Risk factors for moderate and severe microbial keratitis in daily wear contact lens users. Ophthalmology 2012 ; 119 : 1516-21.
[24] Stapleton F, Keay L, Edwards K, Holden B. The epidemiology of microbial keratitis with silicone hydrogel contact lenses. Eye Contact Lens 2013 ; 39 : 79-85.
[25] Morgan PB, Efron N, Hill EA, et al. Incidence of keratitis of varying severity among contact lens wearers. Br J Ophthalmol 2005 ; 89 : 430-6.
[26] Vital MC, Belloso M, Prager TC, Lanier JD. Classifying the severity of corneal ulcers by using the « 1, 2, 3 » rule. Cornea 2007 ; 26 : 16-20.
[27] Konstantopoulos A, Yadegarfar G, Fievez M, et al. In vivo quantification of bacterial keratitis with optical coherence tomography. Invest Ophthalmol Vis Sci 2011 ; 52 : 1093-7.
[28] Garg P. Fungal, Mycobacterial, and Nocardia infections and the eye : an update. Eye (Lond) 2012 ; 26 : 245-51.
[29] Dahlgren MA, Lingappan A, Wilhelmus KR. The clinical diagnosis of microbial keratitis. Am J Ophthalmol 2007 ; 143 : 940-4.
[30] Constantinou M, Daniell M, Snibson GR, et al. Clinical efficacy of moxifloxacin in the treatment of bacterial keratitis : a randomized clinical trial. Ophthalmology 2007 ; 114 : 1622-9.
[31] Ibrahim YW, Boase DL, Cree IA. Epidemiologic characteristics, predisposing factors and microbiological profile of infectious corneal ulcers : the Portsmouth corneal ulcer study. Br J Ophthalmol 2009 ; 93 : 1319-24.
[32] Pachigolla G, Blomquist P, Cavanagh HD. Microbial keratitis pathogens and antibiotic susceptibilities : a 5-year review of cases at an urban county hospital in north Texas. Eye Contact Lens 2007 ; 33 : 45-9.
[33] Labetoulle M, Frau E, Offret H, et al. Non-preserved 1 % lidocaine solution has less antibacterial properties than currently available anaesthetic eye-drops. Curr Eye Res 2002 ; 25 : 91-7.
[34] Das S, Sheorey H, Taylor HR, Vajpayee RB. Association between cultures of contact lens and corneal scraping in contact lens related microbial keratitis. Arch Ophthalmol 2007 ; 125 : 1182-5.
[35] Pinna A, Usai D, Sechi LA, et al. Detection of virulence factors in Pseudomonas aeruginosa strains isolated from contact lens-associated corneal ulcers. Cornea 2008 ; 27 : 320-6.
[36] Duggirala A, Joseph J, Sharma S, et al. Activity of newer fluoroquinolones against gram-positive and gram-negative bacteria isolated from ocular infections : an in vitro comparison. Indian J Ophthalmol 2007 ; 55 : 15-9.
[37] Chiquet C, Romanet JP. Prescribing fortified eye drops. J Fr Ophtalmol 2007 ; 30 : 423-30.
[38] Lin CP, Boehnke M. Effect of fortified antibiotic solutions on corneal epithelial wound healing. Cornea 2000 ; 19 : 204-6.
[39] Chedru-Legros V, Fines-Guyon M, Cherel A, et al. Fortified antibiotic (vancomycin, amikacin and ceftazidime) eye drop stability assessment at -20 degrees C. J Fr Ophtalmol 2007 ; 30 : 807-13.
[40] Hanet MS, Jamart J, Chaves AP. Fluoroquinolones or fortified antibiotics for treating bacterial keratitis : systematic review and meta-analysis of comparative studies. Can J Ophthalmol 2012 ; 47 : 493-9.
[41] O’Brien TP, Maguire MG, Fink NE, et al. Efficacy of ofloxacin vs cefazolin and tobramycin in the therapy for bacterial keratitis. Report from the Bacterial Keratitis Study Research Group. Arch Ophthalmol 1995 ; 113 : 1257-65.
[42] Wilhelmus KR, Hyndiuk RA, Caldwell DR, et al. 0.3 % ciprofloxacin ophthalmic ointment in the treatment of bacterial keratitis. The Ciprofloxacin Ointment/Bacterial Keratitis Study Group. Arch Ophthalmol 1993 ; 111 : 1210-8.
[43] Baker RS, Flowers CW, Jr., Casey R, et al. Efficacy of ofloxacin vs cefazolin and tobramycin in the therapy for bacterial keratitis. Arch Ophthalmol 1996 ; 114 : 632-3.
[44] Sharma N, Goel M, Bansal S, et al. Evaluation of moxifloxacin 0.5 % in treatment of nonperforated bacterial corneal ulcers: a randomized controlled trial. Ophthalmology 2013 ; 120 : 1173-8.
[45] Ray KJ, Prajna L, Srinivasan M, et al. Fluoroquinolone treatment and susceptibility of isolates from bacterial keratitis. JAMA Ophthalmol 2013 ; 131 : 310-3.
[46] Oldenburg CE, Lalitha P, Srinivasan M, et al. Emerging moxifloxacin resistance in Pseudomonas aeruginosa keratitis isolates in South India. Ophthalmic Epidemiol 2013 ; 20 : 155-8.
[47] Srinivasan M, Lalitha P, Mahalakshmi R, et al. Corticosteroids for bacterial corneal ulcers. Br J Ophthalmol 2009 ; 93 : 198-202.
[48] Sy A, Srinivasan M, Mascarenhas J, et al. Pseudomonas aeruginosa keratitis : outcomes and response to corticosteroid treatment. Invest Ophthalmol Vis Sci 2012 ; 53 : 267-72.
[49] See CW, Srinivasan M, Saravanan S, et al. Prior elicitation and Bayesian analysis of the Steroids for Corneal Ulcers Trial. Ophthalmic Epidemiol 2012 ; 19 : 407-13.
[50] Srinivasan M, Mascarenhas J, Rajaraman R, et al. Corticosteroids for bacterial keratitis : the Steroids for Corneal Ulcers Trial (SCUT). Arch Ophthalmol 2012 ; 130 : 143-50.
[51] Srinivasan M, Mascarenhas J, Rajaraman R, et al. The steroids for corneal ulcers trial: study design and baseline characteristics. Arch Ophthalmol 2012 ; 130 : 151-7.
[52] Borkar DS, Fleiszig SM, Leong C, et al. Association between cytotoxic and invasive pseudomonas aeruginosa and clinical outcomes in bacterial keratitis. JAMA Ophthalmol 2013 ; 131(2) : 147-53.
[53] Al-Shehri A, Jastaneiah S, Wagoner MD. Changing trends in the clinical course and outcome of bacterial keratitis at King Khaled Eye Specialist Hospital. Int Ophthalmol 2009 ; 29 : 143-52.
[54] Anshu A, Parthasarathy A, Mehta JS. Outcomes of therapeutic deep lamellar keratoplasty and penetrating keratoplasty for advanced infectious keratitis : a comparative study. Ophthalmology 2009 ; 116 : 615-23.
[55] McClintic SM, Srinivasan M, Mascarenhas J, et al. Improvement in corneal scarring following bacterial keratitis. Eye (Lond) 2013 ; 27 : 443-6.
[56] Barequet IS, Habot-Wilner Z, Keller N, et al. Effect of amniotic membrane transplantation on the healing of bacterial keratitis. Invest Ophthalmol Vis Sci 2008 ; 49 : 163-7.
[57] Kheirkhah A, Tabatabaei A, Zavareh MK, et al. A controlled study of amniotic membrane transplantation for acute Pseudomonas keratitis. Can J Ophthalmol 2012 ; 47 : 305-11.
[58] Hoffmann S, Szentmary N, Seitz B. Amniotic membrane transplantation for the treatment of infectious ulcerative keratitis before elective penetrating keratoplasty. Cornea 2013.
[59] Iseli HP, Thiel MA, Hafezi F, et al. Ultraviolet A/riboflavin corneal cross-linking for infectious keratitis associated with corneal melts. Cornea 2008 ; 27 : 590-4.
[60] Price MO, Tenkman LR, Schrier A, et al. Photoactivated riboflavin treatment of infectious keratitis using collagen cross-linking technology. J Refract Surg 2012 ; 28 : 706-13.
[61] Liang SY, Lee GA. Intrastromal injection of antibiotic agent in the management of recalcitrant bacterial keratitis. J Cataract Refract Surg 2011 ; 37(5) : 960-2.
[62] Lalitha P, Srinivasan M, Manikandan P, et al. Relationship of in vitro susceptibility to moxifloxacin and in vivo clinical outcome in bacterial keratitis. Clin Infect Dis 2012 ; 54 : 1381-7.
[63] Gudmundsson OG, Ormerod LD, Kenyon KR, et al. Factors influencing predilection and outcome in bacterial keratitis. Cornea 1989 ; 8(2) : 115-21.
A. Muselier-Mathieu, A. Bron, C. Creuzot-Garcher
Les atteintes bactériennes sont une cause rare de conjonctivites. Il ne faut pas méconnaître les formes graves de conjonctivites hyperaiguës du nourrisson secondaire à Neisseria gonorrhoeae car elles exposent au risque de cécité. Les germes en cause dans les conjonctivites bactériennes varient selon la forme clinique et l’âge du patient. Une conjonctivite chronique traînante ou résistante à un traitement bien conduit doit faire évoquer le diagnostic de chlamydiose oculaire. En l’absence de critère de gravité (sécrétions purulentes importantes, chémosis, œdème palpébral, larmoiement important, baisse d’acuité visuelle même modérée et photophobie) ou de facteur de risque, le recours à un antibiotique ne doit pas être systématique. Le traitement d’une conjonctivite bactérienne repose sur les lavages oculaires associés à un traitement antiseptique.
Le terme conjonctivite signifie inflammation de la conjonctive sans atteinte cornéenne et ne présume pas de son origine infectieuse ou non. Une conjonctivite aiguë est une conjonctivite qui dure moins de 4 semaines. On la distingue des conjonctivites « hyperaiguës » par son degré de gravité. L’œil rouge représente 1 à 4 % des causes de recours aux consultations chez le médecin généraliste [1]. L’incidence semble augmenter durant le jeune âge. Il paraît donc important de pouvoir préciser l’étiologie de la conjonctivite afin de mettre en route un traitement adapté antibiotique ou non.
L’origine bactérienne n’est pas toujours aisément distinguée au sein des autres causes infectieuses ou parmi les autres étiologies bénignes d’œil rouge (allergie, œil sec, etc.). Les conjonctivites bactériennes représentent entre 50 et 75 % des causes de conjonctivites du jeune enfant [2], le diagnostic de conjonctivite d’origine virale étant plus volontiers porté si elle s’accompagne de signes associés (pharyngite, otite). Il est cependant difficile de déterminer l’incidence réelle des conjonctivites bactériennes, car celles-ci ne sont pas prises en charge de façon exclusive par les ophtalmologistes.
Les facteurs aboutissant à une conjonctivite résultent de la conjonction de plusieurs éléments : dépassement des défenses de l’hôte, effraction des barrières épithéliales, multiplication des germes et réponse inflammatoire de l’hôte.
La conjonctive, en contact avec le monde extérieur, constitue une porte d’entrée à de nombreux germes et virus. En permanence balayées par les clignements des paupières, les sécrétions conjonctivales sont évacuées progressivement vers l’angle interne. La flore conjonctivale résulte de deux éléments :
-
la colonisation bactérienne, issue de la paupière marginale qui correspond à la présence stable de micro-organismes, en équilibre avec les défenses de l’organisme ;
-
la contamination récurrente par des sources extérieures à la conjonctive.
Selon les circonstances, les germes peuvent être pathogènes, de façon opportuniste en cas d’immunodépression ou seulement exceptionnellement en cas de lésions tissulaires associées. Les germes retrouvés sur une conjonctive saine sont non pathogènes et empêcheraient la contamination de la conjonctive par d’autres germes pathogènes [3]. Les germes les plus fréquemment retrouvés sont Staphylococcus epidermidis et Corynebacterium species, puis Staphylococcus aureus pour les cocci à Gram positif et Propionibactérium acnes pour les bacilles à Gram positif. Ces germes sont présents dans les deux tiers des prélèvements effectués sur une population saine, sujets sains notamment chez l’adulte. Les anomalies de statique palpébrale, les troubles chroniques de la surface oculaire, les obstructions des voies lacrymales ainsi que les traitements au long cours peuvent être à l’origine d’une augmentation de la contamination de la conjonctive. Le port de lentilles de contact favorise l’apparition des bactéries à Gram négatif, alors que certaines situations augmentent la présence des germes de type staphylocoque à coagulase négative : le diabète, la dermatite atopique, l’immunodépression ainsi que l’utilisation prolongée de corticoïdes.
Les virus sont également présents au niveau de la conjonctive et les champignons fluctuent selon les conditions climatiques. L’Aspergillus et les Candida sont les plus fréquemment observés.
Les facteurs modifiant cette flore conjonctivale seraient associés à :
-
l’âge : la flore conjonctivale est mise en évidence dès la naissance avec un ratio de bactéries à Gram négatif qui augmente tout au long de la vie ;
-
les saisons : les infections bactériennes surviennent plus volontiers en hiver et au printemps, alors que les atteintes virales prédominent en été ;
-
la géographie : elle influence la fréquence des germes mais le facteur climatique (chaud et humide dans la zone subtropicale) augmente surtout l’incidence des mycoses.
L’étiologie des conjonctivites varie selon l’âge : la période néonatale est marquée par la prédominance de Chlamydia trachomatis et Neisseria gonorrhoeae. Chez l’enfant de moins de 1 an, on retrouve fréquemment des entérocoques coliformes. Haemophilus influenzae (45–60 % des cas), Staphylococcus aureus (8–20 %), Streptococcus pyogenes et pneumoniae (20–30 %) et Moraxella (5–10 %) deviennent les germes majoritaires chez l’enfant et l’adulte.
-
Dans les conjonctivites aiguës : les germes d’origine ORL et respiratoires du genre Streptococcus pneumoniae et Haemophilus influenzae (souvent associés à une otite) sont majoritaires chez les enfants.
-
Dans les conjonctivites chroniques : le staphylocoque doré, les Moraxella et les bactéries à Gram négatif s’accompagnent souvent de blépharite.
La contamination se fait essentiellement par la voie « main–œil » notamment dans les garderies ou les crèches. Toutefois, la contamination d’origine nasopharyngée n’est pas à négliger pour les germes Haemophilus et Staphylococcus aureus. Les enfants présentent en effet une rhinite avec une relative diminution du drainage des larmes expliquant la prépondérance des germes d’origine nasopharyngée. La contamination oculogénitale est liée soit au passage dans la filière génitale chez le nourrisson, soit au contact direct par les doigts. D’autres modes de contamination sont plus anecdotiques : par l’extrémité des flacons de collyres, par les lentilles de contact, par la projection de sang. Il faut enfin rappeler que le temps de contagiosité des conjonctivites bactériennes est de 2 à 7 jours [4].
La conjonctivite est un terme générique qui regroupe un certain nombre d’étiologies [5]. Toutefois, leur symptomatologie est assez univoque. L’aspect clinique orientera alors les examens selon l’étiologie suspectée pour permettre d’adapter le traitement. La conjonctivite bactérienne commence typiquement de façon unilatérale avant de se bilatéraliser au bout de 1 à 2 jours (souvent secondairement à une contamination directe liée au grattage). Une pathologie allergique est plus volontiers bilatérale même si elle n’est pas nécessairement parfaitement symétrique. Une étiologie herpétique sera le plus souvent unilatérale chez l’immunocompétent.
La prise en charge d’une réaction inflammatoire de la conjonctive pourra varier sensiblement selon le mode de présentation : l’étiologie infectieuse sera retenue en cas de présentation aiguë ou a fortiori suraiguë, alors que les mécanismes allergiques ou liés à une sécheresse oculaire seront suspectés lors d’une présentation chronique. Cette distinction n’est bien sûr que théorique : les chlamydioses devront être évoquées devant toute conjonctivite inflammatoire chronique d’autant plus qu’elles ont été précédées d’un épisode aigu. Les circonstances entourant l’apparition de la pathologie inflammatoire chronique doivent être précisées : la recherche d’un déclenchement saisonnier ou dans un lieu donné, systématiquement associé aux récidives, orientera vers une pathologie allergique.
Le plus souvent d’apparition brutale, les conjonctivites bactériennes se caractérisent par des sécrétions épaisses et purulentes. Une photophobie modérée avec larmoiement réactionnel peut être présente mais est plutôt rare. On ne retrouve pas classiquement de baisse d’acuité visuelle. Ainsi, il faut retenir l’adage suivant : « Un œil rouge avec une baisse d’acuité visuelle n’est pas une conjonctivite jusqu’à preuve du contraire. »
Certaines irritations peuvent pousser les patients à se frotter les yeux entraînant ainsi des lésions cornéennes superficielles, avec sensation de corps étranger superficiel.
Aucun signe n’est pathognomonique d’une étiologie bactérienne, mais la présence d’un œil collé le matin est très en faveur, alors que la sensation de démangeaisons ou les antécédents de conjonctivite diminuent cette probabilité. L’examen à la lampe à fente retrouvera une hyperhémie conjonctivale, un œdème conjonctival (ou chémosis) et palpébral. Des sécrétions tout d’abord muqueuses puis mucopurulentes sont fréquentes dans la majorité des cas. L’hypersécrétion sale purulente de couleur jaune est plus volontiers trouvée dans les formes secondaires à Neisseria gonorrhoeae ou meningitidis. Un aspect de fausses membranes ou de membranes peut être associé dans des causes bien identifiées (Corynebacterium diphtheriae et Streptococcus pyogenes). L’œdème palpébral pourra être accompagné de croûtes jaunâtres au niveau du bord des paupières. On peut retrouver à la fois des papilles et des follicules mais ces derniers seront plus volontiers retrouvés dans des formes de conjonctivite chronique (Moraxella). Des signes associés seront systématiquement recherchés, telle une adénopathie prétragienne, rarement présente évoquant plutôt un syndrome oculoglandulaire (voir plus haut). On notera les signes d’atteinte de l’état général à type de fièvre, de pharyngite, de malaise généralisé ou de maux de tête. Enfin, une forme compliquée d’une atteinte cornéenne sera recherchée tout particulièrement dans les conjonctivites hyperaiguës liées à Neisseria gonorrhoeae, ou d’hémorragies sous-conjonctivales liées à certains entérocoques.
Les critères de gravité à prendre en compte devant une conjonctivite bactérienne sont cliniquement des sécrétions purulentes importantes, un chémosis, un œdème palpébral, un larmoiement important, une baisse d’acuité visuelle même modérée et une photophobie [6]. Les autres facteurs de gravité sont résumés dans l’encadré 6-1.
Selon le terrain
• Conjonctivite purulente chez un nouveau-né : surtout si sécrétions abondantes et épaisses, hyperhémie conjonctivale sévère, chémosis important, apparition dans la première semaine de vie, absence de larmoiement en dehors des sécrétions, et signes de gravité – atteinte cornéenne (baisse de vision, photophobie), hypopion
• Conjonctivite purulente chez l’immunodéprimé
• Porteurs de lentilles ou de prothèses oculaires
• Conjonctivite purulente chez un patient ayant été opéré de glaucome ou de cataracte
• Patient traité de façon chronique par corticoïdes locaux
• Notion d’infection à Neisseiria gonorrhoeae, Neisseiria meningitidis ou Haemophilus influenzae
Selon la présentation clinique
• Conjonctivite aiguë avec membranes ou pseudo-membranes
• Conjonctivite associée à une atteinte cornéenne ou à un abcès cornéen
• Conjonctivite chronique résistante au traitement afin de rechercher d’éventuels Chlamydiae
• Conjonctivite aiguë récurrente ou résistante à un traitement empirique de 8 jours
Les conjonctivites bactériennes ne sont pas les causes les plus fréquentes des conjonctivites mais justifient dans certains cas d’un traitement urgent. Il importe donc de bien savoir les reconnaître. Certaines particularités cliniques orienteront plus volontiers vers une étiologie particulière [5, 7].
On appelle conjonctivite du nouveau-né, une conjonctivite survenant dans les 28 jours après la naissance. Les nouveau-nés ont un risque accru de contracter une conjonctivite lors du passage dans la filière génitale d’autant plus qu’une infection du tractus génital de la mère, une rupture prématurée des membranes ou un traumatisme obstétrical sont présents. Conformément aux recommandations de l’Agence nationale de sécurité du médicament et des produits de santé ou ANSM (anciennement l’Afssaps) de 2010 [8] : « D’une manière générale, il n’existe pas de données montrant l’efficacité d’une antibioprophylaxie conjonctivale néonatale systématique. Cependant, par mesure de précaution, une antibioprophylaxie conjonctivale néonatale est recommandée en cas d’antécédents et/ou de facteurs de risque d’infections sexuellement transmissibles (IST) chez les parents. Dans ces situations, il est recommandé d’instiller une goutte de collyre à base de rifamycine dans chaque œil du nouveau-né à la naissance. Il est à noter que les grossesses non ou mal suivies sont considérées comme un facteur de risque d’IST. » Il existe enfin des formes néonatales de conjonctivite bactérienne (forme nosocomiale) en dehors des formes « liées à l’accouchement ».
Il s’agit d’une forme de conjonctivite heureusement rare (0,4 pour 1000 naissances) mais qui ne doit pas être oubliée du fait de sa gravité puisqu’elle expose au risque de cécité par opacification ou perforation cornéenne. Classiquement, elle débute avant le 5e jour post-natal avec un tableau clinique bruyant très inflammatoire. Ce dernier associe un œdème palpébral, des sécrétions purulentes jaunâtres abondantes pouvant entraîner des membranes, elles-mêmes parfois à l’origine d’ulcérations ou de perforations cornéennes dans les cas les plus graves.
Plus fréquente (1 à 2 pour 1000 naissances) et moins spectaculaire, la conjonctivite à inclusions serait présente chez 30 à 40 % des enfants nés de mères infectées et serait contractée lors du passage de la filière génitale, qu’elle soit symptomatique ou non [9]. Elle débute au cours du premier mois de vie classiquement entre le 5e et le 14e jour. Au départ unilatérale, elle se bilatéralise dans la moitié des cas [10]. Le tableau clinique associe la présence d’une conjonctivite papillaire, une hyperhémie conjonctivale parfois marquée et des sécrétions muqueuses ou purulentes. Des pseudomembranes peuvent être présentes ainsi qu’une atteinte cornéenne (ulcération, pannus cornéen séquellaire) mais qui est rare dans les premiers temps. Des manifestations pulmonaires sont associées dans la moitié des cas. À la différence de l’adulte, on ne retrouve pas de follicules, le système immunitaire du nouveau-né étant encore immature. Il est important d’éliminer une infection gonococcique associée et un prélèvement bactériologique sera réalisé au moindre doute.
Une atteinte ophtalmologique et notamment conjonctivale peut être retrouvée en cas d’infection bactérienne à la naissance, quel que soit le germe en cause. Elle peut entraîner une infection des voies lacrymales ou une dacryocystite. On retrouve des streptocoques, des Haemophilus mais les infections à staphylocoque sont les plus fréquentes et de bon pronostic. En cas de récidive multiple, une imperforation des voies lacrymales devra être systématiquement recherchée.
Fréquentes, elles sont volontiers associées chez le nourrisson à une imperforation des voies lacrymales, surtout lorsqu’elles sont récidivantes. Le tableau clinique classique déjà décrit précédemment associe des sécrétions mucopurulentes, une hyperhémie conjonctivale et un œdème palpébral (fig. 6-8). Les bactéries les plus fréquemment en cause dans les conjonctivites bactériennes de l’enfant sont Haemophilus influenzae (45 à 60 %) et les streptocoques (20 à 30 %). Ces germes sont classiquement retrouvés dans le nez et les voies aérodigestives supérieures. La mauvaise qualité du drainage des larmes secondaire au rétrécissement des voies lacrymales favorise l’ascension des germes vers la conjonctive par voie nasale expliquant le spectre bactérien spécifique chez l’enfant. La conjonctivite à Haemophilus influenzae associe volontiers des signes généraux : malaise, fièvre, otite moyenne aiguë (25 à 30 % des cas), atteinte des voies aériennes digestives supérieures. Quant à Streptococcus pneumoniae, des hémorragies sous-conjonctivales accompagnant la conjonctivite sont parfois retrouvées. Des conjonctivites à Staphylococcus aureus (8 à 20 %) et Moraxella catarrhalis (5 à 10 %) sont aussi des formes étiologiques courantes chez l’enfant. Les conjonctivites à Neisseria meningitidis sont extrêmement rares et présentent les mêmes caractéristiques cliniques (conjonctivite hyperaiguë) que celles à Neisseria gonorrhoeae dont elles sont difficilement discernables.
Le syndrome oculoglandulaire de Parinaud, souvent secondaire à une infection par Bartonella henselae dans la maladie des griffes du chat, associe une conjonctivite purulente, des follicules, des granulomes conjonctivaux et une adénopathie prétragienne (pouvant se fistuliser).

Fig. 6-8 Conjonctivite bactérienne de l’enfant.
Les germes en cause dans les conjonctivites bactériennes de l’adulte sont variés. L’association à une autre localisation orientera le diagnostic étiologique : une atteinte des voies lacrymales ou des paupières (chalazion), des ulcères catarrhaux, une kératite ponctuée superficielle évoqueront avant tout la responsabilité du staphylocoque et de la réaction contre son exotoxine. En cas de blépharite angulaire et donc d’atteinte cutanée du canthus externe, Moraxella sera évoqué. Ces deux derniers germes (staphylocoque et Moraxella) peuvent être à l’origine d’une blépharoconjonctivite chronique folliculaire. Il est parfois difficile d’affirmer une étiologie bactérienne mais l’existence de sécrétions sales avec des yeux collés sera en faveur de cette dernière, tandis que des démangeaisons et une histoire ancienne de conjonctivite écarteront plutôt le diagnostic. L’existence d’une urétrite ou d’arthralgies évoquera une origine gonococcique ou chlamydienne. Dans le syndrome oculoglandulaire précédemment cité chez l’enfant, l’affection est causée par différents micro-organismes et consiste en l’apparition d’une conjonctivite généralement unilatérale, avec la présence d’un granulome de couleur variable, unique ou multiple et siégeant en conjonctive inflammatoire. Une ulcération conjonctivale et une réaction folliculaire peuvent accompagner le tableau. On retrouve souvent un petit malaise et une fièvre. Le patient présente souvent une adénopathie préauriculaire et plus rarement une adénopathie prémandibulaire souple. La première cause en est un bacille intracellulaire de type Gram négatif appelé Bartonella henselae. On confond souvent le syndrome oculoglandulaire qui regroupe l’ensemble des affections conjonctivales et glandulaires (tularémie, chlamydioses, maladie de Nicolas-Favre, tuberculose, syphilis, sporotrichose, etc.) et le syndrome oculoglandulaire de Parinaud qui est strictement limité à la maladie des griffes du chat (fig. 6-9). L’affection est alors souvent unilatérale, atteint plus volontiers l’homme et l’adulte jeune ou l’enfant en contact avec des chats. Il peut exister un malaise, de la fièvre, une anorexie et des maux de tête. La conjonctivite prend l’aspect d’une conjonctivite granulomateuse avec des macrofollicules. Il y a peu de complications cornéennes.
Rares sont les arguments permettant de distinguer de façon formelle, devant une conjonctivite aiguë, une atteinte bactérienne d’une atteinte virale. Toutefois, certains éléments d’orientation peuvent être soulignés afin de conduire le diagnostic (tableau 6-4). Les principaux germes pathogènes en cause dans les conjonctivites bactériennes sont résumés dans l’encadré 6-2.
• Conjonctivite hyperaiguë purulente :
■ Neisseria gonorrhoeae
■ Neisseria meningitidis
• Conjonctivite aiguë (adulte) :
■ Staphylococcus aureus
■ Streptococcus pneumoniae
■ Haemophilus influenzae
■ Streptococcus pyogenes
■ bactérie à Gram négatif (rare)
• Conjonctivite aiguë (enfant) :
■ Haemophilus influenzae
■ Streptoccus pneumoniae
■ Staphylococcus aureus
■ Moraxella
• Conjonctivite chronique :
■ Staphylococcus aureus
■ Moraxella lacunata
■ Streptococcus pyogenes
■ Klebsiella pneumoniae
■ Serratia marcescens
■ Escherichia coli
■ Chlamydiae trachomatis

Fig. 6-9 Conjonctivite associée à la maladie des griffes du chat.
Tableau 6-4 Éléments permettant de différencier atteinte virale et atteinte bactérienne.
Les Chlamydiae sont des bactéries à Gram négatif intracellulaires qui ont une structure complexe et se multiplient à l’intérieur de la cellule hôte, formant des inclusions cytoplasmiques. La famille des Chlamydiaceae est constituée de deux genres :
-
celui des Chlamydiae, au sein duquel on distingue trois espèces : Chlamydiae trachomatis (voir chapitre 12-V), Chlamydia muridarum et Chlamydia suis ;
-
celui des Chlamydiophilae regroupant Chlamydia pneumoniae, Chlamydia caviae (ex-Chlamydia psittaci) et Chlamydia pecorum.
Chlamydia trachomatis est responsable du trachome, de conjonctivites à inclusions et de la maladie de Nicolas-Favre ou lymphogranulomatose vénérienne. Les Chlamydiae se présentent sous différentes formes :
-
les corps élémentaires, de 0,1 à 0,3 μm de diamètre, sans activité métabolique mais possédant un pouvoir infectieux, pénétrant dans la cellule ;
-
les corps réticulés, de 1 μm de diamètre, présentant une activité métabolique mais sans pouvoir infectieux ;
-
les inclusions, représentant des colonies de taille et de forme variables qui éclatent en lysant la cellule infectée et libérant alors les corps élémentaires.
Cette variabilité de formes s’explique par les différentes étapes du cycle de développement des Chlamydiae. La durée du cycle est d’environ 70 heures, de l’infection à la lyse cellulaire [11]. Il est strictement intracellulaire. L’adsorption par phagocytose du corps élémentaire au niveau de la cellule constitue la première étape de l’infection. Ce sont les mitochondries de la cellule hôte qui fournissent l’énergie nécessaire à cette phagocytose, les Chlamydiae ne pouvant fournir cette énergie. Dans la cellule, une vésicule entourant le corps élémentaire (le tout constituant un phagosome) le protège des lysosomes. Au sein du phagosome, le corps élémentaire va subir des transformations pour aboutir en quelques heures au corps réticulé. Le rassemblement des corps réticulés va former la morula. Les Chlamydiae sont visibles sur lames fixées à ce stade de leur développement [12]. Les corps réticulés sont les formes de reproduction des Chlamydiae dans la cellule. Leurs divisions forment une grande inclusion basophile. Dans certains corps réticulés, un nucléoïde central à base d’acide désoxyribonucléique (ADN) apparaît, entouré de ribosomes, constituant le corps intermédiaire, forme de transition entre corps élémentaire et corps réticulé. Les corps réticulés se divisent jusqu’à occuper tout le cytoplasme de la cellule infectée, aboutissant à l’éclatement cellulaire et donc à la dissémination de corps élémentaires qui vont aller infecter de nouvelles cellules.
Nous n’aborderons pas ici les manifestations liées aux autres types de chlamydioses pour lesquelles l’atteinte ophtalmologique reste relativement rare.
Celle-ci a été décrite plus haut dans les conjonctivites du nouveau-né.
Alors que le trachome est dû aux sérovars A, B et C de Chlamydia trachomatis, les conjonctivites à inclusions de l’adulte sont en rapport avec les sérovars D, E, F, G, H, I, J et K [13]. Les chlamydioses oculaires se manifestent plutôt dans nos pays occidentaux par une conjonctivite chronique folliculaire résistante au traitement [14, 15]. Elles sont généralement précédées d’un épisode aigu avec conjonctivite papillaire et folliculaire unilatérale ou bilatérale. De diagnostic difficile car souvent traînante dans sa forme chronique, les signes ne sont pas pathognomoniques et peuvent mimer une autre affection. En effet, le patient présente un œil rouge, larmoyant, avec quelques sécrétions le matin. Des follicules sont retrouvés au niveau des culs-de-sac puis au niveau de la conjonctive tarsale (fig. 6-10). Quelques semaines plus tard, une kératite ponctuée superficielle, un micropannus de 1 à 2 mm ainsi que de fins infiltrats sous-épithéliaux peuvent être retrouvés à l’examen clinique. Il existe également une infiltration et un épaississement de la conjonctive mais sans fausse membrane [15]. Appelées aussi conjonctivite à inclusions, elles sont dues à un contact avec des sécrétions génitales [16]. La période d’incubation est de 2 à 20 jours. Il convient donc de rechercher un partenaire infecté (cervicite chez la femme et urétrite chez l’homme) ainsi que l’association à d’autres infections sexuellement transmissibles. On dénombrerait selon l’Organisation mondiale de la santé (OMS) 100 millions de personnes infectées par Chlamydia trachomatis dont 3 millions de nouveaux cas par an en Europe. Cinquante pour cent des hommes et 75 % des femmes ayant une conjonctivite chlamydienne auraient des prélèvements génitaux positifs. Il est à noter que, depuis la chloration des piscines, la contamination de l’eau est devenue rarissime, ce qui a permis d’éradiquer la classique conjonctivite des piscines. Devant toute conjonctivite chronique, résistante au traitement, l’examen clinique avec recherche de follicules et un prélèvement seront réalisés afin de pouvoir orienter le diagnostic vers une conjonctivite à Chlamydia.

Fig. 6-10 Conjonctivite folliculaire.
Le classique syndrome de Fiessinger-Leroy-Reiter (FLR) associe une triade clinique : conjonctivite, urétrite et atteinte articulaire parfois suivies d’une uvéite. La conjonctivite, élément le moins constant de la triade, apparaît quelques jours après l’urétrite. Il s’agit d’une conjonctivite unilatérale, parfois bilatérale, modérée, fugace, qui peut être inapparente et qui se manifeste par la présence de papilles, le plus souvent sans follicules. Le jeune âge est le principal facteur de risque. L’antigène HLA-B27 serait présent dans 40 à 60 % des cas avec risque d’évolution vers une spondylarthrite ankylosante qui augmente avec le temps passant de 15 % à 10 ans à 30 % après 20 ans.
Liée à l’infection par les sérovars L1 à L3, l’atteinte associe des manifestations génitales et un syndrome oculoglandulaire avec une conjonctivite papillaire hyperplasique et de volumineuses adénopathies prétragiennes et sous-maxillaires inflammatoires après une période d’incubation de 3 à 30 jours. La kératite associée est caractérisée par la présence d’une large plage charnue de néovascularisation superficielle au limbe supérieur et parfois accompagnée d’une iridocyclite.
Le trachome fait suite à des infections répétées par Chlamydiae trachomatis de sérotypes A-C [17]. Il est à l’origine d’une cécité de cause curable dans les pays où la maladie sévit à l’état endémique. Le trachome est traité intégralement dans le chapitre 12-V.
Ses principales complications sont nombreuses et diverses :
-
complications palpébrales : l’entropion-trichiasis provient de la rétraction cicatricielle du tarse. Les cils sont orientés vers la cornée et sont à l’origine des complications cornéennes : ulcérations et infiltrations vasculaires allant jusqu’à la vascularisation totale de la cornée. Les variations interindividuelles de la fonction de l’orbiculaire expliqueraient que certains développent un trichiasis et d’autres pas [18] ;
-
complications cornéennes : kératites ponctuées superficielles (en général dans la partie supérieure de la cornée), infiltration stromale antérieure, néovascularisation superficielle (pannus) et ulcères trachomateux entraînant des cicatrices astigmatogènes et opaques (fig. 6-11) ;
-
complications conjonctivales : atrésie des fornix et atrophie conjonctivale avec absence de cellules à mucus et syndrome sec extrême [19]. Au stade terminal, la cornée et la conjonctive sont opaques, c’est le xérosis trachomateux ;
-
complications lacrymales : atrésie des points lacrymaux, dacryocystite et dacryoadénite trachomateuses ;
-
surinfections bactériennes : elles sont très fréquentes, dues souvent au bacille de Weeks, provoquant des ulcères cornéens avec infiltration vasculaire ;
-
anomalies des cils : hypertrophie des cils qui deviennent longs et épais ou, au contraire, atrophie ou rareté des cils (madarosis).

Fig. 6-11 Trachome au stade cicatriciel : opacité cornéenne supérieure avec néovascularisation cornéenne.
Le plus souvent, le diagnostic de la conjonctivite reste clinique et les examens complémentaires sont inutiles. Il ne se conçoit réellement que lors des conjonctivites bactériennes. Cependant, l’identification d’un germe demande en moyenne 48 à 72 heures en dehors des rares cas où celui-ci est identifié à l’examen direct. On sait qu’actuellement entre 85 et 95 % des conjonctivites répondent favorablement en 5 jours à un traitement antibiotique empirique à large spectre. Il ne paraît donc pas raisonnable d’effectuer une telle recherche de façon systématique. Il faut toutefois ne pas négliger ces prélèvements qui peuvent être précieux dans certains cas (terrain, facteurs de risque, facteurs de gravité) résumés dans l’encadré 6-1.
Certains faits doivent être soulignés :
-
chez les porteurs de lentilles de contact qui font une conjonctivite, ne pas jeter lentilles et étuis en cas de surinfection : l’analyse bactériologique est précieuse pour la mise en évidence de germes de champignons ou d’amibes ;
-
avoir présent à l’esprit que la flore conjonctivale varie d’un moment à l’autre et que la présence d’un germe au temps t ne suppose pas nécessairement sa responsabilité dans une infection.
Il se fait à l’aide d’un écouvillon stérile, appliqué dans le cul-de-sac inférieur de dehors en dedans. Il ramasse bien sûr avant tout la flore conjonctivale saprophyte mais également des germes caractérisés par un examen direct puis mis en culture. Par la suite, éventuellement, un antibiogramme est réalisé. Il est à noter que les techniques de biologie moléculaire sont rarement réalisées lors d’une conjonctivite bactérienne.
Le Chlamydia reste difficile à détecter par des techniques classiques en raison de son développement intracellulaire et nécessite des grattages conjonctivaux afin de prélever les cellules conjonctivales superficielles.
Le développement intracellulaire des Chlamydiae signifie que leur isolement nécessite l’utilisation de cellules vivantes. Après anesthésie topique, les prélèvements sont obtenus par raclage de la conjonctive tarsale inférieure et supérieure à l’aide d’un instrument en Dacron®, pour être mis rapidement en culture ou gardés à −70° C si la mise en culture ne peut être immédiate. La conjonctive doit avoir été rincée de la fluorescéine et des anesthésiques locaux utilisés lors de l’examen. Après culture cellulaire, la révélation des germes se fera par : immunofluorescence directe ou indirecte, ou technique immuno-enzymatique.
La culture cellulaire est la technique de référence pour affirmer la présence des Chlamydiae. La présence d’une seule inclusion est suffisante pour affirmer que le germe est présent. Cette technique n’est toutefois pas faite dans tous les laboratoires de bactériologie et demeure, en pratique, difficile à mettre en œuvre. Toutefois, elle seule permet de tester l’efficacité des antibiotiques sur le germe.
Ces techniques visent à mettre en évidence la présence d’anticorps dans le sérum ou dans les larmes dirigés contre les motifs antigéniques des Chlamydiae par immunofluorescence (2 à 3 fois plus sensibles que la culture mais nécessite un personnel entraîné à sa réalisation) ou par technique immuno-enzymatique (enzyme-linked immunosorbent assay ou ELISA). Cette dernière est plus simple et moins subjective que l’immunofluorescence et permet une certaine automatisation. Le résultat est obtenu rapidement avec une bonne spécificité mais une mauvaise sensibilité, notamment dans les prélèvements conjonctivaux de faible charge bactérienne.
Les techniques de polymerase chain reaction (PCR) ont également permis d’améliorer nettement la sensibilité du diagnostic : son principe repose sur l’amplification d’un fragment d’ADN. Les séquences sélectionnées pour l’amplification correspondent au gène de la principale protéine de la membrane externe (mitochondrial outer membrane permeabilization ou MOMP), au plasmide endogène ou au gène codant l’ARN ribosomal 16S [20]. Les résultats sont obtenus en 2 à 4 heures.
Chaque méthode a ses avantages et le choix s’opérera afin de ménager les meilleures sensibilité et spécificité de dosage possibles (tableau 6-5) [21] afin de prouver la conjonctivite à Chlamydia. La culture cellulaire du fait de son coût élevé, de sa difficulté de réalisation et de son nombre important de faux négatifs est une technique non applicable en pratique quotidienne. En revanche, l’immunofluorescence directe présente de nombreux avantages. La PCR reste aujourd’hui la technique qui est la plus souvent réalisée mais elle requiert un laboratoire entraîné. Il est à noter, qu’en cas d’infection localisée, les sérologies à la recherche de Chlamydia n’ont que peu d’intérêt.
Tableau 6-5 Diagnostic biologique des chlamydioses oculaires d’après Talley [21].
Pour ne citer que les plus courants, on peut retenir :
-
les autres causes de conjonctivites : virales ou allergiques dont la présentation clinique est différente avec des sécrétions moins importantes et moins épaisses ;
-
la conjonctivite associée au Molluscum contagiosum (poxvirus) ;
-
les faux larmoiements : liés à une obstruction des voies lacrymales ;
-
les faux yeux rouges : de nombreuses hypermétropies chez l’enfant se traduisent par un œil discrètement rouge avec parfois un discret larmoiement ;
-
les conjonctivites associées à la rosacée oculaire parfois compliquées d’atteinte cornéenne (kératite inférieure) ;
-
la conjonctivite ligneuse chez l’enfant caractérisée par des poussées inflammatoires alternant avec un œil blanc et des fausses membranes ;
-
les conjonctivites iatrogéniques dont le diagnostic est souvent difficile et trompeur ;
-
les rougeurs graves : toute baisse d’acuité visuelle fera éliminer le diagnostic de conjonctivite simple. Une complication cornéenne (kératite) sera toujours possible avec majoration de la photophobie et de la douleur. Un corps étranger sera toujours suspecté surtout dans les métiers à risque ou chez l’enfant. De même, toute baisse de vision avec œil rouge douloureux devra faire évoquer les diagnostics d’uvéite ou de crise aiguë de fermeture de l’angle.
Il faut souligner que la persistance des symptômes après un traitement bien conduit d’une conjonctivite bactérienne n’est pas exceptionnelle. L’inflammation locale induit une altération du film lacrymal qui va perdurer parfois pendant plusieurs mois. Le traitement sera alors celui d’un trouble simple de la surface oculaire afin de ne pas engendrer une iatrogénie.
On sait actuellement que 50 % seulement des conjonctivites aiguës mucopurulentes sont d’origine bactérienne. Toutefois, l’antibiothérapie semble diminuer la durée des symptômes et le risque de contamination permettant la réintégration du patient dans son monde professionnel ou scolaire. Le traitement repose sur les recommandations éditées par l’ANSM en 2004 [6].
On soulignera la primauté de l’examen clinique : un résultat discordant bactériologique ne doit pas faire modifier une thérapeutique objectivement efficace. Quand l’antibiothérapie est jugée nécessaire, il faut sûrement préférer une mono-antibiothérapie mais il pourra être licite d’instaurer une bithérapie pour élargir le spectre et augmenter l’activité du traitement dans certains cas spécifiques. Les conjonctivites justifient le plus souvent une simple bactériostasie (inhibition de la croissance des germes) sans bactéricidie (destruction des bactéries). Le traitement local se prolongera au moins 8 jours, en dépit de l’amélioration clinique souvent précessive, avec une posologie initiale de six à huit gouttes par jour pour s’alléger à 4 fois par jour à la fin du traitement. La persistance d’une symptomatologie inflammatoire conjonctivale, outre la non-observance thérapeutique ou l’inefficacité du traitement, doit faire suspecter la présence d’un corps étranger cornéen, une obstruction des voies lacrymales ou une affection locorégionale. Les porteurs de lentilles de contact doivent être avertis de suspendre le port des lentilles des deux yeux en cas de conjonctivite.
Les conjonctivites purulentes guérissent spontanément sans antibiotique, avec un simple traitement par lavage oculaire répété avec une rémission clinique en 5 jours dans 60 % des cas, mais un traitement antibiotique réduit significativement la durée des symptômes [22, 23]. L’ANSM recommande donc de ne pas traiter systématiquement, mais seulement en fonction du terrain (immunodépression, diabète, antécédents de chirurgie de glaucome, etc.). En effet, l’amélioration plus rapide par une antibiothérapie topique au cours d’une conjonctivite non grave apporte un confort au patient. En l’absence de critère de gravité (sécrétions purulentes importantes, chémosis, œdème palpébral, larmoiement important, baisse d’acuité visuelle même modérée et photophobie) ou de facteur de risque (voir encadré 6-1), le recours à un antibiotique ne doit pas être systématique. Ce gain de confort individuel doit être mis en balance avec le risque de sélectionner des souches résistantes à certains antibiotiques si ceux-ci sont utilisés à grande échelle. Le rapport bénéfice/risque s’inverserait alors au niveau collectif, avec un risque accru d’infections éventuellement sévères à germes résistants en raison de traitements antibiotiques abusifs des conjonctivites, pathologie bénigne dans la grande majorité des cas. Le chloramphénicol en collyre n’est pas utilisé en France en raison du risque potentiel d’aplasie médullaire. Il faut limiter les quinolones aux seules infections sévères. Pendant la grossesse, le mieux est d’utiliser l’azythromycine ou la rifamycine. Les collyres en suspension (comme l’acide fusidique) ou qui peuvent être instillés seulement 2 fois par jour (comme l’azythromycine) sont intéressants notamment chez l’enfant [24, 25].
Le traitement des conjonctivites bactériennes doit comprendre avant tout un lavage oculaire au sérum physiologique associé à un antiseptique, le traitement antibiotique étant réservé aux formes graves. Le spectre des antibiotiques est rappelé dans le tableau 6-6. En cas de persistance des symptômes après un traitement efficace, un traitement lubrifiant simple sera proposé pour améliorer le film lacrymal. De plus, la présence d’une conjonctivite chez les membres du personnel de crèche et de collectivité doit entraîner leur éviction afin d’éviter la transmission des germes.
Tableau 6-6 Spectre d’activité des antibiotiques topiques modifié d’après Robert [27].
méti-R : résistants à la méticilline ; méti-S : sensibles à la méticilline ; R : résistant.
Le traitement doit être local et général afin d’éviter ou de contrôler le développement d’une infection systémique et notamment pulmonaire. Il fait appel par voie locale aux macrolides ou quinolones associés, par voie générale, aux céphalosporines de 3e génération (ceftriaxone) ou aux macrolides (érythromycine, azythromycine).
L’évolution spontanée sans traitement se fait vers la guérison sans séquelles en plusieurs mois voire une à deux années. En cas d’atteinte strictement oculaire, un traitement local par azythromycine est à privilégier. Les tétracyclines ou fluoroquinolones sont aussi efficaces. Si une atteinte extra-oculaire est présente, un traitement général (permettant de traiter l’atteinte génitale) par macrolides (azythromycine) ou cyclines doit être associé. Un dépistage des partenaires sera systématiquement préconisé ainsi que des rapports sexuels protégés jusqu’à la fin du traitement.
Un traitement antibiotique ne sera envisagé qu’en cas de signes de gravité (sécrétions purulentes importantes, chémosis, baisse de vision). Un traitement local par rifamycine ou azythromycine [26] en collyre ou en forme pommade, quand elle est disponible pour faciliter l’observance, sera proposé. En cas d’atteinte systémique associée (Haemophilus influenzae ou Streptococcus pneumoniae), un traitement par voie générale associant amoxicilline et acide clavulanique sera envisagé pendant 8 à 10 jours en l’absence de contre-indication. Lors d’une conjonctivite à Neisseria meningitidis, la recherche de signes systémiques sera systématique. Un traitement local et général sera instauré et un traitement prophylactique pourra être envisagé chez les personnes ayant été en contact. En cas de conjonctivite associée à une imperforation des voies lacrymales, un massage simple du sac lacrymal pluriquotidien pourra être proposé au moins dans un premier temps.
La prise en charge de cette conjonctivite du nouveau-né est une urgence thérapeutique. En fait, très rapidement, la cornée peut devenir grisâtre laissant des séquelles visuelles très importantes. Un traitement sera instauré en urgence de façon locale (macrolides ou rifamycine) et générale (ceftriaxone, céfotaxime ou ciprofloxacine).
L’instillation des gouttes sera horaire les premiers jours puis réduite à 8 fois par jour pendant 10 à 12 jours. Les corticoïdes locaux sont contre-indiqués augmentant le risque de perforations cornéennes.
L’objectif du traitement du trachome est double : guérir de l’infection et éviter la transmission de l’infection. Il repose sur des antibiotiques ayant une bonne pénétration intracellulaire. De nos jours, l’azythromycine en collyre est devenu le traitement de référence y compris chez l’enfant par sa simplicité d’administration. La non-infériorité du traitement local par rapport au traitement général en dose unique a été démontrée dans une étude de Cochereau et al. [26]. Une antibiothérapie par voie générale peut être proposée (tétracyclines, macrolides). Le traitement préventif reste bien sûr primordial et est basé sur la stratégie « CHANCE » qui comprend quatre axes thérapeutiques principaux : chirurgie du trichiasis (CH), antibiothérapie pour les trachomes inflammatoires (A), nettoyage du visage, promotion de l’hygiène (N), changement de l’environnement tel que la gestion des déchets, approvisionnement en eau, etc. (CE). Le traitement chirurgical permet de prendre en charge les séquelles.
La prévention de l’épidémie conjonctivale consiste avant tout à rompre la chaîne de contamination main–œil. Celle-ci concerne avant tout le personnel soignant et l’entourage du patient atteint de conjonctivite. Ces règles concernent des mesures simples comme le lavage des mains, l’utilisation de linge de toilette personnel mais également une désinfection soigneuse de l’ensemble de l’appareillage. La prévention des conjonctivites liées aux germes des infections sexuellement transmissibles (IST), par l’instillation d’antibiotiques à la naissance chez toute femme à risque d’infection génitale, a permis de faire reculer ce fléau.
Les conjonctivites répondent généralement bien au traitement local. Les conjonctivites bactériennes sont nettement moins fréquentes que les conjonctivites virales. Les recommandations de l’ANSM ont clairement redéfini la place des antibiotiques qui restent limités aux formes sévères. La corticothérapie locale n’a pas sa place dans les conjonctivites infectieuses. La banalité de cette affection devra surtout rendre le praticien méfiant afin de ne pas méconnaître une autre cause. Une baisse d’acuité visuelle fait toujours remettre en cause le diagnostic de conjonctivite.
[1] Hovding G. Acute bacterial conjunctivitis. Acta Ophthalmol 2008 ; 86 : 5-17.
[2] Buznach N, Dagan R, Greenberg D. Clinical and bacterial characteristics of acute bacterial conjunctivitis in children in the antibiotic resistance era. Pediatr Infect Dis J 2005 ; 24 : 823-8.
[3] Hwang DG. Bacterial conjunctivitis. In : Pepose JS, Holland GN, Wilhelmus KR. Eds. Ocular infection & immunity. St-Louis : Mosby ; 1996, p. 799-817.
[4] Syed NA, Chandler JW. Bacterial conjunctivitis. In : Tabbara KF, Hyndiuk RA. Infections of the eye. Boston : Little, Brown and Co ; 1996.
[5] Creuzot-Garcher CBA. Conjonctivites bactériennes aiguës. In : Les infections oculaires. Bulletin des sociétés d’ophtalmologie de France. Lamy éditions ; 2010, p. 101-7.
[6] Afssaps. Collyre et autres topiques dans les infections oculaires superficielles. 2004.
[7] Speeg-Schatz C. Conjonctivites infectieuses du nouveau-né et de l’enfant. In : Les infections oculaires. Bulletin des sociétés d’ophtalmologie de France. Lamy éditions ; 2010, p. 108-10.
[8] Afssaps. Prophylaxie des infections conjonctivales du nouveau-né. 2010.
[9] Hammerschlag MR. Neonatal conjunctivitus. In : Pepose JS, Holland GN, Wilhelmus KR. Eds. Ocular infection & immunity. St-Louis : Mosby ; 1996, p. 831-42.
[10] Persson K, Ronnerstam R, Svanberg L, Pohla MA. Neonatal chlamydial eye infection : an epidemiological and clinical study. Br J Ophthalmol 1983 ; 67 : 700-4.
[11] Patton DL, Chan KY, Kuo CC, et al. In vitro growth of Chlamydia trachomatis in conjunctival and corneal epithelium. Invest Ophthalmol Vis Sci 1988 ; 29 : 1087-95.
[12] Orfila J. Generalities on Chlamydia. Clinical, diagnostic and therapeutic applications. J Fr Ophtalmol 1985 ; 8 : 193-7.
[13] Verin P, Gendre P, Andrianjafy H, Mortemousque B. Permanence of chlamydia in trachomatous tissue. Rev Int Trach Pathol Ocul Trop Subtrop Sante Publique 1990 ; 67 : 175-9.
[14] Goldschmidt P. Infections oculaires à chlamydiae. In : Les infections oculaires. Bulletin des sociétés d’ophtalmologie de France. Lamy éditions ; 2010, p. 111-21.
[15] Tabbara KF. Chlamydia : Trachoma and inclusion conjunctivitis. In : Tabbara KF, Hyndiuk RA. Infections of the eye. Boston : Little, Brown and Co ; 1996, p. 433-52.
[16] Thygeson P. Historical review of oculogenital disease. Am J Ophthalmol 1971 ; 71 : 975-85.
[17] Dawson CR SJ, Stephens RS. Chlamydial keratoconjunctivitis In Chlamydial keratoconjonctivitis. In : Pepose JS, Holland GN, Wilhelmus KR. Eds. Ocular infection & immunity. St-Louis : Mosby ; 1996, p. 818-29.
[18] Lewallen S, Courtright P. Anatomical factors influencing development of trichiasis and entropion in trachoma. Br J Ophthalmol 1991 ; 75 : 713-4.
[19] Blodi BA, Byrne KA, Tabbara KF. Goblet cell population among patients with inactive trachoma. Int Ophthalmol 1988 ; 12 : 41-5.
[20] Bailey RL, Hayes L, Pickett M, et al. Molecular epidemiology of trachoma in a Gambian village. Br J Ophthalmol 1994 ; 78 : 813-7.
[21] Talley AR, Garcia-Ferrer F, Laycock KA, et al. The use of polymerase chain reaction for the detection of chlamydial keratoconjunctivitis. Am J Ophthalmol 1992 ; 114 : 685-92.
[22] Sheikh A, Hurwitz B. Topical antibiotics for acute bacterial conjunctivitis : Cochrane systematic review and meta-analysis update. Br J Gen Pract 2005 ; 55 : 962-4.
[23] Bourcier T, Thomas F, Borderie V, et al. Bacterial keratitis : predisposing factors, clinical and microbiological review of 300 cases. Br J Ophthalmol 2003 ; 87 : 834-8.
[24] Cochereau I, Meddeb-Ouertani A, Khairallah M, et al. 3-day treatment with azithromycin 1.5 % eye drops versus 7-day treatment with tobramycin 0.3 % for purulent bacterial conjunctivitis : multicentre, randomised and controlled trial in adults and children. Br J Ophthalmol 2007 ; 91 : 465-9.
[25] Robert PY, Bourcier T, Meddeb-Ouertani A, et al. Efficacy assessment of azithromycin 1.5 % eye drops versus tobramycin 0.3 % on clinical signs of purulent bacterial conjunctivitis. J Fr Ophtalmol 2010 ; 33 : 241-8.
[26] Cochereau I, Goldschmidt P, Goepogui A, et al. Efficacy and safety of short duration azithromycin eye drops versus azithromycin single oral dose for the treatment of trachoma in children : a randomised, controlled, double-masked clinical trial. Br J Ophthalmol 2007 ; 91 : 667-72.
[27] Robert PY. How to prescribe topical antibiotics in ophthalmology. J Fr Ophtalmol 2007 ; 30 : 417-22.
M. Labetoulle, L. Bonin, A. Rousseau, M. M’Garrech, E. Barreau, T. Bourcier
Les infections cornéennes et conjonctivales virales non liées à herpes simplex virus (HSV) et au virus varicelle–zona (varicella-zoster virus ou VZV) se rencontrent surtout dans deux circonstances particulières : les maladies infectieuses éruptives et/ou pédiatriques, et les périodes épidémiques. Dans le premier cas, le contexte fait le diagnostic ; la kératite ou la conjonctivite sont rarement révélatrices d’une rougeole ou des oreillons par exemple. Ce peut être en revanche le cas dans certaines primo-infections à cytomégalovirus ou virus d’Epstein-Barr. Les atteintes observées en contexte épidémique sont essentiellement dues à un adénovirus, plus rarement à un entérovirus. L’identification de ces atteintes doit être rapide pour prendre les mesures sanitaires qui s’imposent. Enfin, des atteintes conjonctivales peuvent aussi s’observer dans un contexte d’arboviroses, maladies actuellement en développement en raison des modifications écologiques, favorisant la prolifération de leurs vecteurs principaux, les moustiques, dans certaines régions jusqu’alors épargnées.
En dehors d’herpes simplex virus (HSV) et du virus varicelle–zona (varicella-zoster virus ou VZV), dont les atteintes sont décrites au chapitre 24, il n’existe pas de traitement étiologique ayant fait la preuve clinique de son efficacité. Et pourtant, il reste essentiel de rechercher le plus précisément possible l’origine réelle de ces atteintes virales, car le reste de la prise en charge en dépend, notamment la recherche des autres localisations infectieuses et les mesures d’hygiène à adopter. À cet égard, nous avons fait le choix de classer les virus, non pas en fonction de leur famille scientifique, mais en fonction de la présence ou non d’une enveloppe lipidique (d’origine cellulaire) autour de la capside virale. On distingue ainsi les virus enveloppés des virus nus. Les premiers sont sensibles à la dessiccation et aux saponifiants, et leur transmission à l’homme passe par des contacts étroits via certains fluides biologiques (sang, salive, gouttelettes de Pflügge, voire larmes). À l’inverse, les virus nus sont particulièrement résistants à la dessiccation et aux techniques de nettoyage usuelles, ce qui explique leur transmission rapide par les contacts cutanés (mains sales) et les surfaces contaminées.
La primo-infection systémique au virus d’Epstein-Barr (EBV) est responsable du classique syndrome de mononucléose infectieuse (parfois aussi dû au cytomégalovirus), qui peut s’accompagner d’une conjonctivite folliculaire, voire nodulaire, uni- ou bilatérale. Les conjonctivites à EBV sont volontiers associées à une atteinte cornéenne épithéliale ou sous-épithéliale, à type de microdendrites stellaires [1, 2] ou d’opacités numulaires mimant une adénovirose [3].
Plus rarement, l’EBV peut entraîner des kératites stromales, essentiellement sous deux aspects :
-
opacités stromales antérieures granulaires et multifocales, bien limitées et disposées en anneaux ;
-
opacités périphériques mal définies, en taches de formes diverses [4–6].
Certains auteurs ont rapporté des troubles de la motilité oculaire dans le cadre d’une atteinte oculaire antérieure à EBV [7], de même que la possibilité d’épisclérite et d’uvéite [8].
L’atteinte de la surface oculaire à EBV peut faire partie d’un syndrome oculoglandulaire de Parinaud [4] qui associe une conjonctivite unilatérale nodulaire et des adénopathies préauriculaires et/ou sous-maxillaires homolatérales. L’EBV en est une des principales causes, avec le cytomégalovirus, le virus de Newcastle, et d’autres types d’agents infectieux comme Bartonella henselae, bactérie responsable de la maladie des griffes du chat.
Enfin, notons que plusieurs études ont retrouvé la présence d’EBV dans les larmes de patients asymptomatiques ou présentant un syndrome de sécheresse oculaire [9, 10], ce qui rend un peu plus difficile d’attribuer de façon certaine des signes de conjonctivite à ce virus [4].
Les atteintes oculaires à cytomégalovirus (CMV) ont longtemps été décrites surtout pour le pôle postérieur (rétinite), chez des patients immunodéprimés [11, 12]. Chez les patients immunocompétents, les conjonctivites à CMV sont classiquement décrites dans le cadre des syndromes mononucléosiques liés à une primo-infection par ce virus [13]. Il peut s’agir d’atteintes uni- ou bilatérales, folliculaires et/ou catarrhales (fig. 6-12). Les conjonctivites à CMV peuvent cependant traduire un état d’immunodépression partielle, comme chez les transplantés rénaux [14], mais elles ont finalement été assez peu décrites dans le cadre du sida (syndrome d’immunodéficience acquise), même chez les patients atteints de rétinite à CMV [15, 16]. Des kératites peuvent aussi être rencontrées, avec des dendrites atypiques (peu de branchements), mais récidivantes et rebelles aux antiviraux de première génération [17].

Fig. 6-12 Opacités cornéennes nummulaires dans le cadre d’un syndrome de primo-infection à CMV.
Il s’agit d’une entité nouvellement identifiée, dont la fréquence réelle est encore difficile à apprécier. La description princeps des signes cliniques d’endothélite inflammatoire revient à Khodadoust et Attarzadeh en 1982 : œdème cornéen plus ou moins focal avec précipités rétrodescemétiques en regard, effet Tyndall minime et possible destruction de l’endothélium au décours [18]. Parmi les différents types d’endothélites, celles dites « linéaires », en raison de la présence d’une ligne (dite de Khodadoust) entre les parties saines et pathologiques de l’endothélium, sont les plus sévères du fait du risque majeur de perte endothéliale [19]. Il est rapidement apparu que ces endothélites pouvaient être dues à une infection virale, en particulier par HSV [20, 21] et VZV [22]. De façon anecdotique, le virus des oreillons a aussi été rapporté dans un cas [23]. L’observation d’une réponse partielle de certaines endothélites d’allure virale aux antiviraux conventionnels (aciclovir, valaciclovir, famciclovir) et l’utilisation conjointe de la PCR (polymerase chain reaction) sur l’humeur aqueuse des patients ont permis de démontrer que le CMV est une autre cause possible d’endothélite. La première publication revient à Koizumi en 2006 [24]. Depuis, il est apparu que ces endothélites à CMV peuvent prendre des formes classiques : disciformes, diffuses ou linéaires [25–27]. Il est désormais établi que certaines présentations cliniques sont particulièrement évocatrices, comme celles avec des atteintes multifocales de l’endothélium en « œil de hibou » ou en « pièce de monnaie » [24, 27, 28]. Ce type d’atteintes peut survenir spontanément, ou dans les suites d’une endothélite apparemment herpétique mais devenant de plus en plus résistante au traitement antiviral conventionnel, ou enfin dans les suites d’une greffe de cornée (diagnostic différentiel avec un rejet de greffe). La prise en charge consiste à tenter de faire la preuve du CMV (PCR sur l’humeur aqueuse) et à débuter un traitement antiviral réellement actif sur ce virus, en pratique le valganciclovir per os. En raison du risque majeur de récidive, il est souvent nécessaire d’instaurer un traitement d’entretien pendant quelques mois ou années, d’autant que ces endothélites à CMV peuvent s’associer avec des uvéites à CMV [29], notamment de type Posner-Schlossman, dont le risque principal est le développement d’un glaucome.
Le virus HHV-6 (human herpesvirus) peut induire des conjonctivites papillaires, isolées ou associées à une ulcération épithéliale [10, 30]. Lors d’une recherche systématique chez des patients atteints de divers troubles de la surface oculaire, Robert et al. l’ont mis en évidence dans plusieurs cas de sécheresse oculaire apparemment idiopathique [10].
Le virus HHV-8 est l’agent responsable du sarcome de Kaposi, dont la localisation conjonctivale est classique (fig. 6-13) [12, 31]. L’atteinte, typique à la phase d’état, peut débuter par des tableaux trompeurs, comme une rougeur localisée de la conjonctive bulbaire, mimant une hémorragie sous-conjonctivale ou un chalazion [32].

Fig. 6-13 Localisation conjonctivale d’une maladie de Kaposi, due à une infection à HHV-8 chez un patient fortement immunodéprimé (collection P. Le Hoang).
(Source : Rapport SFO 2000. Masson ; 2000, p. 421.)
Le virus de la variole, déclaré éradiqué en octobre 1977, était une cause fréquente d’infection de la surface oculaire, avec des atteintes conjonctivales, palpébrales et cornéennes parfois sévères [33].
Dorénavant, le principal poxvirus responsable d’une atteinte de la surface oculaire est l’agent responsable du Molluscum contagiosum (fig. 6-14). Ces conjonctivites se rencontrent principalement chez l’enfant et le jeune adulte, avec une prévalence estimée à environ 1 % dans la population préscolaire anglaise [34]. Le virus se propage par le biais des mains contaminées lors du grattage des multiples lésions cutanées, typiques de cette atteinte virale. Elles sont facilement identifiables sur le visage, sous forme d’une petite tuméfaction de 1 à 2 mm de diamètre, avec en son centre une dépression (ombilic), pathognomonique de l’affection. La conjonctivite peut être chronique et folliculaire, parfois accompagnée d’une kératopathie ponctuée épithéliale [33, 35]. L’atteinte oculaire est le plus souvent seulement réactionnelle aux lésions cutanées situées à distance, l’ablation des lésions cutanées induisant la disparition de l’inflammation conjonctivale. Le traitement de la conjonctivite consiste donc en l’ablation des lésions cutanées par curetage mécanique, idéalement complété d’une cryoapplication du site arasé. Pour être efficace, le traitement doit traiter toutes les lésions, en raison du risque de rechute par auto-inoculation à partir des lésions restantes.
Il peut exister, rarement, des cas de Molluscum contagiosum de la conjonctive ou du limbe, notamment chez les patients immunodéprimés [7, 36]. Dans ce cas, l’ablation mécanique est requise pour obtenir la guérison.
Quelques rares cas d’infection de la surface oculaire ont aussi été décrits pour d’autres Poxviridae, essentiellement par contamination avec le virus de la vaccine, qui confère une immunité croisée contre la variole, mais aussi des zoonoses toujours actives comme le cowpox (présent chez les rongeurs dans l’ouest de la France) [37, 38].

Fig. 6-14 Localisation conjonctivale d’un Molluscum contagiosum chez un patient fortement immunodéprimé (collection P. Le Hoang).
(Source : Rapport SFO 2000. Masson ; 2000, p. 418.)
La grippe peut entraîner une conjonctivite catarrhale, folliculaire, avec parfois des hémorragies sous-conjonctivales. Des atteintes cornéennes sont possibles (fig. 6-15), surtout sous forme ponctuée superficielle [7]. Elles restent très rares malgré la fréquence de la grippe dans la population générale [33].

Fig. 6-15 Opacité avec œdème stromal inférieur dans le cadre d’une grippe (collection H. Offret).
Elles se manifestent pendant les premiers jours de l’invasion virale, sous forme catarrhale le plus souvent, avec parfois une tache de Koplick (pathognomonique de la rougeole), directement visible en regard de la conjonctive. L’atteinte est souvent associée à une kératite, qui peut être ponctuée superficielle, ou avec des dépôts intrastromaux antérieurs, qui peuvent même prendre le colorant (fig. 6-16) [39–43]. Ce type d’atteintes est en recrudescence depuis quelques années en France en raison de la baisse de la couverture vaccinale dans la population. Le pronostic demeure en général excellent, sauf chez les enfants dénutris (déficit en vitamine A) [44] et/ou milieu défavorisé) pour lesquels la surinfection bactérienne peut être sévère, avec des tableaux de fausses membranes, d’ulcérations majeures, voire de perforations (risque de perte du globe ou de taie centrale). La rougeole demeure d’ailleurs de nos jours une cause significative de cécité dans le monde, contre laquelle la vaccination et l’amélioration des conditions de vie sont les meilleures armes [8, 44].

Fig. 6-16 Atteintes épithéliales multiples, prenant légèrement le colorant, avec opacités stromales antérieures en regard, dans le cadre d’une rougeole.
Les oreillons peuvent s’accompagner d’une conjonctivite folliculaire ou folliculo-papillaire, qui apparaît en général en même temps que les autres signes habituels de l’infection ourlienne. Elle peut s’accompagner d’un chémosis et d’hémorragies sous-conjonctivales. Des formes sévères peuvent aussi associer une atteinte conjonctivale à une épisclérite, une sclérite, une uvéite antérieure, une dacryoadénite [7, 45, 46]. Les kératites sont rares. Elles peuvent apparaître 5 à 11 jours après la parotidite. Les descriptions initiales (historiques) font état de complications sévères, avec opacités inflammatoires centrales majeures, laissant une zone saine autour du limbe. La résolution se faisait alors au prix d’opacités nébuleuses, sans néovascularisation [33].
Elles sont surtout observées dans les populations à risque (vétérinaires, éleveurs de volailles, personnel d’animalerie de laboratoire), le virus de Newcastle étant responsable de pneumo-encéphalite mortelle chez les volailles. Deux jours après le contact avec un animal atteint (ou une projection de matériel infecté), apparaît une conjonctivite folliculaire, associée à une fébricule et une adénopathie prétragienne (pouvant entrer dans le cadre d’un syndrome oculoglandulaire de Parinaud). Une kératite peut se développer, surtout épithéliale, voire avec des opacités sous-épithéliales. La guérison survient spontanément en 1 à 2 semaines [7, 47–50].
Le principal représentant chez l’homme est le virus de la rubéole, qui peut induire des lésions oculaires lors d’une infection maternofœtale ou chez l’adulte non vacciné (fig. 6-17). Dans ce dernier cas, les conjonctivites se rencontrent pendant la phase éruptive de la maladie. Elles sont en général bénignes, folliculaires, éventuellement associées à une kératite ponctuée superficielle [51, 52]. Quelques patients peuvent développer des kératites ponctuées, non spécifiques, qui apparaissent une semaine après le rash cutané [33]. Quant à la rubéole congénitale, théoriquement évitée grâce au dépistage systématique en début de grossesse, elle peut s’accompagner d’atteinte cornéenne, avec en particulier des leucomes, kératocônes et hydrops [33, 53].

Fig. 6-17 Atteinte du segment antérieur de l’œil dans le cadre d’une rubéole congénitale (collection H. Offret et F. Niessen).
(Source : Rapport SFO 2000. Masson ; 2000, p. 190.)
Les arbovirus sont, par définition, des virus transmis par des arthropodes suceurs de sang : moustiques, tiques et phlébotomes. Les territoires francophones sont possiblement touchés par ces maladies, notamment dans les départements français d’outre-mer et certains pays francophones, équatoriaux et tropicaux. Suite au réchauffement climatique, les vecteurs de transmission ont tendance à remonter vers des latitudes initialement épargnées, et les populations de la métropole française peuvent dorénavant être touchées. De nombreux arbovirus continuent régulièrement d’être découverts, nous ne traiterons que les plus classiques d’entre eux en l’état actuel des connaissances.
Il peut être transmis par plusieurs moustiques du genre Aedes, largement présents à La Réunion, à Mayotte, par exemple, mais aussi plus récemment aux Antilles. Ils sont aussi présents dans le sud de la métropole française, mais les cas autochtones de virus Chikungunya restent rares. Si le virus Chikungunya est connu pour provoquer des inflammations importantes des tissus intraoculaires (uvéites, rétinites) [54–57], les conjonctivites, épisclérites et kératites (essentiellement dendritiques) sont plus rares ; on les retrouve éventuellement dans le cadre d’une infection systématique (fig. 6-18) [56–59]. Une étude récente a mis en évidence la possibilité de transmission du virus via les greffons cornéens prélevés dans les zones à risque d’infection fréquente, ce qui souligne l’importance du dépistage de cette infection, éventuellement asymptomatique chez les donneurs [60].

Fig. 6-18 Précipités rétrodescemétiques dans le cadre d’une infection aiguë à virus Chikungunya.
Il est principalement transmis par le moustique Aedes aegypti, mais d’autres moustiques de genre Aedes peuvent servir de vecteur. Le territoire de développement du virus de la dengue a tendance à augmenter significativement depuis quelques années. Initialement confiné aux régions tropicales (dont les Antilles, la Nouvelle-Calédonie, la Polynésie), il a récemment été décrit en Europe, et même en métropole française [61]. L’atteinte conjonctivale survient pendant la phase aiguë, mais sans particularité clinique dans la plupart des cas, sinon d’éventuelles formes hémorragiques [62, 63].
Il est transmis pas le moustique Aedes aegypti. Aucun cas n’a été acquis en métropole depuis plus de 40 ans, mais la vaccination est obligatoire dans d’autres régions, dont la Guyane française. Les conjonctivites liées au virus de la fièvre jaune sont caractérisées par la présence d’hémorragies sous-conjonctivales sur un fond hyperémique et ictérique, associé à un œdème palpébral et facial. Elles surviennent pendant la phase aiguë de la maladie [64].
Le virus est transmis par les moustiques du genre Culex et Aedes. Il a surtout été décrit en Afrique, le long de la vallée du rift, en Égypte et en Tunisie. Outre les classiques complications du segment postérieur de l’œil [65], il peut aussi entraîner des conjonctivites [66, 67].
Il est transmis par les moustiques du genre Culex et sévit dans de nombreux territoires. Il a récemment été décrit autour du bassin méditerranéen, dont l’Italie. Des conjonctivites ont été décrites dans le cadre d’infections plus sévères par le West Nile virus, associant myalgies, céphalées, lymphadénopathies, roséole, voire encéphalite et/ou méningite [68, 69].
Elles sont très souvent associées à une atteinte cornéenne a minima, et l’on traitera ici indifféremment des conjonctivites et des kératoconjonctivites à adénovirus.
Il existe plusieurs formes cliniques d’infection adénovirale de la surface oculaire, dont les caractères communs sont la contagiosité et le possible développement de complications cornéennes à type de dépôts inflammatoires sous-épithéliaux.
Après le contage, les signes inflammatoires apparaissent en 2 à 21 jours, et se résolvent dans la plupart des cas en 1 à 3 semaines. Cependant, la durée de sécrétion virale dans les larmes est d’au moins 2 semaines [72], voire plus longtemps pour certains patients, puisque 73 % des flacons utilisés jusqu’à 9 semaines après le début de la conjonctivite contiennent du virus [73]. Il semble même exister des possibilités de portage sain d’adénovirus, et l’immunité conférée par un épisode infectieux n’est valable que pour le sérotype en cause (sachant qu’il existe plusieurs dizaines de sérotypes d’adénovirus). L’adénovirus étant un virus sans enveloppe d’origine cellulaire, il est particulièrement résistant à la dessiccation et aux techniques simples de nettoyage (des produits virucides sont en revanche disponibles pour nettoyer les surfaces contaminées). L’adénovirus peut rester infectieux hors du corps humain pendant une longue période, plus de 10 jours en milieu sec et près de 20 jours en milieu humide [74]. Une étude a d’ailleurs montré que la moitié des patients atteints sont porteurs de particules virales infectieuses sur leurs mains [75]. Ces données expliquent l’importance des mesures d’hygiène pour limiter le risque épidémique, à la fois pour le patient et les équipes soignantes [76]. Ces mesures d’hygiène font pleinement partie de la stratégie thérapeutique, car elles doivent être appliquées dès le début de la prise en charge, dès que le diagnostic d’infection adénovirale est évoqué. Les principales mesures sont :
-
la création d’un parcours court, dans le centre de soins, pour ce type de patients (limitant le contact avec les personnes saines) ;
-
pour les personnels soignants : le port de gants, l’utilisation d’instruments à usage unique et, à défaut, le nettoyage du matériel avec une solution virucide ;
-
pour le patient et son entourage : l’apprentissage des règles d’hygiène, le lavage des mains, l’utilisation de linge personnel pour la toilette, la réduction des contacts et l’arrêt de travail s’il est au contact du public [77].
Les atteintes cliniques des infections de la surface oculaire par l’adénovirus dépendent en grande partie du sérotype en cause [8, 78–80]. Les sérotypes 1, 2, 4 et 6 sont surtout responsables d’une conjonctivite folliculaire (fig. 6-19), sans atteinte cornéenne, qui sévit essentiellement dans les communautés pédiatriques. Des complications pulmonaires peuvent être rencontrées. Une forme chronique de ce type d’atteintes a parfois été rapportée avec les sérotypes 2, 3, 4 et 5. En revanche, les sérotypes 3, 4 et 7 (moins souvent 1, 2, 5, 11, 14, 19, 21, 37) sont typiquement responsables de la forme APC (adéno-pharyngo-conjonctivite). Il peut exister des formes sporadiques, mais elles sont le plus souvent rencontrées dans un cadre épidémique, éventuellement par le biais des eaux de piscine contaminées. Le syndrome infectieux associant fièvre, ganglions et pharyngite peut être eu premier plan. La conjonctivite peut être folliculaire simple ou générant des pétéchies. Le risque d’atteinte cornéenne, en particulier à long terme, serait moins important dans cette forme clinique que dans la forme épidémique pure. Les sérotypes 8, 19 et 37 (mais aussi 9, 10, 13, 30) sont les principaux responsables de la forme dite kératoconjonctivite épidémique (KCE), plus volontiers rencontrée chez l’adulte, chez qui apparaît une conjonctivite folliculaire environ 7 à 21 jours après le contage. Les signes fonctionnels sont souvent bruyants : sensation de corps étranger, de brûlures, larmoiement abondant, dans un contexte de fébricule avec ganglions prétragiens (15 à 95 % des cas) ou sous-mandibulaire, voire parotidite et signes d’atteinte respiratoire. La conjonctivite peut être hémorragique, en règle avec un chémosis et un larmoiement importants. Elle persiste sur un mode aigu pendant 1 à 2 semaines, pendant lesquels peuvent apparaître des pseudo-membranes et surtout une atteinte cornéenne [81], finalement retrouvée jusque dans 80 % des cas selon certaines séries [79]. À la phase aiguë de l’infection, la kératite est épithéliale, sous forme ponctuée superficielle (fig. 6-20). Des infiltrats lymphocytaires peuvent se développer dans les jours à semaines qui suivent, à l’origine d’opacités sous-épithéliales (fig. 6-21), en nombre plus ou moins important. Elles peuvent persister plusieurs mois et gêner la vision lorsqu’elles sont dans l’axe optique. Leur prise en charge dépend de la gêne visuelle induite [78, 82].
D’autres complications peuvent aussi être observées au décours d’une infection adénovirale. Les formes sévères (pseudo-membraneuses) peuvent générer des ptosis, des symblépharons et une obstruction canaliculaire, immédiatement en aval des méats lacrymaux [78, 83, 84]. De façon beaucoup plus fréquente, apparaît un syndrome de sécheresse oculaire, souvent ressenti par le patient comme une persistance de son infection. Il convient de le rassurer tout en insistant sur la prise en charge symptomatique du syndrome sec, qui perdure volontiers plusieurs mois.
Enfin, chez l’enfant, l’adénovirus peut être impliqué dans un syndrome de Kawasaki (incluant conjonctivite bulbaire, rash cutané, fièvre, chéléite et desquamation des extrémités) [85].
Les atteintes adénovirales posent parfois des difficultés de diagnostic différentiel. Le contage par l’eau de piscine et la présence de ganglions prétragiens sont retrouvés avec certaines atteintes chlamydiennes, et les eaux non traitées peuvent aussi être des vecteurs d’autres infections cornéennes, comme les amibes. Les formes hémorragiques doivent aussi faire évoquer une atteinte entérovirale, surtout chez un patient revenant d’une zone à risque (Afrique du Nord par exemple). Quant aux formes très inflammatoires, avec de fausses membranes, elles peuvent classiquement être aussi observées dans les conjonctivites streptococciques, voire dans les atteintes diphtériques exceptionnelles (on parle alors de vraies membranes, impossibles à peler sans arracher la conjonctive attenante).
Des tests immuno-enzymatiques sont désormais disponibles pour le diagnostic rapide, au cabinet, des infections adénovirales. La spécificité serait proche de 100 %, et la sensibilité est d’environ 70 %. Il s’agit toutefois d’un test de dépistage, qui ne permet pas de connaître le sérotype en cause [80, 86]. Le prélèvement de larmes (par le biais d’une bandelette de Schirmer) permet aussi d’amplifier directement le génome viral par PCR, et de rechercher les autres agents infectieux pouvant mimer une infection adénovirale [87].

Fig. 6-19 Kératoconjonctivite adénovirale en phase aiguë, dans sa forme la plus courante (conjonctivite folliculaire).

Fig. 6-20 Kératite ponctuée superficielle chez le même patient que dans la figure 6-19.

Fig. 6-21 Opacités cornéennes sous-épithéliales au décours d’une kératoconjonctivite adénovirale.
L’aspect le plus évocateur des conjonctivites liées aux virus du genre Enterovirus est la forme aiguë hémorragique en contexte épidémique. L’incubation est très courte (24 h), et le début des symptômes est brutal, associant œdème palpébral, chémosis, larmoiement. La conjonctivite touche en général les deux yeux d’emblée, avec des follicules très marqués, prédominant dans les deux culs-de-sac. La conjonctive bulbaire supérieure est typiquement le siège d’hémorragies multiples, dont la taille varie de simples pétéchies à de larges placards dans les formes les plus agressives. Les signes fonctionnels sont majeurs, à type de sensation de corps étranger, de brûlures, voire de photophobie en cas d’atteinte cornéenne (fig. 6-22). Il s’agit en général d’une kératite ponctuée prédominant dans la cornée inférieure [33]. Cette dernière apparaît souvent dans un second temps, 2 à 4 jours après la conjonctivite, sous forme de ponctuations superficielles qui peuvent devenir confluentes. La présence de ganglions prétragiens douloureux est notée dans 15 à 40 % des cas. Leur apparition est légèrement retardée (entre 2 ou 3 jours après le début de la conjonctivite). Malgré l’aspect impressionnant à la phase aiguë, l’évolution est souvent favorable en 1 semaine environ, généralement sans opacités cornéennes sous-épithéliales au décours. Cependant, ces opacités peuvent aussi être observées dans ce contexte. Des complications inflammatoires intraoculaires peuvent aussi être vues (iridocyclite hypertensive, névrite rétrobulbaire), mais elles sont rares [88].
Comme pour les adénovirus, la transmission des entérovirus se fait surtout par les mains et les eaux souillées, en particulier par les matières fécales (les entérovirus ont un tropisme intestinal). Les deux virus les plus classiquement en cause sont l’entérovirus 70 (EV70) et le coxsackievirus A24 (CA24) [7, 89–91]. Outre les intestins, les entérovirus ont aussi un tropisme respiratoire et neurologique, mais ce type de complications est rare : seul 1/10 000e des conjonctivites à EV70 se compliquent de signes neurologiques (atteintes des nerfs crâniens et/ou périphériques), qui peuvent suivre les signes oculaires de 1 à 8 semaines [92, 93].
D’autres coxsackievirus A ont aussi été rapportés, dans le cadre d’un syndrome « pied–main–bouche » [94], les atteintes conjonctivales ou cornéennes à coxsackievirus B, echovirus 11 et 7 étant encore plus rares [95, 96]. Ces dernières atteintes touchent volontiers les personnels de laboratoire, en général avec une guérison rapide.
Le diagnostic des conjonctivites à Enterovirus est le plus souvent posé sur l’aspect clinique et les données épidémiologiques. On peut toutefois s’aider d’une recherche du génome viral par PCR dans les larmes, ou d’une élévation des anticorps dans le sang ou les larmes [97].

Fig. 6-22 Opacités cornéennes sous-épithéliales sévères chez un patient ayant développé une kératoconjonctivite présumée d’origine entérovirale (acquise en période épidémique lors d’un voyage en Afrique du Nord).
Les papillomavirus humains (human papilloma virus ou HPV) peuvent entraîner une conjonctivite chronique réactionnelle à la présence d’un ou de plusieurs papillomes conjonctivaux. Ils prennent la forme d’une tumeur framboisée, en général pédiculée, volontiers située dans les culs-de-sac ou en regard du canthus interne (fig. 6-23). L’arborescence vasculaire, visible en transparence, est évocatrice de l’origine papillomateuse, mais elle peut être difficile à observer dans les formes kératinisées. Certaines atteintes peuvent être planes, sessiles et couvrir à la fois la conjonctive et la cornée, prenant alors l’aspect d’un ptérygion [98]. D’ailleurs, plusieurs études ont montré une sur-représentation de la présence de HPV dans les ptérygions par rapport à des biopsies conjonctivales réalisées au cours d’autres types d’interventions [99, 100]. Cependant, la liaison statistique n’était pas majeure et, à l’inverse, la présence de HPV dans des tissus apparemment sains est finalement loin d’être exceptionnelle [101, 102].
De nombreux sérotypes de HPV peuvent infecter la conjonctive. La biopsie–exérèse permet à la fois de vérifier le caractère bénin de la lésion et de déterminer le sérotype en cause. Cette étape diagnostique est importante car les sérotypes 16 ou 18 exposent au risque de transformation cancéreuse, à l’image des lésions génitales dont ils sont aussi une cause majeure [98]. La contamination oculaire semble d’ailleurs passer par contact cutané, à partir d’autres sites infectés, sur le patient ou ses proches. La recherche d’autres lésions corporelles est donc particulièrement importante en cas de lésion oculaire à HPV-16 ou 18 [7, 103].

Fig. 6-23 Tumeur conjonctivale bénigne liée à une infection à papillomavirus.
L’apparition d’un syndrome de sécheresse oculaire dans les suites d’une infection aiguë de la surface oculaire est bien connue de tous les cliniciens. Pour les atteintes virales, l’exemple le plus classique revient aux kératoconjonctivites adénovirales. Après la disparition depuis plusieurs semaines des signes inflammatoires, les patients continuent parfois de décrire des signes subjectifs de sécheresse (brûlures, piqûres, etc.) et la conjonctive et la cornée sont marquées après instillation de fluorescéine. La sécheresse oculaire est probablement la conséquence du syndrome inflammatoire aigu, ayant décompensé l’équilibre de la surface oculaire, selon les principes pathogéniques en cercle vicieux de syndrome sec [104]. Avec le temps et des traitements topiques adaptés (mouillants), les signes ont tendance à régresser.
Une sécheresse oculaire bilatérale peut aussi survenir dans le cadre des kératites herpétiques récidivantes, alors même que ces dernières sont unilatérales dans la presque totalité des cas. Ce phénomène est probablement lié à l’altération de l’innervation cornéenne induite par les multiples épisodes de kératites, qui à terme perturbent le message neuronal du réflexe lacrymal, et une perte bilatérale des capacités sécrétrices [105].
Enfin, la sécheresse oculaire peut apparaître en l’absence de toute atteinte virale directe de la cornée, probablement par le biais de mécanismes immunitaires déclenchés par l’infection virale. Ce type de tableaux cliniques a été décrit dans le cadre des infections à HTLV-1 [106–109], VHC (virus de l’hépatite C) [110, 111], VIH [12] et même EBV et HHV-6 [9, 10, 112].
[1] Wilhelmus KR. Ocular involvement in infectious mononucleosis. Am J Ophthalmol 1981 ; 91 : 117-8.
[2] Pinnolis M, McCulley JP, Urman JD. Nummular keratitis associated with infectious mononucleosis. Am J Ophthalmol 1980 ; 89 : 791-4.
[3] Matoba AY, Jones DB. Corneal subepithelial infiltrates associated with systemic Epstein-Barr viral infection. Ophthalmology 1987 ; 94 : 1669-71.
[4] Matoba AY. Ocular disease associated with Epstein-Barr virus infection. Surv Ophthalmol 1990 ; 35 : 145-50.
[5] Wong KW, D’Amico DJ, Hedges TR, et al. Ocular involvement associated with chronic Epstein-Barr virus disease. Arch Ophthalmol 1987 ; 105 : 788-92.
[6] Palay DA, Litoff D, Krachmer JH. Stromal keratitis associated with Epstein-Barr virus infection in a young child. Arch Ophthalmol 1993 ; 111 : 1323-4.
[7] Renard G. Pathologies de la cornée et de la conjonctive. Autres atteintes virales. In : Offret H. Ed. Œil et virus. Paris : Masson ; 2000.
[8] Alvarenga L, Scarpi M, Mannis MJ. Viral conjunctivitis. In : Krachmer JH, Mannis MJ, Holland EJ. Eds. Cornea-fundamentals, diagnosis and management. Mosby-Elsevier ; 2011.
[9] Willoughby CE, Baker K, Kaye SB, et al. Epstein-Barr virus (types 1 and 2) in the tear film in Sjogren’s syndrome and HIV infection. J Med Virol 2002 ; 68 : 378-83.
[10] Robert PY, Traccard I, Adenis JP, et al. Multiplex detection of herpesviruses in tear fluid using the « stair primers » pcr method : prospective study of 93 patients. J Med Virol 2002 ; 66 : 506-11.
[11] Newman H, Gooding C. Viral ocular manifestations : a broad overview. Rev Med Virol 2013 ; 23 : 281-94.
[12] Lehoang P, Girard B, Rousselie F. Œil et Sida. In : Lehoang P, Girard B, Rousselie F. Eds. Œil et Sida. Paris : Doin ; 1989.
[13] Garau J, Kabins S, Denosaquo S, Lee G, Keller R. Spontaneous cytomegalovirus mononucleosis with conjunctivitis. Arch Intern Med 1977 ; 137 : 1631-2.
[14] Pour-Reza-Gholi F, Labibi A, Farrokhi F, et al. Signs and symptoms of cytomegalovirus disease in kidney transplant recipients. Transplant Proc 2005 ; 37 : 3056-8.
[15] Brown HH, Glasgow BJ, Holland GN, Foos RY. Cytomegalovirus infection of the conjunctiva in AIDS. Am J Ophthalmol 1988 ; 106 : 102-4.
[16] Brody JM, Butrus SI, Laby DM, et al. Anterior segment findings in AIDS patients with cytomegalovirus retinitis. Graefes Arch ClinExp Ophthalmol 1995 ; 233 : 374-6.
[17] Wilhelmus KR, Font RL, Lehmann RP, Cernoch PL. Cytomegalovirus keratitis in acquired immunodeficiency syndrome [clinical conference]. Arch Ophthalmol 1996 ; 114 : 869-72.
[18] Khodadoust AA, Attarzadeh A. Presumed autoimmune corneal endotheliopathy. Am J Ophthalmol 1982 ; 93 : 718-22.
[19] Suzuki T, Ohashi Y. Corneal endotheliitis. Semin Ophthalmol 2008 ; 23 : 235-40.
[20] Robin JB, Steigner JB, Kaufman HE. Progressive herpetic corneal endotheliitis. Am J Ophthalmol 1985 ; 100 : 336-7.
[21] Ohashi Y, Yamamoto S, Nishida K, et al. Demonstration of herpes simplex virus DNA in idiopathic corneal endotheliopathy. Am J Ophthalmol 1991 ; 112 : 419-23.
[22] Maudgal PC, Missotten L, De Clercq E, Descamps J. Varicella-zoster virus in the human corneal endothelium : a case report. Bull Soc Belge Ophtalmol 1980 ; 190 : 71-86.
[23] Singh K, Sodhi PK. Mumps-induced corneal endotheliitis. Cornea 2004 ; 23 : 400-2.
[24] Koizumi N, Yamasaki K, Kawasaki S, et al. Cytomegalovirus in aqueous humor from an eye with corneal endotheliitis. Am J Ophthalmol 2006 ; 141 : 564-5.
[25] Hori Y, Maeda N, Kosaki R, Inoue T, Tano Y. Three cases of idiopathic « multiple-parallel-line » endotheliitis. Cornea 2008 ; 27 : 103-6.
[26] Alfawaz A. Cytomegalovirus-related corneal endotheliitis : a review article. Saudi J Ophthalmol 2013 ; 27 : 47-9.
[27] Koizumi N, Inatomi T, Suzuki T, et al. For The Japan Corneal Endotheliitis Study Group. Clinical features and management of cytomegalovirus corneal endotheliitis : analysis of 106 cases from the Japan corneal endotheliitis study. Br J Ophthalmol 2014.
[28] Koizumi N, Suzuki T, Uno T, et al. Cytomegalovirus as an etiologic factor in corneal endotheliitis. Ophthalmology 2008 ; 115 : 292-7 e3.
[29] Kongyai N, Sirirungsi W, Pathanapitoon K, et al. Viral causes of unexplained anterior uveitis in Thailand. Eye (Lond) 2012 ; 26 : 529-34.
[30] Boto-De-Los-Bueis A, Romero Gomez MP, Del Hierro Zarzuelo A, et al. Recurrent ocular surface inflammation associated with human herpesvirus 6 infection. Eye Contact Lens 2013.
[31] Jeng BH, Holland GN, Lowder CY, et al. Anterior segment and external ocular disorders associated with human immunodeficiency virus disease. Surv Ophthalmol 2007 ; 52 : 329-68.
[32] Dugel PU, Gill PS, Frangieh GT, Rao NA. Ocular adnexal Kaposi’s sarcoma in acquired immunodeficiency syndrome. Am J Ophthalmol 1990 ; 110 : 500-3.
[33] Chern KC, Meisler DM. Less common viral corneal infections. In : Krachmer JH, Mannis MJ, Holland EJ. Eds. Cornea-fundamentals, diagnosis and management. Mosby-Elsevier ; 2011.
[34] Pannell RS, Fleming DM, Cross KW. The incidence of molluscum contagiosum, scabies and lichen planus. Epidemiol Infect 2005 ; 133 : 985-91.
[35] Robinson MR, Udell IJ, Garber PF, et al. Molluscum contagiosum of the eyelids in patients with acquired immune deficiency syndrome. Ophthalmology 1992 ; 99 : 1745-7.
[36] Merisier H, Cochereau I, Hoang-Xuan T, et al. Multiple molluscum contagiosum lesions of the limbus in a patient with HIV infection. Br J Ophthalmol 1995 ; 79 : 393-4.
[37] Lee SF, Buller R, Chansue E, et al. Vaccinia keratouveitis manifesting as a masquerade syndrome. Am J Ophthalmol 1994 ; 117 : 480-7.
[38] Schwarzer H, Kurth A, Hermel M, Plange N. Severe ulcerative keratitis in ocular cowpox infection. Graefes Arch Clin Exp Ophthalmol 2013 ; 251 : 1451-2.
[39] M’Garrech M, Gendron G, De Monchy I, et al. Corneal manifestations of measles in the unvaccinated adult : two typical cases during an epidemic. J Fr Ophtalmol 2013 ; 36 : 197-201.
[40] Kayikcioglu O, Kir E, Soyler M, Guler C, Irkec M. Ocular findings in a measles epidemic among young adults. Ocul Immunol Inflamm 2000 ; 8 : 59-62.
[41] Deckard PS, Bergstrom TJ. Rubeola keratitis. Ophthalmology 1981 ; 88 : 810-3.
[42] Pavlopoulos GP, Giannakos GI, Theodosiadis PG, et al. Rubeola keratitis : a photographic study of corneal lesions. Cornea 2008 ; 27 : 411-6.
[43] Yasunaga H, Shi Y, Takeuchi M, et al. Measles-related hospitalizations and complications in Japan, 2007-2008. Intern Med 2010 ; 49 : 1965-70.
[44] Bowman RJ, Faal H, Dolin P, Johnson GJ. Non-trachomatous corneal opacities in the Gambia--aetiology and visual burden. Eye (Lond) 2002 ; 16 : 27-32.
[45] Meyer RF, Sullivan JH, Oh JO. Mumps conjunctivitis. Am J Ophthalmol 1974 ; 78 : 1022-4.
[46] Kalkan A, Ozden M, Yilmaz T, et al. A case of mumps conjunctivitis : detection of the virus RNA by nested PCR in tear sample. Scand J Infect Dis 2004 ; 36 : 697-700.
[47] Hales RH, Ostler HB. Newcastle disease conjunctivitis with subepithelial infiltrates. Br J Ophthalmol 1973 ; 57 : 694-7.
[48] AlexandeR DJ. Newcastle disease and other avian paramyxoviruses. Rev Sci Tech 2000 ; 19 : 443-62.
[49] Capua I, Alexander DJ. Human health implications of avian influenza viruses and paramyxoviruses. Eur J Clin Microbiol Infect Dis 2004 ; 23 : 1-6.
[50] Mustaffa-Babjee A, Ibrahim AL, Khim TS. A case of human infection with Newcastle disease virus. Southeast Asian J Trop Med Public Health 1976 ; 7 : 622-4.
[51] Hara J, Fujimoto F, Ishibashi T, et al. Ocular manifestations of the 1976 rubella epidemic in Japan. Am J Ophthalmol 1979 ; 87 : 642-5.
[52] Kato H, Imamura A, Sekiya N, et al. Medical study of cases diagnosed as rubella in adults. Kansenshogaku Zasshi 2013 ; 87 : 603-7.
[53] Niessen F. Embryofoetopahites virales. In : Offret H. Ed. Œil et virus. Paris : Masson ; 2000.
[54] Sebastian MR, Lodha R, Kabra SK. Chikungunya infection in children. Indian J Pediatr 2009 ; 76 : 185-9.
[55] Mahesh G, Giridhar A, Shedbele A, et al. A case of bilateral presumed chikungunya neuroretinitis. Indian J Ophthalmol 2009 ; 57 : 148-50.
[56] Mahendradas P, Avadhani K, Shetty R. Chikungunya and the eye : a review. J Ophthalmic Inflamm Infect 2013 ; 3 : 35.
[57] Mahendradas P, Ranganna SK, Shetty R, et al. Ocular manifestations associated with Chikungunya. Ophthalmology 2008 ; 115 : 287-91.
[58] Lalitha P, Rathinam S, Banushree K, et al. Ocular involvement associated with an epidemic outbreak of chikungunya virus infection. Am J Ophthalmol 2007 ; 144 : 552-6.
[59] Staikowsky F, Talarmin F, Grivard P, et al. Prospective study of Chikungunya virus acute infection in the Island of La Reunion during the 2005-2006 outbreak. PLoS One 2009 ; 4 : e7603.
[60] Couderc T, Gangneux N, Chretien F, et al. Chikungunya virus infection of corneal grafts. J Infect Dis 2012 ; 206 : 851-9.
[61] Daumas RP, Passos SR, Oliveira RV, et al. Clinical and laboratory features that discriminate dengue from other febrile illnesses : a diagnostic accuracy study in Rio de Janeiro, Brazil. BMC Infect Dis 2013 ; 13 : 77.
[62] Chhavi N, Venkatesh C, Soundararajan P, Gunasekaran D. Unusual ocular manifestations of dengue fever in a young girl. Indian J Pediatr 2013 ; 80 : 522-3.
[63] Buchy P, Vo VL, Bui KT, et al. Secondary dengue virus type 4 infections in Vietnam. Southeast Asian J Trop Med Public Health 2005 ; 36 : 178-85.
[64] Noguchi H. Etiology of Yellow Fever : II. Transmission experiments on yellow fever. J Exp Med 1919 ; 29 : 565-84.
[65] Khairallah M, Kahloun R. Ocular manifestations of emerging infectious diseases. Curr Opin Ophthalmol 2013 ; 24 : 574-80.
[66] Jouan A, Philippe B, Riou O, et al. Mild clinical forms of Rift Valley fever during the epidemic in Mauritania. Bull Soc Pathol Exot Filiales 1989 ; 82 : 620-7.
[67] El-Bahnasawy M, Megahed LA, Abdalla Saleh HA, Morsy TA. The Rift Valley fever : could re-emerge in Egypt again ? J Egypt Soc Parasitol 2013 ; 43 : 41-56.
[68] Asnis DS, Conetta R, Teixeira AA, et al. The West Nile Virus outbreak of 1999 in New York : the Flushing Hospital experience. Clin Infect Dis 2000 ; 30 : 413-8.
[69] Asnis DS, Conetta R, Waldman G, Teixeira AA. The West Nile virus encephalitis outbreak in the United States (1999-2000) : from Flushing, New York, to beyond its borders. Ann N Y Acad Sci 2001 ; 951 : 161-71.
[70] Hayes EB. Zika virus outside Africa. Emerg Infect Dis 2009 ; 15 : 1347-50.
[71] Duffy MR, Chen TH, Hancock WT, et al. Zika virus outbreak on Yap Island, Federated States of Micronesia. N Engl J Med 2009 ; 360 : 2536-43.
[72] Kaufman HE. Treatment of viral diseases of the cornea and external eye. Prog Retin Eye Res 2000 ; 19 : 69-85.
[73] Uchio E, Ishiko H, Aoki K, Ohno S. Adenovirus detected by polymerase chain reaction in multidose eyedrop bottles used by patients with adenoviral keratoconjunctivitis. Am J Ophthalmol 2002 ; 134 : 618-9.
[74] Nauheim RC, Romanowski EG, Araullo-Cruz T, et al. Prolonged recoverability of desiccated adenovirus type 19 from various surfaces. Ophthalmology 1990 ; 97 : 1450-3.
[75] Azar MJ, Dhaliwal DK, Bower KS, et al. Possible consequences of shaking hands with your patients with epidemic keratoconjunctivitis. Am J Ophthalmol 1996 ; 121 : 711-2.
[76] Dart JK, El-Amir AN, Maddison T, et al. Identification and control of nosocomial adenovirus keratoconjunctivitis in an ophthalmic department. Br J Ophthalmol 2009 ; 93 : 18-20.
[77] Centers For Disease Control And Prevention (CDC) US. Adenovirus-associated epidemic keratoconjunctivitis outbreaks--four states, 2008-2010. MMWR Morb Mortal Wkly Rep 2013 ; 62 : 637-41.
[78] Renard G. Kérato-conjonctivites à adénovirus. J Fr Ophtalmol 2010 ; 33 : 586-92.
[79] Okumus S, Coskun E, Tatar MG, et al. Cyclosporine a 0.05 % eye drops for the treatment of subepithelial infiltrates after epidemic keratoconjunctivitis. BMC Ophthalmol 2012 ; 12 : 42.
[80] Sambursky R, Trattler W, Tauber S, et al. Sensitivity and specificity of the AdenoPlus test for diagnosing adenoviral conjunctivitis. JAMA Ophthalmol 2013 ; 131 : 17-22.
[81] Gonzalez-Lopez JJ, Morcillo-Laiz R, Munoz-Negrete FJ. Adenoviral keratoconjunctivitis : an update. Arch Soc Esp Oftalmol 2013 ; 88 : 108-15.
[82] Tsagkataki M, Trainor E, Kaye LC, et al. Adenoviral keratoconjunctivitis associated with stromal oedema and keratic precipitates. Clin Experiment Ophthalmol 2013 ; 41 : 715-6.
[83] Chintakuntlawar AV, Chodosh J. Cellular and tissue architecture of conjunctival membranes in epidemic keratoconjunctivitis. Ocul Immunol Inflamm 2010 ; 18 : 341-5.
[84] Hammer LH, Perry HD, Donnenfeld ED, Rahn EK. Symblepharon formation in epidemic keratoconjunctivitis. Cornea 1990 ; 9 : 338-40.
[85] Chang LY, Lu CY, Shao PL, et al. Viral infections associated with Kawasaki disease. J Formos Med Assoc 2014 ; 113 : 148-54.
[86] Kaufman HE. Adenovirus advances : new diagnostic and therapeutic options. Curr Opin Ophthalmol 2011 ; 22 : 290-3.
[87] Dalapathy S, Lily TK, Roy S, Madhavan HN. Development and use of nested polymerase chain reaction (PCR) for the detection of adenovirus from conjunctivitis specimens. J Clin Virol 1998 ; 11 : 77-84.
[88] Asbell PA, De La Pena W, Harms D, et al. Acute hemorrhagic conjunctivitis in Central America : first enterovirus epidemic in the western hemisphere. Ann Ophthalmol 1985 ; 17 : 205-8, 210.
[89] Sattar SA, Dimock KD, Ansari SA, Springthorpe VS. Spread of acute hemorrhagic conjunctivitis due to enterovirus-70 : effect of air temperature and relative humidity on virus survival on fomites. J Med Virol 1988 ; 25 : 289-96.
[90] Wu B, Qi X, Xu K, et al. Genetic characteristics of the coxsackievirus A24 variant causing outbreaks of acute hemorrhagic conjunctivitis in Jiangsu, China, 2010. PLoS One 2014 ; 9 : e86883.
[91] Leveque N, Huguet P, Norder H, Chomel JJ. Enteroviruses responsible for acute hemorrhagic conjunctivitis. Med Mal Infect 2010 ; 40 : 212-8.
[92] Wadia NH, Katrak SM, Misra VP, et al. Polio-like motor paralysis associated with acute hemorrhagic conjunctivitis in an outbreak in 1981 in Bombay, India : clinical and serologic studies. J Infect Dis 1983 ; 147 : 660-8.
[93] Hung TP. A polio-like syndrome in adults following acute hemorrhagic conjunctivitis. Int J Neurol 1981 ; 15 : 266-78.
[94] Marks MI. Coxsackieviruses in human disease. Am Fam Physician 1975 ; 12 : 88-91.
[95] Koroleva GA, Gul’man LA, Lashkevich VA, et al. ECHO-II virus, the pathogen of the third outbreak of uveitis in children in Kransnoyarsk, 1986. Vopr Virusol 1989 ; 34 : 55-65.
[96] Koroleva GA, Lashkevich VA, Savinov AP. Lesions of the vascular tract of the eye (uveitis) caused by enteroviruses in man and monkeys. Vopr Virusol 1984 ; 29 : 447-54.
[97] Xiao Xl, Wu H, Li YJ, et al. Simultaneous detection of enterovirus 70 and coxsackievirus A24 variant by multiplex real-time RT-PCR using an internal control. J Virol Methods 2009 ; 159 : 23-8.
[98] Hayek S, M’Garrech M, Troumiani Y, et al. Carcinome conjonctival épidermoïde invasif révélé après exérèse d’une lésion simulant un ptérygion. In press.
[99] Di Girolamo N. Association of human papilloma virus with pterygia and ocular-surface squamous neoplasia. Eye (Lond) 2012 ; 26 : 202-11.
[100] Piecyk-Sidor M, Polz-Dacewicz M, Zagorski Z, Zarnowski T. Occurrence of human papillomavirus in pterygia. Acta Ophthalmol 2009 ; 87 : 890-5.
[101] Sjo NC, Von BC, Prause JU, et al. Human papillomavirus and pterygium. Is the virus a risk factor ? Br J Ophthalmol 2007 ; 91 : 1016-8.
[102] Sjo NC, Von Buchwald C, Cassonnet P, et al. Human papillomavirus in normal conjunctival tissue and in conjunctival papilloma : types and frequencies in a large series. Br J Ophthalmol 2007 ; 91 : 1014-5.
[103] Saegusa M, Takano Y, Hashimura M, et al. HPV type 16 in conjunctival and junctional papilloma, dysplasia, and squamous cell carcinoma. J Clin Pathol 1995 ; 48 : 1106-10.
[104] Baudouin C. Un nouveau schéma pour mieux comprendre les maladies de la surface oculaire. J Fr Ophtalmol 2007 ; 30 : 239-46.
[105] M’Garrech M, Rousseau A, Kaswin G, et al. Impairment of lacrimal secretion in the unaffected fellow eye of patients with recurrent unilateral herpetic keratitis. Ophthalmology 2013 ; 120 : 1959-67.
[106] Pinheiro SR, Lana-Peixoto MA, Proietti AB, et al. HTLV-I associated uveitis, myelopathy, rheumatoid arthritis and Sjogren’s syndrome. Arq Neuropsiquiatr 1995 ; 53 : 777-81.
[107] Georges-Gobinet A, Moynet D, Hajjar C, et al. HTLV-I associated sicca syndrome in Guadeloupe : lack of relation with a peculiar encoding sequence of surface envelope glycoprotein. Virus Genes 1998 ; 16 : 195-8.
[108] Buggage RR. Ocular manifestations of human T-cell lymphotropic virus type 1 infection. Curr Opin Ophthalmol 2003 ; 14 : 420-5.
[109] Merle H, Cabre P, Olindo S, et al. Ocular lesions in 200 patients infected by the human T-cell lymphotropic virus type 1 in martinique (French West Indies). Am J Ophthalmol 2002 ; 134 : 190-5.
[110] Jacobi C, Wenkel H, Jacobi A, et al. Hepatitis C and ocular surface disease. Am J Ophthalmol 2007 ; 144 : 705-11.
[111] Zegans ME, Anninger W, Chapman C, Gordon SR. Ocular manifestations of hepatitis C virus infection. Curr Opin Ophthalmol 2002 ; 13 : 423-7.
[112] Merayo-Lloves J, Baltatzis S, Foster CS. Epstein-Barr virus dacryoadenitis resulting in keratoconjunctivitis sicca in a child. Am J Ophthalmol 2001 ; 132 : 922-3.
M. Labetoulle, A. Rousseau, M. M’Garrech, G. Kaswin, L. Bonin, E. Barreau, T. Bourcier
Les infections cornéennes et conjonctivales virales liées à herpes simplex virus (HSV) et au virus varicelle–zona (varicella-zoster virus ou VZV) représentent une part importante des pathologies infectieuses du segment antérieur de l’œil. Il convient de réaliser une analyse sémiologique précise des lésions car la prise en charge thérapeutique en dépend. La distinction entre lésions impliquant l’endothélium ou non demeure fondamentale, car elle conditionne le choix du mode d’application des antiviraux et l’utilisation rapide, ou pas, des corticoïdes. Dans le cadre du zona ophtalmique ou de la varicelle, les atteintes cliniques peuvent être très proches des atteintes herpétiques, mais elles peuvent aussi survenir au décours de l’éruption cutanée, plusieurs semaines plus tard, voire en l’absence de tout signe dermatologique. La récidive, la chronicité et la cortico-dépendance sont les principales complications de ces atteintes d’origine zostérienne.
Les infections de la surface oculaire dues à herpes simplex virus (HSV) et au virus varicelle–zona (varicella-zoster virus ou VZV) sont un motif fréquent de consultation dans les cabinets d’ophtalmologie. Si certaines formes cliniques sont particulièrement évocatrices, d’autres peuvent prendre des aspects plus difficiles à reconnaître. Pour autant, la rapidité de la prise en charge diagnostique et donc thérapeutique reste le meilleur atout pour conserver une bonne acuité visuelle. L’enjeu est de taille, car les kératites herpétiques restent la première cause de malvoyance acquise d’origine infectieuse dans les pays occidentaux.
Pour les infections herpétiques de la surface oculaire, c’est surtout le type 1 d’herpes simplex virus (HSV-1) qui est responsable des atteintes cliniques de l’adulte et de l’enfant, le type 2 (HSV-2) étant presque uniquement rencontré dans les infections néonatales, lors d’un accouchement par voie basse dans un contexte d’infection génitale active chez la parturiante. Ces infections maternofœtales sont rares, moins de cinq cas pour 10 000 grossesses [1]. Les lésions oculaires peuvent être minimes (conjonctivite, kératite ponctuée superficielle) ou plus sévères [2]. Le risque immédiat une atteinte neurologique centrale (méningo-encéphalite) associée, qui apparaît environ 7 jours après la naissance, et le risque à plus long terme est de faire le lit d’une réactivation plus tardive, au début de la vie adulte, sous la forme d’une rétinite nécrosante, éventuellement bilatérale [3].
La primo-infection par HSV-1 est asymptomatique dans la presque totalité des cas : 94 % d’après Liesegang et al. [4]. Les quelques primo-infections cliniquement symptomatiques (soit 6 % des cas) surviennent presque exclusivement dans la sphère oropharyngée [4, 5]. La primo-infection oculaire par HSV-1 est donc possible mais rare [6] et ses manifestations typiques (association de blépharite vésiculeuse, kératite et conjonctivite) sont d’ailleurs très proches des herpès récidivants sur ce terrain pédiatrique [7, 8].
L’âge de la primo-infection est plus précoce dans les populations où la promiscuité est importante et les conditions d’hygiène médiocres. Dans les pays occidentaux, il a d’ailleurs tendance à se déplacer de l’enfance à l’adolescence, voire au début de la vie d’adulte [9]. Si l’on se réfère à la présence d’anticorps spécifiques dans le sang, le nombre de personnes infectées par HSV-1 passe de 23 % à 15 ans à 50 % à 30 ans, alors que l’infection à HSV-2 passe de 0,4 % à 22 % [10]. On estime généralement que la séroprévalence de l’infection herpétique augmente ensuite de 10 % par décennie. Ainsi, près de 90 % de la population de plus de 60 ans est porteuse d’anticorps anti-HSV-1, témoins d’une primo-infection survenue antérieurement.
La réplication du virus dans l’épithélium du site de primo-infection (voies oropharyngées surtout) lui permet de pénétrer dans les terminaisons nerveuses, puis de se propager par transport axonal rétrograde dans le système nerveux, jusqu’aux sites où il peut entrer en latence. Pour HSV-1, il s’agit essentiellement du ganglion trigéminé de Gasser, relais des voies nerveuses sensitives de la face [11–13]. Cependant, de nombreux autres relais neurologiques connectés à l’œil peuvent être infectés de façon latente, notamment le ganglion cervical supérieur (relais sympathique), le ganglion ciliaire (relais parasympathique) et les voies hypothalamiques et visuelles (connectées à la rétine) [14].
Il a longtemps été présumé que la prévalence de l’infection latente par HSV-1 dans le système nerveux était proche de la séroprévalence. Des études basées sur l’amplification génique (PCR) ont montré que l’infection latente représente 18 % des sujets âgés de 20 ans et est proche de 100 % chez les sujets de plus de 60 ans, du virus ayant même été retrouvé dans les ganglions trigéminés de patients pourtant séronégatifs pour HSV-1 [4, 15–17]. Toutefois, la présence de quelques copies de génome de HSV-1 dans le ganglion trigéminé ne signifie pas forcément un risque majeur de réactivation virale, car des études expérimentales ont montré que ce risque est corrélé à la charge de virus latent dans les neurones [18]. Si pratiquement tous les sujets de plus de 50 ans peuvent théoriquement réactiver le virus HSV-1, par exemple après une chirurgie oculaire, ce risque semble globalement faible, sauf chez les patients déjà atteints d’herpès oculaire (voir ci-dessous).
Les récidives cliniques sont la conséquence d’une reprise de la réplication virale dans le site de latence, principalement le ganglion trigéminé en ce qui concerne la cornée, la conjonctive et les muqueuses buccales. Selon les études, entre 15 et 45 % de la population générale en France présente régulièrement des épisodes d’herpès labial (bouton de fièvre) [9, 19], et 0,15 % est concernée par l’herpès oculaire [4], ce qui représente tout de même 90 000 Français. Au total, le risque de développer un herpès oculaire au moins une fois dans la vie est estimé aux alentours de 1 % [20].
La réactivation virale peut survenir soit de façon spontanée, soit à la faveur d’une exposition à un facteur déclenchant, qui peut être physique ou biologique. Toute lésion ou agression d’un neurone infecté de façon latente peut déclencher la réactivation virale, via la stimulation de facteurs de transcription [21]. Les actes chirurgicaux et/ou l’exposition de la cornée aux ultraviolets, ou au froid, sont donc parmi les facteurs de réactivation les plus redoutables. Le virus peut aussi profiter de dérèglements métaboliques pour se réactiver. Les prostaglandines (produites lors d’une inflammation ou délivrées sous formes d’analogues en application topique), les alpha-adrénergiques ou encore les corticoïdes (par leur effet promoteur de la synthèse de certains facteurs de transcription) sont les principaux facteurs de risque biologiques d’une réactivation herpétique.
Des données récentes suggèrent qu’un certain nombre d’événements de réactivation virale n’entraînent pas automatiquement une récidive clinique. Ainsi, 1 à 10 % des patients séropositifs pour HSV-1 émettent régulièrement des particules virales dans leur salive. L’étude de Kumar a retrouvé 42 % de résultats positifs sur une série de deux prélèvements salivaires quotidiens pendant 30 jours chez des volontaires sains, 91 % d’entre eux présentant au moins un prélèvement positif sur cette courte période [22]. Dans la même étude, les larmes, prélevées avec la même fréquence, contenaient du génome de HSV-1 dans 49 % des prélèvements, et 93 % des sujets avaient au moins un prélèvement positif sur la période d’étude de 30 jours. Ces quelques chiffres peuvent être rapprochés des 3 à 5 % de cornées de banques de tissus qui contiennent du génome de HSV-1, alors même que les boutons cornéens ont, par définition, été prélevés chez des donneurs dont l’œil était considéré comme sain au moment du décès [23, 24].
Elles sont classiquement le témoin d’un processus de primo-infection. Dans une série de 108 cas, Darougar a retrouvé une blépharite chez 38 % des patients associée, la plupart du temps, à une conjonctivite, alors que 15 % des patients présentaient une atteinte palpébrale avec conjonctivite et kératite [25].
Les atteintes palpébrales herpétiques ne sont pas pour autant pathognomoniques de primo-infection, puisqu’elles peuvent être aussi observées au cours d’un épisode de récurrence, notamment chez l’enfant. Dans ce cadre, elles sont même souvent associées à une conjonctivite et/ou une kératite, y compris dans des formes récurrentes [6–8]. L’étude de Rochester, qui combinait primo-infection et récurrences, retrouvait 21 % d’atteintes palpébrales dans les cas d’herpès oculaire, ce qui souligne la fréquence relative de cette atteinte, probablement méconnue dans certaines formes minimes et spontanément résolutives. L’aspect typique est fait de vésicules au sein de plages érythémateuses qui évoluent vers des croûtes sans laisser de cicatrice.
Elles peuvent aussi entrer dans le cadre d’une éruption généralisée chez un patient, constituant alors le tableau classique mais rare de syndrome de Kaposi-Juliusberg [26], dont les poussées peuvent être récurrentes tant que l’origine herpétique n’est pas traitée par des antiviraux oraux à doses préventives.
Le virus HSV-1 est une cause possible, mais rare, de sclérite. Foster et son équipe ont publié deux séries de neuf et trente-cinq cas [27, 28]. Les sclérites étaient essentiellement antérieures, de forme diffuse ou à l’inverse nodulaire. Les atteintes nécrosantes étaient rares, de même que les atteintes bilatérales (20 % des cas). La régression des signes inflammatoires sous traitement antiviral pouvait être longue.
La fréquence réelle des conjonctivites herpétiques est totalement inconnue, mais nombre de spécialistes considèrent qu’elle est sous-évaluée, car ces conjonctivites sont souvent attribuées à tort à d’autres agents infectieux, en raison de leur présentation souvent banale. Pour certains, elles compteraient pour plus de 20 % des conjonctivites aiguës supposées bactériennes [9], et seraient en réalité la forme clinique la plus fréquente des atteintes oculaires liées au virus herpétique, presque exclusivement de type 1 dans cette localisation [6], sauf chez le nouveau-né (HSV de type 2 par contamination d’origine génitale lors de l’accouchement) [1].
La forme clinique la plus fréquente est celle observée dans la plupart des conjonctivites virales, à savoir une conjonctivite folliculaire avec présence d’un ganglion prétragien sensible à la palpation. La guérison est spontanément favorable en quelques jours, voire en 1 à 2 semaines [29]. Certains auteurs ont insisté sur la proximité clinique entre les conjonctivites herpétiques et celles dues à certains sérotypes d’adénovirus, en particulier ceux des groupes 3, 7 et 11. Ces dernières ont cependant tendance à durer plus longtemps et à être fréquemment bilatérales [29]. À l’inverse, les caractéristiques pouvant orienter l’enquête étiologique vers une infection herpétique sont l’unilatéralité de l’atteinte (observée dans 88 % des cas) et, dans la moitié des cas pour certains auteurs [30], une ulcération dendritique ou géographique de l’épithélium conjonctival (fig. 6-24) [31], plus facilement visible après instillation de fluorescéine. On sait cependant que ces caractéristiques peuvent manquer, notamment dans les cas de primo-infection oculaire (mois de 6 % de toutes les primo-infections herpétiques [4]) et/ou chez l’enfant, même s’il s’agit déjà d’un épisode récurent [32]. En réalité, les tableaux cliniques de l’atteinte pédiatrique et de la primo-infection herpétique sont très difficiles à discerner : la conjonctivite est souvent bilatérale et associée à une blépharite vésiculaire, voire une atteinte cornéenne. La fébricule oriente plutôt vers une réelle primo-infection [30], de même qu’une modification du profil sérologique, qui peut toutefois être observé dans 5 % des récurrences, ce qui lui donne peu d’intérêt en pratique courante [9, 33]. Parmi 108 primo-manifestations herpétiques (âge moyen : 25 ans, 7 % d’enfants de moins de 5 ans), Darougar et al. ont retrouvé 85 % de conjonctivites, parfois très modérées, et 38 % de blépharites, en général associées à des lésions cornéennes. Environ 7 % des patients avaient développé une conjonctivite folliculaire isolée et 15 % ont été atteints de blépharo-conjonctivite chronique isolée [25]. Dans l’étude observationnelle sur la population de Rochester, menée entre 1950 et 1982, 21 % des herpès oculaires clairement identifiés comme tels ne présentaient que des lésions palpébrales, les conjonctivites et blépharites étant souvent associées entre elles ou à une kératite (54 % des primo-manifestations herpétiques et 31 % des récurrences) [4]. À l’inverse, les conjonctivites isolées attribuées cliniquement à l’herpès étaient très rares.
Outre la confusion possible avec une banale conjonctivite bactérienne ou adénovirale (surtout avant leur bilatéralisation), les conjonctivites herpétiques peuvent aussi être prises pour des infections chlamydiennes. La présence d’un ganglion prétragien douloureux étant commune à toutes ces causes, le diagnostic différentiel repose sur les prélèvements conjonctivaux (s’ils sont possibles), l’évolution des signes, voire la réponse au traitement antiviral ou antibiotique. La reconnaissance du diagnostic définitif n’est pas anecdotique, car une atteinte herpétique signifie que le patient est susceptible de présenter des réactivations, notamment dans les suites d’une chirurgie oculaire. Malheureusement, les prélèvements biologiques ne sont pas toujours contributifs. Le frottis ou l’empreinte conjonctivale pour analyse en immunofluorescence n’ont qu’une sensibilité de 70 % (mais une spécificité proche de 100 %). Le prélèvement des larmes par le biais d’une bandelette de Schirmer permet aussi une recherche du génome viral par amplification génique (PCR) [34], mais la sensibilité n’est malheureusement pas parfaite, et ces techniques sont difficilement accessibles en dehors des centres hospitalo-universitaires.

Fig. 6-24 Conjonctivite herpétique (concomitante d’une kératite stromale).
L’incidence annuelle des kératites varie entre 12 et 31,5 cas pour 100 000 habitants [4, 20, 35], soit environ 18 000 épisodes par an pour la France.
D’après les diverses études du Herpetic Eye Disease Study Group (HEDS), un premier épisode de kératite herpétique expose à une récidive (en l’absence de traitement préventif) dans 9,6 % des cas à 1 an, 22,9 % à 2 ans, 40 % à 5 ans et 63,2 % à 20 ans [36, 37]. Des chiffres de 22,9 à 33 % à 2 ans, 36 % à 5 ans, et 67 % à 7 ans ont été retrouvés dans d’autres études réalisées en Europe ou aux États-Unis [38–40].
Par ailleurs, la fréquence des récidives augmente avec le nombre de poussées, au moins pour les cinq premiers épisodes [9, 20, 25, 41]. Ainsi, un patient ayant déjà présenté deux épisodes de kératite dans les 12 derniers mois est exposé à un risque de 32 % de nouvelle poussée dans les 12 mois suivants, et même de 44 % si le nombre de kératites dans l’année précédente était de quatre [42]. Sur un suivi de 15 ans, les patients anglais touchés une première fois par l’herpès oculaire présentaient une récidive dans 16 % des cas, entre deux et cinq récidives dans 12,8 % des cas, et plus de six récidives pour 3,7 % des cas [41].
Tous ces chiffres montrent que la maladie herpétique oculaire doit être prise en charge sur le long terme. Les dernières données publiées de l’étude observationnelle de Rochester sur plus de 30 ans montrent que le risque d’acuité visuelle inférieure à moins de 1/10e est de 7 % dans les 10 ans qui suivent le début de la maladie herpétique et de 11 % à 20 ans [20]. Logiquement, les formes les plus sévères sont plus péjoratives pour le pronostic visuel : 58 % des kératites avec endothélite entraînent une acuité visuelle inférieure à 5/10e dans les 5 ans qui suivent [43]. Et surtout, l’absence de traitement préventif est maintenant aussi clairement identifiée comme un facteur de mauvais pronostic : 85 % des patients de Rochester avec une acuité visuelle finale inférieure à 1/10e n’avaient pas reçu de traitement prophylactique récent, et 65 % n’en avaient jamais pris [20].
Les facteurs de risque de récidive herpétique sont :
-
toutes les situations qui favorisent directement la réplication du virus : nous avons précédemment cité les corticoïdes, les prostaglandines, les alpha-adrénergiques, et toutes les sources d’agression des terminaisons neuronales intracornéennes (chirurgie, ultraviolets, froid, etc.) comme des activateurs directs de la réplication virale [44, 45] ;
-
toutes les situations qui diminuent la qualité de la réaction immunitaire antivirale générale (infection intercurrence, cancer, traitements immunosuppresseurs, etc.) ou locale, en particulier un traitement corticoïde local. Les injections de stéroïdes retard sont à cet égard particulièrement à risque chez un patient déjà atteint d’herpès oculaire [46, 47].
Certaines populations à risque d’herpès particulièrement sévère ou rebelle sont désormais identifiées. De façon générale, la gravité et la fréquence de la maladie sont dictées par des facteurs génétiques de l’hôte et du virus, mais ces domaines sont encore relativement peu explorés chez l’homme [11]. On sait cependant que des mutations dans les gènes des protéines interférant dans la réponse à l’interféron favorisent la survenue d’encéphalites herpétiques [48] et qu’il existe aussi un gène de susceptibilité au bouton de fièvre (CSSG1) sur le chromosome 21 [49]. De façon plus précise pour l’herpès oculaire, une étude a montré que certaines souches virales prédisposent au développement de kératites stromales [50].
Les patients opérés de l’œil constituent la population à risque la plus représentative du risque viral, car les gestes chirurgicaux combinent les trois principaux facteurs de risque de réactivation de HSV-1 : stimulation nerveuse, inflammation postopératoire, et corticothérapie locale. La greffe de cornée illustre ces données : des récidives herpétiques surviennent dans 25 % à 1 an et 45 % à 2 ans après le geste si aucune prévention antivirale n’a été mise en place [51], et même chez les patients sans antécédents herpétiques avant la greffe, les kératites herpétiques sont observées entre 4 et 6 fois plus fréquemment après l’intervention que dans la population normale [52–54]. Ces récidives sont aussi des facteurs d’échec de la greffe [55, 56], notamment lors des premiers jours, puisque 33 % des échecs primaires de greffe contiennent de l’ADN de HSV-1 [57], et 22 % de reprises de greffon sont attribuables à une récurrence herpétique [58]. Il s’agit dans la très grande majorité des cas d’une réactivation de HSV-1 dans le site de latence du receveur (c’est-à-dire le ganglion trigéminé) qui conduit ensuite à la réplication du virus dans le greffon [59]. Plus rarement, le greffon peut servir de vecteur au virus [60–63]. D’ailleurs 3 à 5 % des boutons cornéens de banques de tissus contiennent du génome viral [23, 24], mais à l’inverse, la séroconversion d’un patient initialement séronégatif pour HSV-1 et transplanté avec une cornée de donneur séropositif reste un événement exceptionnel [64]. L’échec de greffe par infection herpétique reste donc, en règle générale, dû à une réactivation virale depuis les tissus du receveur.
Les gestes de chirurgie réfractive sont d’autres situations à risque, car ils combinent souvent une découpe de la cornée et l’utilisation de lasers émettant dans l’ultraviolet. De nombreux cas cliniques ont été rapportés, y compris chez des patients indemnes de tout antécédent herpétique [65–69]. Le risque est pourtant globalement faible, estimé à environ un cas toutes les 1 000 procédures, mais la fréquence des événements chez les patients déjà herpétiques n’est pas encore évaluée [70].
Toutes les autres chirurgies du segment antérieur peuvent favoriser une récidive herpétique, mais avec une fréquence nettement moindre que dans les greffes de cornée. Des cas ont été rapportés après iridotomie périphérique au laser argon [71] ou YAG [72], après trabéculoplastie [73] et, bien entendu, après phako-exérèse. Le délai de récidive virale peut alors varier de quelques jours à 5 semaines après la chirurgie de la cataracte [74, 75].
Les enfants sont rarement l’objet d’infection herpétique oculaire, mais il s’agit alors de cas volontiers rebelles, avec des atteintes plus souvent stromales que chez l’adulte (60 à 80 % des cas versus 30 % chez l’adulte), plus récidivantes (45 % à 15 mois versus 30 % à 24 mois chez l’adulte) et plus souvent bilatérales (61 à 86 % versus moins de 5 % chez l’adulte) [7, 8, 76–80].
Les patients atopiques atteints par un herpès cornéen présentent volontiers des formes stromales nécrotiques [81–83], probablement consécutives à une dysrégulation de la réponse antivirale liée à la maladie allergique et/ou aux traitements stéroïdes fréquents dans cette situation.
Les patients diabétiques semblent 2 fois plus souvent atteints par l’herpès et par ses récidives que la population générale, d’après une étude épidémiologique et rétrospective, sur données de registre [84].
En revanche, les études épidémiologiques n’ont pas mis en évidence de déséquilibre de fréquence entre les deux sexes, ni selon les saisons ou le port de lentilles [59, 85]. De façon surprenante, les patients infectés par le VIH ne développent pas de formes particulières d’herpès oculaire, mais celui-ci est cependant plus fréquent et récidivant [9, 86], sans compter la possibilité de croissance de souches très résistantes aux antiviraux [87], alors que cette situation est exceptionnelle dans la population générale.
On distingue classiquement trois types élémentaires de kératites herpétiques : épithéliales, stromales et endothéliales, souvent associées entre elles. Ces atteintes liées directement à une infection provoquée par HSV-1 doivent être distinguées des kératites neurotrophiques (appelées autrefois méta-herpétiques), qui sont la conséquence de la destruction des terminaisons nerveuses cornéennes par le virus de l’herpès (ou du virus varicelle–zona).
Les caractéristiques cliniques des différentes formes de kératite herpétique sont détaillées dans les tableaux 6-7 à 6-9, et les principaux diagnostics différentiels sont résumés dans les tableaux 6-10 et 6-11.
Une caractéristique commune est l’unilatéralité de l’atteinte, observée chez plus de 95 % des patients touchés par l’herpès cornéen [59]. On note aussi que toutes les kératites herpétiques s’accompagnent d’une perte globale de la sensibilité cornéenne, alors que ce déficit sensitif n’est observé qu’en regard des lésions dans la plupart des autres causes de kératite infectieuse [6].
La différence entre les formes cliniques est liée à leur pathogénie. Les kératites épithéliales sont la conséquence presque exclusive de la réplication virale dans l’épithélium (fig. 6-25 à 6-27), de même que les kératites stromales nécrotiques (fig. 6-28) traduisent une réplication virale massive dans le stroma. Ces deux types d’atteintes sont une contre-indication à l’instillation de corticoïdes et engendrent des douleurs et des signes inflammatoires aigus marqués, avec cercle périkératique et photophobie.
À l’inverse, les kératites stromales non nécrotiques (fig. 6-29) et les endothélites (fig. 6-30 et 6-31) traduisent un conflit immunitaire en réponse à la réplication du virus. Les kératites stromales non nécrosantes font ainsi à la fois intervenir des réactions de type antigène–anticorps–complément (AAC) et une infiltration lymphocytaire spécifique des cellules infectées à l’origine d’anomalies tissulaires éventuellement persistantes [13, 88, 89]. Le même type d’anomalies biologiques a été observé dans les endothélites herpétiques [90, 91]. En clinique, ces phénomènes se traduisent dans les kératites stromales par un anneau immunitaire (similaire à un anneau de Wessely) et dans certaines endothélites par une ligne dite de Khodadoust (fig. 6-32) [92].
Tableau 6-7 Les différentes formes de kératites herpétiques épithéliales.
Tableau 6-8 Les différentes formes de kératites herpétiques stromales.
Tableau 6-9 Les différentes formes de kératites herpétiques endothéliales.
Tableau 6-10 Principaux diagnostics différentiels des kératites herpétiques épithéliales, modifié d’après Labetoulle et al. [152].
Tableau 6-11 Principaux diagnostics différentiels des kératites herpétiques stromales, modifié d’après Labetoulle et al. [152].

Fig. 6-25 Kératite herpétique épithéliale dans sa forme dendritique.

Fig. 6-26 Kératite herpétique épithéliale dans sa forme géographique (sur une cornée greffée).

Fig. 6-27 Kératite herpétique épithéliale dans sa forme limbique (en regard d’une cicatrice de poussée antérieure).

Fig. 6-28 Kératite herpétique stromale dans une forme partiellement nécrotique.
Noter la zone très blanche, dans la partie supérieure de l’opacité.

Fig. 6-29 Kératite herpétique stromale dans sa forme non nécrotique.

Fig. 6-30 Kératite herpétique endothéliale disciforme.
Noter la présence d’un œdème en forme de disque en regard de précipités rétrodescémétiques.

Fig. 6-31 Kératite herpétique endothéliale linéaire.
Noter la ligne de Khodadoust entre zone saine et zone pathologique.

Fig. 6-32 Éruption typique de zona ophtalmique avec blépharite et épisclérite diffuse dans l’œil ipsilatéral.
Il n’y a qu’un seul type de virus varicelle–zona (VZV), mais deux façons pour la surface oculaire d’en être la cible : au moment de la primo-infection (varicelle) ou lors d’une réactivation (zona). On estime que la fréquence des varicelles cliniquement patentes est de l’ordre de 100 000 cas par an en France, mais l’incidence des complications oculaire y est faible. Pour le zona, les chiffres augmentent en raison du vieillissement de la population. Il y aurait environ 200 000 cas par an en France de zona, dont 10 à 20 % touchent le dermatome de la branche V1 du nerf trigéminé, soit entre 20 000 et 40 000 cas [93–95]. Ce chiffre correspond d’ailleurs aux 1 à 4 % de risque de zona ophtalmique pour une vie d’homme, alors que celui de développer un zona, toutes localisations confondues, est de 10 à 15 % [95–97].
Elle survient en général au cours de l’enfance et dans les premières années de la vie d’adulte, surtout par l’intermédiaire des gouttelettes respiratoires de patients eux-mêmes en phase de primo-infection. Même lorsque cette dernière est asymptomatique (en réalité la majorité des cas), le risque de transmettre le virus aux sujets contacts est important, estimé à 90 %. La première rencontre avec le VZV peut aussi être la conséquence d’une contamination par des sujets en période de quiescence clinique apparente mais en phase de sécrétion asymptomatique de VZV [98].
La primo-infection suit plusieurs étapes : infection de la sphère buccopharyngée, puis virémie avant une dernière phase de diffusion dans l’ensemble des tissus nerveux et cutanés, et plus rarement dans les poumons. Cette diffusion est asymptomatique dans plus de 90 % des cas. Dans la minorité des cas où cette primo-infection est patente, elle se caractérise par une répartition des vésicules cutanées sur l’ensemble du corps, dont l’aspect et l’évolution vers des lésions croûteuses sont pathognomoniques de la varicelle. En même temps, le virus atteint de nombreux sites neurologiques, où fort heureusement il entre rapidement en latence plutôt que de se répliquer. Ce n’est cependant pas toujours le cas et le virus peut se répliquer plus qu’à l’habitude. Les principales complications sont pulmonaires, neurologiques (méningite lymphocytaire, encéphalite) et oculaires. Les atteintes peuvent alors être très diverses : uvéites antérieures, sclérokératites, épisclérites, kératites, conjonctivites [99]. De survenue exceptionnelle chez la femme enceinte non préalablement immunisée, la varicelle peut devenir congénitale pour l’enfant porté, avec risques de micromélie, microcéphalie, cicatrices cutanées, syndrome dysautonomique [1].
En l’absence de campagne de vaccination, l’incidence annuelle de la varicelle clinique est estimée entre de 1,3 à 3,4 cas pour 1000 habitants, surtout chez les moins de 20 ans. Mais ces données épidémiologiques et cliniques doivent dorénavant être remises en question dans les pays qui ont fait le choix d’une utilisation massive, voire systématique, du vaccin contre la varicelle. Les enfants vaccinés en bas âge ne font désormais plus de varicelle classique, mais ils peuvent dans quelques rares cas présenter une varicelle vaccinale, beaucoup moins spectaculaire en termes de diffusion et de nombre de lésions cutanées. Des localisations oculaires ont d’ailleurs été décrites [100–102]. À l’inverse, les varicelles graves (avec complications neurologiques ou pulmonaires surtout) ont réduit de 90 % dans les pays utilisant la vaccination [99].
Le VZV, comme le HSV, entre en latence dans le système nerveux après la phase de primo-infection. Les études en biologie moléculaire ont montré que la presque totalité de la population adulte de plus de 50 ans héberge cette infection latente dans les neurones sensitifs des ganglions rachidiens et dans le ganglion trigéminé [14, 15]. À la différence du virus de l’herpès, l’infection latente ne se définit pas comme une extinction totale de toute activité virale puisque certaines protéines continuent d’être traduites [103]. D’ailleurs, il existe des épisodes de réactivation virale infracliniques, rapidement maîtrisés par le système immunitaire. Selon le modèle proposé par Hope-Simpson dans les années 1960, une réactivation clinique (zona) ne serait finalement qu’un de ces multiples épisodes qui n’aurait pas été bloqué par le système immunitaire [104]. Ceci explique le rôle majeur de l’immunosénescence liée à l’âge dans la survenue des zonas [105].
Le zona se traduit par l’apparition de vésicules semblables à celles de la varicelle, mais réparties dans le territoire cutané (dermatome) du ganglion sensitif concerné par la réactivation virale. Comme dans la varicelle, de nouvelles lésions peuvent apparaître durant 1 à 2 semaines [99]. Le zona ophtalmique traduit une réactivation du virus dans la partie V1 du ganglion trigéminé, avec des lésions cutanées sur le scalp, et dans la partie supérieure de la face et l’aile du nez (voir fig. 6-32). Certains patients peuvent développer des formes extensives de zona, touchant plusieurs dermatomes voisins, voire avec des atteintes viscérales en raison d’un nouvel épisode de virémie [99, 106]. Elles sont le plus souvent rencontrées chez les patients dont le système immunitaire est perturbé du fait d’une maladie grave (maladies cancéreuses ou infectieuses intercurrentes, etc.) ou, tout simplement, d’un âge très avancé.
Les atteintes palpébrales sont classiques dans le cadre du zona (voir fig. 6-32). Lors de la phase éruptive, elles peuvent se manifester par la présence de vésicules zostériennes et/ou un gonflement responsable d’un ptosis. Dans les formes très délabrantes, la cicatrisation peut altérer la dynamique palpébrale et entraîner une rétraction avec ectropion ou entropion, ou une lagophtalmie [99, 107, 108]. Les conséquences pour la surface oculaire peuvent être désastreuses, car l’exposition cornéenne est aggravée par l’hypoesthésie cornéenne per- et post-zostérienne, secondaire à l’inflammation des fibres trigéminées en réaction à la réplication virale [109, 110].
Cependant, les atteintes à VZV des paupières ne sont pas l’apanage du zona, elles peuvent aussi se rencontrer après une varicelle [111, 112].
Les atteintes sclérales et épisclérales sont classiques dans le cadre d’une varicelle ou d’un zona, lors de la phase aiguë (voir fig. 6-32), plus fréquemment dans les semaines qui suivent [99, 113], avec une certaine tendance à la chronicité, à la récidive et finalement à la cortico-dépendance [110, 114]. Les formes cliniques sont diverses, mais les atteintes nodulaires sont particulièrement évocatrices, surtout dans leur forme récidivante [115]. Dans le cadre du zona, elles ont souvent tendance à progresser vers le limbe, donnant alors un tableau de sclérokératite avec typiquement une atrophie sclérale au décours [99, 107, 116], voire un tableau plus extensif de scléromalacie [117]. De rares cas de sclérite nécrosante ont aussi été décrits après une varicelle [118]. Enfin, les sclérites peuvent encore prendre une forme postérieure, liée à une inflammation granulomateuse après un zona, avec atteinte périvasculaire et périneurite [99].
Notons enfin que la souche vaccinale OKA, utilisée dans les vaccins contre la varicelle et le zona, a été associée à d’exceptionnels cas de sclérokératite [119].
Elles sont essentiellement observées dans le cadre ou les suites d’une varicelle ou du zona, mais il est probable qu’un certain nombre surviennent en l’absence de tout signe cutané (herpes sine herpete). Les conjonctivites à VZV survenant dans le cadre d’une varicelle sont fréquentes mais discrètes, bien que catarrhales et bilatérales [113, 120]. Une conjonctivite est notée dans 38 % des cas de varicelle avec complication oculaire [111]. L’origine varicelleuse de la conjonctivite ne fait pas de doute lorsque sont observées des phlyctènes limbiques associées aux vésicules cutanées sur les paupières, comme sur l’ensemble du corps, mais cette triade typique n’est pas la plus fréquente. Des uvéites antérieures peuvent être associées aux complications conjonctivales de la varicelle, dans 25 % des cas dans la série de Jordan [112] et 48 % dans celle de Sungur (qui ne prenait en compte que les varicelles avec signes oculaires) [111]. De façon heureusement plus rare, la varicelle peut se compliquer de rétinite nécrosante [121]. En pratique courante, les complications les plus fréquentes de la varicelle, avec ou sans conjonctivite à la phase aiguë, sont l’apparition d’épisodes récurrents de kératite stromale, et/ou d’épisclérite, qui débutent dans les semaines qui suivent la résolution de l’éruption cutanée [113, 122].
Les conjonctivites contemporaines d’un zona ophtalmique signent une atteinte de la branche nasociliaire du nerf trigéminé. L’atteinte homolatérale à l’éruption cutanée peut être folliculaire ou folliculopapillaire, plus ou moins sévère, avec parfois un œdème conjonctival, des vésicules, des fausses membranes. Des pétéchies, voire des hémorragies conjonctivales sont possibles, témoins de l’atteinte vasculaire par le virus. Certains auteurs ont rapporté des formes particulièrement agressives, avec fibrose conjonctivale, symblépharon et atrésie du point lacrymal [6, 116].
Les deux populations à risque de kératite à VZV sont les patients en cours de primo-infection (varicelle) ou en cours de réactivation dans le cadre d’un zona. De façon générale, l’incidence du zona augmente clairement avec l’âge, surtout après 60 ans, passant de 1 cas pour 1000 patients parmi les sujets de 20 à 30 ans à entre 4,50 et 11 cas pour 100 patients dans la population des plus de 70 ans [95, 123]. Un sujet de 85 ans naïf de tout zona est même exposé à un risque de 50 % pendant les dernières années de sa vie [124]. De façon concomitante, le risque de zona augmente franchement chez les patients fortement immunodéprimés, avec un risque global de 25 % contre 2 à 4 % dans la population générale [99, 125]. Il existe à l’inverse des formes apparemment très discrètes, sans manifestations cutanées, qu’on appelle zoster sine herpete [126–128]. Beaucoup de complications oculaires de l’infection à VZV entrent dans ce cadre, notamment les uvéites antérieures isolées, ou dans le cadre d’un syndrome de nécrose rétinienne aiguë [110, 129–131].
Les complications cornéennes de la varicelle sont de même nature que celles rencontrées pendant ou au décours du zona, et sont volontiers associées à d’autres signes inflammatoires du segment antérieur de l’œil (conjonctivite, épisclérite, sclérokératite, uvéite antérieure) [99, 129]. Elles peuvent survenir lors de la phase éruptive, mais apparaissent plus volontiers à distance, entre 2 et 8 semaines après la varicelle. Leur fréquence de survenue est cependant moindre que dans le zona, notamment pour les formes tardives (plaques muqueuses, kératites neurotrophiques). En revanche, elles ont une forte tendance à la récidive et à la cortico-dépendance, comme d’ailleurs les complications des zonas ophtalmiques du sujet jeune [132]. Les risques sont l’amblyopie due aux opacités cornéennes résiduelles ainsi que la cataracte et le glaucome cortico-induits.
Les complications oculaires de zona ophtalmique (herpes zoster ophthalmicus ou HZO) sont fréquentes, jusqu’à 50 % selon certaines études, avec un risque de cicatrice cornéenne résiduelle dans 15 % des cas [107, 108]. L’atteinte cornéenne est même encore plus fréquente chez les patients présentant le signe de Hutchinson (vésicules sur l’aile du nez, traduisant l’atteinte virale de la branche nasociliaire, commune avec la cornée) [133–135]. Il peut s’agir d’une atteinte épithéliale (fig. 6-33) et/ou stromale, dont le principal risque est la survenue d’une kératite neurotrophique au décours (fig. 6-34).
Cependant, des études réalisées en milieu gériatrique ou en médecine de ville ont retrouvé des fréquences plus faibles de complications oculaires, parfois même de moins de 10 % [136]. Sur une étude de cohorte de plus de 7 370 patients touchés par un zona (toutes localisations confondues), 184 présentaient une atteinte oculaire grave (2,5 %), impliquant la cornée dans trois quarts des cas. Une ulcération cornéenne était retrouvée dans 5 % des cas, des opacités résiduelles dans 10 % des cas, et une baisse sévère de l’acuité visuelle dans 3 % des cas. En moyenne, les patients avec une complication oculaire de HZO avaient consulté plus de 10 fois leur médecin, pour des troubles ophtalmiques (dont des douleurs) ayant duré en moyenne 308 jours [137]. On sait d’ailleurs qu’une des principales complications du zona ophtalmique est les douleurs post-zostériennes, dont la fréquence est d’ailleurs supérieure dans cette indication à celle observée dans les autres localisations du zona [138].
Les différents types de kératites dues au virus VZV sont détaillés dans le tableau 6-12.

Fig. 6-33 Kératite épithéliale dendritique dans le cadre d’un zona.
Noter la forme particulière des dendrites, avec peu de branches et pas de bulbe terminal.

Fig. 6-34 Kératite neurotrophique post-zostérienne.
Tableau 6-12 Les différentes formes de kératites associées au zona ophtalmique.
Le diagnostic des kératites virales est essentiellement clinique. La preuve biologique peut cependant être intéressante dans les cas atypiques ou lorsque l’évolution ne répond pas à la thérapeutique de première intention. Les progrès de la biologie moléculaire permettent dorénavant de dépister plusieurs types de virus à partir d’un seul prélèvement, et même de faire des analyses génétiques pour l’identification de gènes de résistance aux traitements.
Compte tenu de la fréquence de la présence d’anticorps anti-HSV, anti-VZV et même anti-CMV dans le sang (la séroprévalence pour ces trois virus est d’au moins 90 % dans la population de plus de 50 ans), leur recherche n’a pas d’intérêt en pratique quotidienne, sauf dans les très rares cas de suspicion de primo-infection avec complication cornéenne. De même, les grattages conjonctivaux et/ou cornéens à des fins d’étude histologique (recherche d’effet cytopathogène ± immunomarquage) ou d’isolement du virus sur des cellules en culture ne sont plus guère utilisés en raison de leur faible rendement [33].
L’amplification génique (PCR) est désormais la technique de référence. Pour la recherche d’infection à HSV, ses index de sensibilité et spécificité sont respectivement de 100 % et 68 % contre 57 % et 87 % pour les colorations histologiques, et 86 % et 85 % pour l’immunofluoresence [139]. Deux types de prélèvements peuvent être testés par PCR : les grattages cornéens et les prélèvements de larmes. Les premiers sont plus difficiles à réaliser mais leur rentabilité est supérieure : 37 % de PCR positive contre 14 % pour les larmes dans une étude comparative sur des cas d’infection sévère [140]. Les techniques de PCR permettent désormais de tester plusieurs agents infectieux à partir d’un seul prélèvement [34]. Elles permettent aussi de quantifier la charge virale. Ainsi, Fukuda et al. ont confirmé que les kératites dendritiques sont le siège d’une réplication importante de HSV-1 à la surface de l’œil (100 % de prélèvements positifs avec en moyenne 6 × 105 copies de génome/ml de larmes), alors qu’elle est moindre dans les kératites stromales non nécrosantes (57 % de prélèvement positifs avec 105 copies/ml) et nulles dans les périodes non actives de kératite stromale et les endothélites [141]. La même équipe a aussi démontré que les déficits épithéliaux persistants, classiquement considérés comme entrant dans le cadre des kératites neurotrophiques, sont en réalité le siège d’une réplication virale dans 89 % des cas [142].
[1] Niessen F. Embryofœtopahites virales. In : Offret H. Ed. Œil et virus. Paris : Masson ; 2000.
[2] Yoser SL, Forster DJ, Rao NA. Systemic viral infections and their retinal and choroidal manifestations. Surv Ophthalmol 1993 ; 37 : 313-52.
[3] Tran TH, Stanescu D, Caspers-Velu L, et al. Clinical characteristics of acute HSV-2 retinal necrosis. Am J Ophthalmol 2004 ; 137 : 872-9.
[4] Liesegang TJ, Melton LJD, Daly PJ, Ilstrup DM. Epidemiology of ocular herpes simplex. Incidence in Rochester, Minn, 1950 through 1982. Arch Ophthalmol 1989 ; 107 : 1155-9.
[5] Umene K, Sakaoka H. Evolution of herpes simplex virus type 1 under herpesviral evolutionary processes. Arch Virol 1999 ; 144 : 637-56.
[6] Colin J. Pathologies de la cornée et de la conjonctive. Atteintes herpétiques. Zona ophtalmique. In : Offret H. Ed. Œil et virus. Paris : Masson ; 2000.
[7] Chong EM, Wilhelmus KR, Matoba AY, et al. Herpes simplex virus keratitis in children. Am J Ophthalmol 2004 ; 138 : 474-5.
[8] Schwartz GS, Holland EJ. Oral acyclovir for the management of herpes simplex virus keratitis in children. Ophthalmology 2000 ; 107 : 278-82.
[9] Liesegang TJ. Herpes simplex virus epidemiology and ocular importance. Cornea 2001 ; 20 : 1-13.
[10] Christenson B, Bottiger M, Svensson A, Jeansson S. A 15-year surveillance study of antibodies to herpes simplex virus types 1 and 2 in a cohort of young girls. J Infect 1992 ; 25 : 147-54.
[11] Kaye S, Choudhary A. Herpes simplex keratitis. Prog Retin Eye Res 2006 ; 25 : 355-80.
[12] Labetoulle M, Maillet S. Modèles animaux d’infection à HSV1 : des outils pour mieux comprendre le neurotropisme et la latence herpétique. Virologie 2004 ; 7 : 425-32.
[13] Hoang-Xuan T. Immunopathologie de l’infection oculaire. Le virus Herpes Simplex. In : Faure JP, Bloch-Michel E, Lehoang P, Vadot E. Eds. Immunopathologie de l’œil. Paris : Masson ; 1988.
[14] Richter ER, Dias JK, Gilbert JE, Atherton SS. Distribution of herpes simplex virus type 1 and varicella zoster virus in ganglia of the human head and neck. J Infect Dis 2009 ; 200 : 1901-6.
[15] Wang K, Lau TY, Morales M, Mont EK, Straus SE. Laser-capture microdissection : refining estimates of the quantity and distribution of latent herpes simplex virus 1 and varicella-zoster virus DNA in human trigeminal Ganglia at the single-cell level. J Virol 2005 ; 79 : 14079-87.
[16] Farooq AV, Shukla D. Herpes simplex epithelial and stromal keratitis : an epidemiologic update. Surv Ophthalmol 2012 ; 57 : 448-62.
[17] Liedtke W, Opalka B, Zimmermann CW, Lignitz E. Age distribution of latent herpes simplex virus 1 and varicella-zoster virus genome in human nervous tissue. J Neurol Sci 1993 ; 116 : 6-11.
[18] Sawtell NM. The probabillity of in vivo reactivation of herpes simplex virus type 1 increases with the number of latently infected neurons in the ganglia. J Virol 1998 ; 72 : 6888-92.
[19] Whitley RJ. Herpes simplex viruses. In : Fields BN, Knipe DM, Howley PM, et al. Eds. Fields Virology. Philadelphia : Raven Publishers ; 2001.
[20] Young RC, Hodge DO, Liesegang TJ, Baratz KH. Incidence, recurrence, and outcomes of herpes simplex virus eye disease in Olmsted County, Minnesota, 1976-2007 : the effect of oral antiviral prophylaxis. Arch Ophthalmol 2010 ; 128 : 1178-83.
[21] Valyi-Nagy T, Deshmane SL, Dillner A, et al. Induction of cellular transcription factors in trigeminal ganglia of mice by corneal scarification, herpes simplex type 1 infection, and explantation of trigeminal ganglia. J Virol 1991 ; 65 : 4142-52.
[22] Kumar M, Hill Jm, Clement C, et al. A double-blind placebo-controlled study to evaluate valacyclovir alone and with aspirin for asymptomatic HSV-1 DNA shedding in human tears and saliva. Invest Ophthalmol Vis Sci 2009 ; 50 : 5601-8.
[23] Van Gelderen BE, Van der Lelij A, Treffers WF, Van der Gaag R. Detection of herpes simplex virus type 1, 2 and varicella zoster virus DNA in recipient corneal buttons. Br J Ophthalmol 2000 ; 84 : 1238-43.
[24] Robert PY, Adenis JP, Denis F, et al. Herpes simplex virus DNA in corneal transplants : prospective study of 38 recipients. J Med Virol 2003 ; 71 : 69-74.
[25] Darougar S, Wishart MS, Viswalingam ND. Epidemiological and clinical features of primary herpes simplex virus ocular infection. Br J Ophthalmol 1985 ; 69 : 2-6.
[26] Colin J, Dhermy P. Les kéatites superficielles herpétiques. In : Pouliquen Y, Colin J, Aymard M, et al. Eds. L’herpès oculaire. Marseille : Lamy ; 1983.
[27] Bhat PV, Jakobiec FA, Kurbanyan K, et al. Chronic herpes simplex scleritis : characterization of 9 cases of an underrecognized clinical entity. Am J Ophthalmol 2009 ; 148 : 779-89.e2.
[28] Gonzalez-Gonzalez LA, Molina-Prat N, Doctor P, et al. Clinical features and presentation of infectious scleritis from herpes viruses : a report of 35 cases. Ophthalmology 2012 ; 119 : 1460-4.
[29] Alvarenga L, Scarpi M, Mannis MJ. Viral conjunctivitis. In : Krachmer JH, Mannis MJ, Holland EJ. Eds. Cornea-Fundamentals, diagnosis and management. Mosby-Elsevier ; 2011.
[30] Colin J, Labetoulle M. Kératites herpétiques, conjonctivites et blépharites : formes cliniques. In : Labetoulle M. Ed. L’herpès et le zona oculaire en pratique : clinique, thérapeutique et prévention. Paris : Med’Com Editions ; 2009.
[31] Dawson CR, Togni B. Herpes simplex eye infections : clinical manifestations, pathogenesis and management. Surv Ophthalmol 1976 ; 21 : 121-35.
[32] Uchio E, Takeuchi S, Itoh N, et al. Clinical and epidemiological features of acute follicular conjunctivitis with special reference to that caused by herpes simplex virus type 1. Br J Ophthalmol 2000 ; 84 : 968-72.
[33] Robert PY. Diagnostic biologique des infections oculaires à virus Herpes simplex. In : Labetoulle M. Ed. L’herpès et le zona oculaire en pratique : clinique, thérapeutique et prévention. Paris : Med’Com Éditions ; 2009.
[34] Robert PY, Traccard I, Adenis JP, et al. Multiplex detection of herpesviruses in tear fluid using the « stair primers » PCR method : prospective study of 93 patients. J Med Virol 2002 ; 66 : 506-11.
[35] Labetoulle M, Auquier P, Conrad H, et al. Incidence of herpes simplex virus keratitis in France. Ophthalmology 2005 ; 112 : 888-95.
[36] Liesegang TJ. Epidemiology of ocular herpes simplex. Natural history in Rochester, Minn, 1950 through 1982. Arch Ophthalmol 1989 ; 107 : 1160-5.
[37] Wilhelmus KR, Coster DJ, Donovan HC, et al. Prognosis indicators of herpetic keratitis. Analysis of a five-year observation period after corneal ulceration. Arch Ophthalmol 1981 ; 99 : 1578-82.
[38] Norn MS. Dendritic (herpetic) keratitis. I. Incidence--seasonal variations--recurrence rate--visual impairment--therapy. Acta Ophthalmol (Copenh) 1970 ; 48 : 91-107.
[39] Ribaric V. The incidence of herpetic keratitis among population. Ophthalmologica 1976 ; 173 : 19-22.
[40] Shuster JJ, Kaufman HE, Nesburn AB. Statistical analysis of the rate of recurrence of herpesvirus ocular epithelial disease. Am J Ophthalmol 1981 ; 91 : 328-31.
[41] Wishart MS, Darougar S, Viswalingam ND. Recurrent herpes simplex virus ocular infection : epidemiological and clinical features. Br J Ophthalmol 1987 ; 71 : 669-72.
[42] The Herpetic Eye Disease Study Group. Acyclovir for the prevention of recurrent herpes simplex virus eye disease. N Engl J Med 1998 ; 339 : 300-6.
[43] Kabra A, Lalitha P, Mahadevan K, et al. Herpes simplex keratitis and visual impairment : a case series. Indian J Ophthalmol 2006 ; 54 : 23-7.
[44] Labetoulle M. Modèles animaux des maladies virales ophtalmolgiques (in vivo). Maladies à HSV et VZV. In : Offret H. Ed. Œil et virus. Paris : Masson ; 2000.
[45] Alm A, Grierson I, Shields MB. Side effects associated with prostaglandin analog therapy. Surv Ophthalmol 2008 ; 53 : S93-105.
[46] Shtein RM, Stahl RM, Saxe SJ, Mian SI. Herpes simplex keratitis after intravitreal triamcinolone acetonide. Cornea 2007 ; 26 : 641-2.
[47] Gulkilik G, Demirci G, Ozdamar AM, Muftuoglu GI. A case of herpetic keratitis after intravitreal triamcinolone injection. Cornea 2007 ; 26 : 1000-1.
[48] Dupuis S, Jouanguy E, Al-Hajjar S, et al. Impaired response to interferon-alpha/beta and lethal viral disease in human STAT1 deficiency. Nat Genet 2003 ; 33 : 388-91.
[49] Kriesel JD, Jones BB, Matsunami N, et al. C21orf91 genotypes correlate with herpes simplex labialis (cold sore) frequency : description of a cold sore susceptibility gene. J Infect Dis 2011 ; 204 : 1654-62.
[50] Umene K, Inoue T, Inoue Y, Shimomura Y. Genotyping of herpes simplex virus type 1 strains isolated from ocular materials of patients with herpetic keratitis. J Med Virol 2003 ; 71 : 75-81.
[51] Lomholt JA, Baggesen K, Ehlers N. Recurrence and rejection rates following corneal transplantation for herpes simplex keratitis. Acta Ophthalmol Scand 1995 ; 73 : 29-32.
[52] Rezende RA, Uchoa UB, Raber IM, et al. New onset of herpes simplex virus epithelial keratitis after penetrating keratoplasty. Am J Ophthalmol 2004 ; 137 : 415-9.
[53] De Kesel RJ, Koppen C, Ieven M, Zeyen T. Primary graft failure caused by herpes simplex virus type 1. Cornea 2001 ; 20 : 187-90.
[54] Remeijer L, Doornenbal P, Geerards AJ, et al. Newly acquired herpes simplex virus keratitis after penetrating keratoplasty. Ophthalmology 1997 ; 104 : 648-52.
[55] Sterk CC, Jager MJ, Swart-vd Berg M. Recurrent herpetic keratitis in penetrating keratoplasty. Doc Ophthalmol 1995 ; 90 : 29-33.
[56] Epstein RJ, Seedor JA, Dreizen NG, et al. Penetrating keratoplasty for herpes simplex keratitis and keratoconus. Allograft rejection and survival. Ophthalmology 1987 ; 94 : 935-44.
[57] Cockerham GC, Bijwaard K, Sheng ZM, et al. Primary graft failure : a clinicopathologic and molecular analysis. Ophthalmology 2000 ; 107 : 2083-90.
[58] Al-Yousuf N, Mavrikakis I, Mavrikakis E, Daya SM. Penetrating keratoplasty : indications over a 10 year period. Br J Ophthalmol 2004 ; 88 : 998-1001.
[59] Labetoulle M, De Monchy I, Offret H. Épidémiologie de la maladie herpétique oculaire. In : Labetoulle M. Ed. L’herpès et le zona oculaire en pratique : clinique, thérapeutique et prévention. Paris : Med’Com Éditions ; 2009.
[60] Cockerham GC, Krafft AE, Mclean IW. Herpes simplex virus in primary graft failure. Arch Ophthalmol 1997 ; 115 : 586-9.
[61] Biswas S, Suresh P, Bonshek RE, et al. Graft failure in human donor corneas due to transmission of herpes simplex virus. Br J Ophthalmol 2000 ; 84 : 701-5.
[62] Thuret G, Acquart S, Gain P, et al. Ultrastructural demonstration of replicative herpes simplex virus type 1 transmission through corneal graft. Transplantation 2004 ; 77 : 325-6.
[63] Robert PY, Adenis JP, Pleyer U. How « safe » is corneal transplantation ? A contribution on the risk of HSV-transmission due to corneal transplantation. Klin Monatsbl Augenheilkd 2005 ; 222 : 870-3.
[64] Robert PY, Adenis JP, Denis F, et al. Surveillance sérologique pour les Herpesvirus chez les receveurs de greffe de cornée. J Fr Ophtalmol 2006 ; 29 : 259-63.
[65] Levy J, Lapid-Gortzak R, Klemperer I, Lifshitz T. Herpes simplex virus keratitis after laser in situ keratomileusis. J Refract Surg 2005 ; 21 : 400-2.
[66] Gomez GS, Pinero Bustamante AM, Gutierrez SE, Pinero BA. Herpes simplex keratitis following laser in situ keratomileusis. Arch Soc Esp Oftalmol 2004 ; 79 : 139-41.
[67] Perry HD, Doshi SJ, Donnenfeld ED, et al. Herpes simplex reactivation following laser in situ keratomileusis and subsequent corneal perforation. CLAO J 2002 ; 28 : 69-71.
[68] Davidorf JM. Herpes simplex keratitis after LASIK. J Refract Surg 1998 ; 14 : 667.
[69] Lu CK, Chen KH, Lee SM, et al. Herpes simplex keratitis following excimer laser application. J Refract Surg 2006 ; 22 : 509-11.
[70] Moshirfar M, Welling JD, Feiz V, et al. Infectious and noninfectious keratitis after laser in situ keratomileusis occurrence, management, and visual outcomes. J Cataract Refract Surg 2007 ; 33 : 474-83.
[71] Gaynor BD, Stamper RL, Cunningham ET, Jr. Presumed activation of herpetic keratouveitis after Argon laser peripheral iridotomy. Am J Ophthalmol 2000 ; 130 : 665-7.
[72] Hou YC, Chen CC, Wang IJ, Hu FR. Recurrent herpetic keratouveitis following YAG laser peripheral iridotomy. Cornea 2004 ; 23 : 641-2.
[73] Reed SY, Shin DH, Birt CM, Rhee RK. Herpes simplex keratitis following argon laser trabeculoplasty. Ophthalmic Surg 1994 ; 25 : 640.
[74] Barequet IS, Wasserzug Y. Herpes simplex keratitis after cataract surgery. Cornea 2007 ; 26 : 615-7.
[75] Miyajima S, Sano Y, Sotozono C, et al. Herpes simplex keratitis after ophthalmic surgery. Nippon Ganka Gakkai Zasshi 2003 ; 107 : 538-42.
[76] Beigi B, Algawi K, Foley-Nolan A, O’Keefe M. Herpes simplex keratitis in children. Br J Ophthalmol 1994 ; 78 : 458-60.
[77] Beneish RG, Williams FR, Polomeno RC, Flanders ME. Herpes simplex keratitis and amblyopia. J Pediatr Ophthalmol Strabismus 1987 ; 24 : 94-6.
[78] Colin J, Le Grignou M, Le Grignou A, et al. L’herpès oculaire de l’enfant. Ophthalmologica 1982 ; 184 : 1-5.
[79] Poirier RH. Herpetic ocular infections of childhood. Arch Ophthalmol 1980 ; 98 : 704-6.
[80] Liu S, Pavan-Langston D, Colby KA. Pediatric herpes simplex of the anterior segment : characteristics, treatment, and outcomes. Ophthalmology 2012 ; 119 : 2003-8.
[81] Prabriputaloong T, Margolis TP, Lietman TM, et al. Atopic disease and herpes simplex eye disease : a population-based case-control study. Am J Ophthalmol 2006 ; 142 : 745-9.
[82] Rezende RA, Hammersmith K, Bisol T, et al. Comparative study of ocular herpes simplex virus in patients with and without self-reported atopy. Am J Ophthalmol 2006 ; 141 : 1120-5.
[83] Rezende RA, Bisol T, Hammersmith K, et al. Epithelial herpetic simplex keratitis recurrence and graft survival after corneal transplantation in patients with and without atopy. Am J Ophthalmol 2007 ; 143 : 623-8.
[84] Kaiserman I, Kaiserman N, Nakar S, Vinker S. Herpetic eye disease in diabetic patients. Ophthalmology 2005 ; 112 : 2184-8.
[85] Brandt BM, Mandleblatt J, Asbell PA. Risk factors for herpes simplex-induced keratitis : a case-control study. Ann Ophthalmol 1994 ; 26 : 12-6.
[86] Hodge WG, Margolis TP. Herpes simplex virus keratitis among patients who are positive or negative for human immunodeficiency virus : an epidemiologic study. Ophthalmology 1997 ; 104 : 120-4.
[87] Bodaghi B, Mougin C, Michelson S, et al. Acyclovir-resistant bilateral keratitis associated with mutations in the HSV-1 thymidine kinase gene. Exp Eye Res 2000 ; 71 : 353-9.
[88] Dawson C, Togni B, Moore TE, Jr. Structural changes in chronic herpetic keratitis. Studied by light and electron microscopy. Arch Ophthalmol 1968 ; 79 : 740-7.
[89] Liesegang TJ. Classification of herpes simplex virus keratitis and anterior uveitis. Cornea 1999 ; 18 : 127-43.
[90] O’Brien WJ, Guy J, Taylor JL. Pathogenesis of corneal oedema associated with herpetic eye disease. Br J Ophthalmol 1990 ; 74 : 723-30.
[91] Holland EJ, Schwartz GS. Classification of herpes simplex virus keratitis. Cornea 1999 ; 18 : 144-54.
[92] Khodadoust AA, Attarzadeh A. Presumed autoimmune corneal endotheliopathy. Am J Ophthalmol 1982 ; 93 : 718-22.
[93] Labetoulle M, Colin J. Zona ophtalmique. In : Bourcier T, Bodaghi B, Bron A. Eds. Les infections oculaires. Paris : Lamy ; 2010.
[94] Gnann JW, Jr., Whitley RJ. Clinical practice. Herpes zoster. N Engl J Med 2002 ; 347 : 340-6.
[95] Ragozzino MW, Melton LJ, III, Kurland LT, et al. Population-based study of herpes zoster and its sequelae. Medicine (Baltimore) 1982 ; 61 : 310-6.
[96] Liesegang TJ. Herpes zoster virus infection. Curr Opin Ophthalmol 2004 ; 15 : 531-6.
[97] Pavan-Langston D. Herpes zoster antivirals and pain management. Ophthalmology 2008 ; 115 : S13-S20.
[98] Nagel MA, Choe A, Cohrs RJ, et al. Persistence of varicella zoster virus DNA in saliva after herpes zoster. J Infect Dis 2011 ; 204 : 820-4.
[99] Liesegang TJ. Herpes zoster ophthalmicus natural history, risk factors, clinical presentation, and morbidity. Ophthalmology 2008 ; 115 : S3-12.
[100] Gonzales JA, Levison AL, Stewart JM, et al. Retinal necrosis following varicella-zoster vaccination. Arch Ophthalmol 2012 ; 130 : 1355-6.
[101] Khalifa YM, Jacoby RM, Margolis TP. Exacerbation of zoster interstitial keratitis after zoster vaccination in an adult. Arch Ophthalmol 2010 ; 128 : 1079-80.
[102] Nagpal A, Vora R, Margolis TP, Acharya NR. Interstitial keratitis following varicella vaccination. Arch Ophthalmol 2009 ; 127 : 222-3.
[103] Deback C, Agut H. Alphaherpesvirinae II : virus varicelle-zona et mode d’action des anti-viraux. In : Labetoulle M. Ed. Herpès et zona oculaire : de la clinique au traitement. Paris : Med’Com Éditions ; 2009.
[104] Hope-Simpson R. The nature of herpes zoster : a long term study and a new hypothesis. Proc Soc Exp Biol Med 1965 ; 58 : 9.
[105] Attal N, Deback C, Gavazzi G, et al. Functional decline and herpes zoster in older people : an interplay of multiple factors. Submitted 2015.
[106] Arvin A. Aging, immunity, and the varicella-zoster virus. N Engl J Med 2005 ; 352 : 2266-7.
[107] Kaufman SC. Anterior segment complications of herpes zoster ophthalmicus. Ophthalmology 2008 ; 115 : S24-S32.
[108] Abitbol O, Hoang-Xuan T. Zona ophtalmique. In : Labetoulle M. Ed. L’herpès et le zona oculaire en pratique : clinique, thérapeutique et prévention. Paris : Med’Com Éditions ; 2009.
[109] Labetoulle M, Colin J. Zona ophtalmique et atteintes du segment antérieur de l’œil. In : Bourcier T, Bodaghi B, Bron A. Eds. Les infections oculaires. Paris : Lamy ; 2010.
[110] Labetoulle M, Bourcier T. Zona ophtalmique et atteintes du segment antérieur de l’œil. Encycl Méd Chir (Elsevier, Paris). Ophtalmologie, 21-470-D-15. 2012 : p. 1-7.
[111] Sungur G, Hazirolan D, Duran S, et al. effect of clinical severity and eyelid rash on ocular involvement in primary varicella infection. Eur J Ophthalmol 2009 ; 19 : 905-8.
[112] Jordan DR, Noel LP, Clarke WN. Ocular involvement in varicella. Clin Pediatr (Phila) 1984 ; 23 : 434-6.
[113] Ostler HB, Thygeson P. The ocular manifestations of herpes zoster, varicella, infectious mononucleosis, and cytomegalovirus disease. Surv Ophthalmol 1976 ; 21 : 148-59.
[114] Cobo M, Foulks GN, Liesegang T, et al. Observations on the natural history of herpes zoster ophthalmicus. Curr Eye Res 1987 ; 6 : 195-9.
[115] Livir-Rallatos C, El Shabrawi Y, Zatirakis P, et al. Recurrent nodular scleritis associated with varicella zoster virus. Am J Ophthalmol 1998 ; 126 : 594-7.
[116] Liesegang TJ. Corneal complications from herpes zoster ophthalmicus. Ophthalmology 1985 ; 92 : 316-24.
[117] Yoeruek E, Deuter CM, Szurman P, et al. Scleromalacia associated with varicella-zoster virus. Ophthalmologe 2008 ; 105 : 480-4.
[118] Gungor IU, Ariturk N, Beden U, Darka O. Necrotizing scleritis due to varicella zoster infection : a case report. Ocul Immunol Inflamm 2006 ; 14 : 317-9.
[119] Naseri A, Good WV, Cunningham ET, Jr. Herpes zoster virus sclerokeratitis and anterior uveitis in a child following varicella vaccination. Am J Ophthalmol 2003 ; 135 : 415-7.
[120] Pogorzalek N, Labetoulle M. Conjonctivites virales. In : Bourcier T, Bodaghi B, Bron A. Eds. Les infections oculaires. Paris : Lamy ; 2010.
[121] Yoshida M, Hayasaka S, Yamada T, et al. Ocular findings in Japanese patients with varicella-zoster virus infection. Ophthalmologica 2005 ; 219 : 272-5.
[122] Fernandez De Castro LE, Sarraf OA, Hawthorne KM, et al. Ocular manifestations after primary varicella infection. Cornea 2006 ; 25 : 866-7.
[123] Donahue JG, Choo PW, Manson JE, Platt R. The incidence of herpes zoster. Arch Intern Med 1995 ; 155 : 1605-9.
[124] Chapman RS, Cross KW, Fleming DM. The incidence of shingles and its implications for vaccination policy. Vaccine 2003 ; 21 : 2541-7.
[125] Buchbinder SP, Katz MH, Hessol NA, et al. Herpes zoster and human immunodeficiency virus infection. J Infect Dis 1992 ; 166 : 1153-6.
[126] Lewis GW. Zoster sine herpete. Br Med J 1958 ; 2 : 418-21.
[127] Silverstein BE, Chandler D, Neger R, Margolis TP. Disciform keratitis : a case of herpes zoster sine herpete. Am J Ophthalmol 1997 ; 123 : 254-5.
[128] [128. Van der Lelij A, Ooijman FM, Kijlstra A, Rothova A. Anterior uveitis with sectoral iris atrophy in the absence of keratitis : a distinct clinical entity among herpetic eye diseases. Ophthalmology 2000 ; 107 : 1164-70.
[129] De Monchy I, Doan S, Offret H, Labetoulle M. Complications oculaires de la varicelle. In : Labetoulle M. Ed. L’herpès et le zona oculaire en pratique : clinique, thérapeutique et prévention. Paris : Med’Com Éditions ; 2009.
[130] Ducos De Lahitte G, Bodaghi B. Uvéites antérieures à HSV et VZV. In : Labetoulle M. Éd. L’herpès et le zona oculaire en pratique : clinique, thérapeutique et prévention. Paris : Med’Com Éditions ; 2009.
[131] Ducos De Lahitte G, Bodaghi B. Rétinites herpétiques à HSV et VZV, nécrosantes et non-nécrosantes. In : Labetoulle M. Ed. L’herpès et le zona oculaire en pratique : clinique, thérapeutique et prévention. Paris : Med’Com Éditions ; 2009.
[132] Ghaznawi N, Virdi A, Dayan A, et al. Herpes zoster ophthalmicus : comparison of disease in patients 60 years and older versus younger than 60 years. Ophthalmology 2011 ; 118 : 2242-50.
[133] Harding SP, Lipton JR, Wells JC. Natural history of herpes zoster ophthalmicus : predictors of postherpetic neuralgia and ocular involvement. Br J Ophthalmol 1987 ; 71 : 353-8.
[134] Yamada K, Hayasaka S, Yamamoto Y, Setogawa T. Cutaneous eruption with or without ocular complications in patients with herpes zoster involving the trigeminal nerve. Graefes Arch Clin Exp Ophthalmol 1990 ; 228 : 1-4.
[135] Zaal MJ, Volker-Dieben HJ, D’Amaro J. Prognostic value of Hutchinson’s sign in acute herpes zoster ophthalmicus. Graefes Arch Clin Exp Ophthalmol 2003 ; 241 : 187-91.
[136] Chidiac C, Bruxelle J, Daures JP, et al. Characteristics of patients with herpes zoster on presentation to practitioners in France. Clin Infect Dis 2001 ; 33 : 62-9.
[137] Yawn BP, Wollan PC, St Sauver JL, Butterfield LC. Herpes zoster eye complications : rates and trends. Mayo Clin Proc 2013 ; 88 : 562-70.
[138] Rousseau A, Bourcier T, Colin J, Labetoulle M. Herpes zoster ophthalmicus : diagnosis and management. US Ophthalmic Review 2013 ; 6 : 119-24.
[139] Subhan S, Jose RJ, Duggirala A, et al. Diagnosis of herpes simplex virus-1 keratitis : comparison of Giemsa stain, immunofluorescence assay and polymerase chain reaction. Curr Eye Res 2004 ; 29 : 209-13.
[140] Satpathy G, Mishra AK, Tandon R, et al. Evaluation of tear samples for Herpes Simplex Virus 1 (HSV) detection in suspected cases of viral keratitis using PCR assay and conventional laboratory diagnostic tools. Br J Ophthalmol 2011 ; 95 : 415-8.
[141] Fukuda Y, Yamamura J, Uwano T, et al. Regulated transgene delivery by ganciclovir in the brain without physiological alterations by a live attenuated herpes simplex virus vector. Neurosci Res 2003 ; 45 : 233-41.
[142] Fukuda M, Deai T, Higaki S, et al. Presence of a large amount of herpes simplex virus genome in tear fluid of herpetic stromal keratitis and persistent epithelial defect patients. Semin Ophthalmol 2008 ; 23 : 217-20.
[143] Tabery HM. Early epithelial changes in recurrent herpes simplex virus keratitis : a non-contact photomicrographic study in vivo in the human cornea. Acta Ophthalmol Scand 1998 ; 76 : 349-52.
[144] Pavan-Langston D. Diagnosis and management of herpes simplex ocular infection. Int Ophthalmol Clin 1975 ; 15 : 19-35.
[145] McGill J, Williams H, Mckinnon J, et al. Reassessment of idoxuridine therapy of herpetic keratitis. Trans Ophthalmol Soc UK 1974 ; 94 : 542-52.
[146] Whitcher JP, Dawson CR, Hoshiwara I, et al. Herpes simplex keratitis in a developing country. Natural history and treatment of epithelial ulcers in Tunisia. Arch Ophthalmol 1976 ; 94 : 587-92.
[147] Gabison EE, Alfonsi N, Doan S, et al. Archipelago keratitis : a clinical variant of recurrent herpetic keratitis ? Ophthalmology 2007 ; 114 : 2000-5.
[148] Amano S, Oshika T, Kaji Y, et al. Herpes simplex virus in the trabeculum of an eye with corneal endotheliitis. Am J Ophthalmol 1999 ; 127 : 721-2.
[149] Robin JB, Steigner JB, Kaufman HE. Progressive herpetic corneal endotheliitis. Am J Ophthalmol 1985 ; 100 : 336-7.
[150] Ohashi Y, Yamamoto S, Nishida K, et al. Demonstration of herpes simplex virus DNA in idiopathic corneal endotheliopathy. Am J Ophthalmol 1991 ; 112 : 419-23.
[151] Dayan M, McGhee C, Anastas C. Idiopathic sectoral corneal endotheliitis. Aust N Z J Ophthalmol 1996 ; 24 : 357-9.
[152] Labetoulle M, Rousseau A, Bourcier T. Atteintes herpétiques du segment antérieur de l’œil : aspects épidémiologiques, cliniques et diagnostiques. Encycl Méd Chir (Elsevier, Paris). Ophtalmologie. 2014 ; in press.
[153] Kaufman HE. Treatment of viral diseases of the cornea and external eye. Prog Retin Eye Res 2000 ; 19 : 69-85.
[154] Mackie IA. Role of the corneal nerves in destructive disease of the cornea. Trans Ophthalmol Soc UK 1978 ; 98 : 343-7.
[155] Kim JH, Ko MK, Shin JC. Infectivity of basal epithelial cells in herpetic dendritic epithelial keratitis. Korean J Ophthalmol 1997 ; 11 : 84-8.
[156] Starr CE, Pavan-Langston D. Varicella-zoster virus : mechanisms of pathogenicity and corneal disease. Ophthalmol Clin North Am 2002 ; 15 : 7-15, v.
[157] Bourcier T, Semoun O. Kératites métaherpétiques. In : Labetoulle M. Ed. L’herpès et le zona oculaire en pratique : clinique, thérapeutique et prévention. Paris : Med’Com Éditions ; 2009.
T. Bourcier, J. Letsch, A. Sauer, A. Aboubacar, M. Labetoulle, E. Candolfi
La kératite amibienne (KA) est une infection cornéenne rare et grave dont le principal facteur de risque est l’utilisation des lentilles de contact. La KA est une pathologie à la fois infectieuse et immunologique se caractérisant par une évolution longue et douloureuse. Épithéliopathie atypique, kératonévrite radiaire puis atteinte stromale en sont les principales caractéristiques cliniques. Tout herpès cornéen survenant chez un porteur de lentilles de contact est à considérer comme étant une KA jusqu’à preuve du contraire. Celle-ci peut entraîner, malgré un traitement approprié, de très lourdes séquelles visuelles, ce qui rend impératif, comme pour toutes les kératites infectieuses, un diagnostic précoce et un traitement médical (association biguanide–diamidine) et parfois chirurgical adapté. De nouvelles techniques de diagnostic microbiologique (polymerase chain reaction ou PCR) et d’imagerie cornéenne (Heidelberg retina tomograph ou HRT) contribuent depuis quelques années à réaliser cet objectif.
La kératite amibienne (KA) est une infection cornéenne rare et grave dont la description est relativement récente puisque le premier cas a été rapporté au Texas en 1973. Son incidence est croissante depuis lors, allant de pair avec l’utilisation des lentilles de contact, principal facteur de risque dans les pays occidentaux. La KA est une pathologie à la fois infectieuse et immunologique se caractérisant par une évolution longue et douloureuse. L’herpès cornéen est le principal diagnostic différentiel de la KA. Celle-ci peut entraîner, malgré un traitement approprié, de très lourdes séquelles visuelles ce qui rend impératif, comme pour toutes les kératites infectieuses, un diagnostic précoce et un traitement adapté. De nouvelles techniques de diagnostic microbiologique et d’imagerie cornéenne contribuent depuis quelques années à réaliser cet objectif.
Les amibes libres sont des protozoaires pouvant accomplir la totalité de leur cycle dans la nature et ne requérant pas d’hôte. Il existe plusieurs genres d’amibes : les Acanthamœba sont essentiellement responsables de kératites, tandis que les Naegleria, Hartmannella, Vahlkampfia, Sappinia et Balamuthia sont à l’origine de dermatites chez les immunodéprimés, d’encéphalites fatales ou de pneumonies consécutives à des baignades en eau contaminée, et elles n’ont été que très rarement isolées au niveau de la cornée [1]. Les amibes libres sont ubiquitaires, omniprésentes dans l’environnement, dans l’air, la terre et l’eau quelle que soit son origine : eau du robinet (surtout calcaire), eau des piscines, réservoirs, citernes, vase, égouts, systèmes de climatisation et d’humidification, surfaces naturelles (mer, étangs, mares, lacs, rivières, nappes phréatiques, canaux d’irrigation, sources thermales chaudes), eau minérale. Les amibes vivent en symbiose avec les bactéries commensales de la surface oculaire dont elles se nourrissent. On peut en effet les retrouver dans la flore conjonctivale des porteurs de lentilles de contact et, en quantité moindre, chez des sujets non porteurs de lentilles.
Les KA sont généralement contractées par contact direct de l’organisme avec une cornée lésée. La production de protéases, péroxydases, élastases ainsi que la capacité d’adhérer aux cellules épithéliales font partie des facteurs de virulence de l’amibe et semblent plus importantes pour les souches pathogènes [2]. L’activité protéasique des amibes est ainsi responsable de la dégradation des membranes basales, de la cytolyse et de l’apoptose des kératocytes ainsi que de la dissolution du collagène stromal. D’autres facteurs liés à l’hôte tels qu’un déficit de l’immunité humorale (IgG sériques et IgA lacrymales anti-Acanthamœba) et cellulaire (hypersensibilité retardée) ont été évoqués [3].
Depuis quelques années, la nouvelle classification fait désormais intervenir les résultats de l’étude du génome des amibes : 17 génotypes différents ont été identifiés à ce jour. Les génotypes T3, T4, T11, plus rarement T2, T6, T15 ont été isolés dans les cas de KA, mais les souches T4 sont les plus nombreuses dans l’environnement et sont le plus fréquemment isolées au cours des infections humaines (87 à 100 %) [4, 5]. Les Acanthamœba existent sous deux formes : le kyste et le trophozoïte (fig. 6-35). Le trophozoïte constitue la forme réplicative, mobile, responsable de l’invasion des tissus. Le kyste est la forme de résistance. Sa paroi protectrice permet la survie de l’amibe dans des conditions environnementales défavorables, grâce à son extrême résistance aux variations de températures, à la dessiccation, aux agressions chimiques et médicamenteuses, ainsi qu’aux changements de pH. Le passage d’une forme à l’autre est fonction des conditions environnementales (température, humidité, nourriture). Ainsi, lorsque le trophozoïte rencontre des conditions défavorables, il se transforme en kyste et peut survivre jusqu’à 20 ans dans l’environnement. Ce dernier peut par la suite se transformer de nouveau en trophozoïte lorsque les conditions redeviennent favorables [1].

Fig. 6-35 Kyste de 15 à 20 μm (a) et trophozoïte de 15 à 40 μm de diamètre (b) d’Acanthamœba observés au microscope (milieu liquide, grossissement × 1000).
Le premier cas de KA a été décrit en 1973 aux États-Unis [6]. L’incidence de l’infection était très rare jusqu’au milieu des années 1980–1990 aux États-Unis et en Angleterre. La plupart de ces cas n’étaient pas liés au port des lentilles de contact mais à des traumatismes cornéens suivis de contacts aquatiques (inondations). Depuis 1985, l’incidence croissante de la KA s’explique par l’utilisation massive des lentilles de contact souvent délivrées sans contrôle ophtalmologique chez des patients mal informés des règles d’hygiène et des techniques d’entretien. En outre, l’amélioration des techniques de diagnostic microbiologique ainsi qu’une sensibilisation accrue des ophtalmologistes ont permis une meilleure reconnaissance de cette pathologie. Actuellement, les KA représentent environ 1 à 6 % des séries publiées de kératites ou ulcères infectieux [7–9].
Il existe toutefois des disparités géographiques importantes puisque l’incidence de la KA a été estimée à la fin des années 1990 à : 1,36 cas/million d’habitants/an aux États-Unis ; 3,06 cas/million d’habitants/an aux Pays-Bas ; 17 à 21 cas/million d’habitants/an au Royaume-Uni. Ces différences s’expliquent en partie par la présence beaucoup plus fréquente d’amibes dans les installations d’eau (notamment dans l’eau calcaire) des maisons au Royaume-Uni par rapport aux autres pays précédemment cités [10–12]. Des phénomènes régionaux tels que des pluies abondantes, des inondations ont été également à l’origine d’une recrudescence locale de cas aux États-Unis [13]. On constate également des variations saisonnières avec une majorité de cas débutant aux saisons chaudes [14, 15].
Il existe deux facteurs de risque de KA :
-
le port de lentilles de contact : facteur retrouvé dans 83 à 100 % des cas observés dans les pays industrialisés [14, 16, 17]. L’incidence de la KA chez les porteurs de lentilles de contact a été estimée au Royaume-Uni à 1/30 000 par an [18]. Les sujets atteints sont donc le plus souvent des adultes jeunes (34 ans en moyenne dans une série récente) immunocompétents [15]. La distribution homme–femme est identique. Il peut s’agir de lentilles souples, rigides, utilisées à titre optique, esthétique ou thérapeutique. Une mauvaise hygiène d’entretien est fréquente : baignade en piscine, jacuzzi, port nocturne (port continu ou orthokératologie), rinçage des lentilles à l’eau du robinet, utilisation de solutions salines « maison », humidification de la lentille à l’aide de salive, absence de séchage des mains, boîtiers sales. Une augmentation de l’incidence des KA a été observée aux États-Unis (Chicago, Illinois) entre 2004 et 2007. Celle-ci a été reliée à l’utilisation d’un produit d’entretien multifonction pour lentilles de contact désormais retiré du marché [19]. Les amibes peuvent parfois être isolées au niveau des boîtiers des porteurs de lentilles de contact y compris chez des patients asymptomatiques. Les trophozoïtes adhérent aux lentilles neuves ou usagées qui servent de vecteur et les microtraumatismes de l’épithélium cornéen induits par le port des lentilles facilitent l’adhésion du trophozoïte à la surface de la cornée. Il semble par ailleurs que le biofilm produit par certaines bactéries augmente l’adhésivité des amibes à la surface des lentilles et le risque d’infection amibienne ;
-
un traumatisme cornéen : dans 2 à 30 % des cas selon les séries, il existe une notion de traumatisme cornéen avec ou sans corps étranger suivi d’une exposition à une eau souillée, à de la boue, de la terre, de la nourriture pour volaille, des végétaux ou des insectes [20]. Enfin, de très rares cas de KA ont été décrits après kératoplastie transfixiante, chirurgie réfractive, anneaux intracornéens [21] ou crosslinking cornéen [22].
La symptomatologie est généralement unilatérale, seuls quelques rares cas d’infections bilatérales ayant été rapportés [23]. Elle se caractérise après quelques jours d’évolution par une photophobie, une irritation oculaire, un larmoiement, laissant rapidement place à des douleurs oculaires parfois extrêmement importantes qui peuvent paraître disproportionnées par rapport aux lésions cornéennes pourtant limitées à l’épithélium cornéen. Toutefois, ces douleurs ne sont présentes que dans 50 % des cas précoces. La notion de port de lentilles de contact ou de traumatisme cornéen récent est retrouvée à l’interrogatoire et un traitement local antibiotique, corticoïde, antiviral local ou général a souvent déjà été effectué sans succès.
L’encadré 6-3 résume les principales manifestations cliniques de la KA.
L’infection amibienne est marquée par deux phases successives qui se distinguent par leur chronologie et leur sévérité. La phase précoce correspond aux 4 à 6 premières semaines de l’infection et comporte des lésions cornéennes prédominantes au niveau épithélial et sous-épithélial. En l’absence de traitement adapté, le stade tardif (4 à 6 semaines et au-delà) se caractérise par une atteinte cornéenne essentiellement stromale et la survenue de complications non cornéennes. Le principal diagnostic différentiel de la KA est l’herpès cornéen aussi bien au stade précoce (pseudo-dendrite) que tardif (œdème disciforme).
Kératite amibienne précoce
• Kératite ponctuée superficielle
• Irrégularité de la surface épithéliale (lignes ou ulcères, aspect gélatineux)
• Microkystes épithéliaux
• Pseudo-dendrites
• Infiltrats épithéliaux ou sous-épithéliaux diffus ou focaux
• Kératonévrite radiaire
Kératite amibienne tardive
• Ulcération(s) épithéliale(s) persistante(s) ou récurrente(s)
• Infiltrat stromal disciforme
• Anneau immunitaire (infiltrat annulaire)
• Lésions satellites
• Fonte stromale
• Amincissement
• Descemétocèle
• Perforation
• Néovascularisation
• Sclérite
• Uvéite, hypopion
• Cataracte
• Hypertonie
• Hypotonie
• Choroïdite
• Endophtalmie
• Décollement de rétine
• Névrite optique
• Pthyse
Des lésions cornéennes très polymorphes peuvent être observées à la phase précoce ou épithéliale : kératite ponctuée superficielle, kystes ou infiltrats épithéliaux (fig. 6-36 et 6-37), irrégularité et œdème de la surface épithéliale, limbite, pseudo-dendrite (fig. 6-38) mimant volontiers une infection herpétique (ce d’autant qu’on peut constater une diminution de la sensibilité cornéenne à la phase initiale de la KA [24]), ou toute autre cause d’épithéliopathie chez le porteur de lentilles de contact (insuffisance lacrymale, allergie, hypoxie, serrage, kératite toxique). Deux équipes ont montré encore récemment que 66 % et 70 % des KA ont été diagnostiquées et traitées initialement comme un herpès cornéen [15, 17]. Le seul signe pathognomonique de la KA est la kératonévrite radiaire (fig. 6-38 et 6-39) qui est toutefois très inconstante puisque retrouvée dans 15 à 20 % des cas. De fait, le diagnostic de KA est rarement évoqué au tout début de l’infection et les traitements antibiotiques et/ou antiviraux instaurés n’entraînent pas la guérison, mais une succession de périodes de rémission et d’aggravation. Certains antibiotiques tels que la rifamycine, les fluoroquinolones ou encore la polymyxine B sont en effet faiblement amœbicides.
En cas de persistance de l’infection et/ou de traitement mal adapté, la KA atteint progressivement après quelques semaines le stroma cornéen (fig. 6-40 à 6-42). L’atteinte stromale peut prendre la forme d’infiltrats localisés ou diffus, d’un anneau immunitaire accompagné d’une réaction inflammatoire importante et d’un vaste ulcère épithélial, ne posant alors plus guère de problème diagnostique chez un patient hyperalgique. Dans une récente série regroupant 56 cas de KA, le diagnostic était posé au cours du premier mois d’évolution dans 56,9 % des cas, au cours du deuxième mois dans 25,5 % des cas, au-delà du deuxième mois dans 15,7 % des cas [16].
De nombreuses complications cornéennes, sclérales ou intraoculaires peuvent émailler l’évolution d’une infection amibienne chronique et/ou sévère [25, 26].

Fig. 6-36 Kératite amibienne évoluant depuis 2 semaines chez un porteur de lentilles souples hydrophiles.
Aspect irrégulier de l’épithélium cornéen, infiltrats épithéliaux et sous-épithéliaux nummulaires de topographie centrale.

Fig. 6-37 Kératite amibienne évoluant depuis 4 semaines chez un porteur de lentilles rigides perméables au gaz.
Aspect irrégulier de l’épithélium cornéen, infiltrats sous-épithéliaux nummulaires et haze diffus. Douleurs intenses insomniantes.

Fig. 6-38 Kératite amibienne évoluant depuis 3 semaines chez une porteuse de lentilles souples hydrophiles.
Kératonévrites multiples (flèches) et pseudo-dendrite (ovale) pouvant évoquer un herpès cornéen.

Fig. 6-39 Kératite amibienne évoluant depuis 2 semaines chez un porteur de lentilles de contact.
Noter la kératonévrite radiaire (flèches) : celle-ci correspond à l’infiltration des nerfs cornéens par les cellules inflammatoires et explique l’intensité des douleurs oculaires ressenties par le patient. Aspect correspondant en OCT-SD module cornée.

Fig. 6-40 Kératite amibienne avec atteinte stromale chez une porteuse de lentilles souples hydrophiles.
Diagnostic réalisé après 4 mois de traitement antibiotique et antiviral. Noter l’aspect d’anneau immunitaire.

Fig. 6-41 Kératite amibienne évoluée (6 mois). Anneau immunitaire (flèche) et sclérite (étoile).

Fig. 6-42 Kératite amibienne évoluée (18 mois). Amincissement, ectasie et néovascularisation cornéenne.
Le diagnostic de certitude repose sur la mise en évidence de l’amibe au sein de la cornée par grattage cornéen profond en périphérie de la lésion. Celui-ci est effectué par un ophtalmologiste, à la lampe à fente ou au bloc. Le port de gants stériles sans talc est obligatoire. Fluorescéine et anesthésiant doivent être éliminés de la surface oculaire par un lavage abondant des culs-de-sac conjonctivaux au sérum physiologique stérile (effet inhibiteur sur les techniques de PCR) [27]. Le prélèvement doit être effectué avant tout traitement ou après une fenêtre thérapeutique de 24 à 48 heures. L’examen direct est réalisé après étalement mince sur lame et coloration par May-Grünwald-Giemsa (MGG), ce qui autorise une lecture immédiate par microscopie optique (× 200 et × 400) permettant de visualiser les amibes (kystes et trophozoïtes), les cellules cornéennes et les autres pathogènes (bactéries, champignons). Toutefois la sensibilité diagnostique de l’examen direct est variable car elle nécessite une équipe de microbiologie expérimentée et entraînée. L’ensemencement est fait sur gélose non nutritive ou milieu liquide enrichis avec une suspension d’Escherichia coli. La culture est généralement positive après 3 jours d’incubation (jusqu’à 15 à 21 jours en cas de traitement préalable) mais son « rendement » est faible, de l’ordre de 50 à 60 % [16, 28].
La PCR est en revanche extrêmement sensible (sensibilité actuellement proche de 100 %) [1, 29–31]. Elle est positive même en présence d’un seul kyste amibien. Le grattage cornéen pour PCR est effectué à l’aide d’une lame stérile en acier inoxydable, d’un tube stérile ADN et ARN libre. La réponse du laboratoire est relativement rapide (1 à 3 jours) lorsque la recherche est effectuée en routine (fig. 6-43). Des PCR multiplex sont désormais disponibles [32]. Les co-infections ou surinfections notamment bactériennes sont fréquentes chez le porteur de lentilles de contact de sorte que des cultures bactériennes, fongiques et virales doivent être systématiquement effectuées. Le grattage cornéen est également thérapeutique, car il permet de débrider l’épithélium atteint et d’augmenter la pénétration des anti-amibiens.
Le diagnostic microbiologique peut à défaut être réalisé par biopsie cornéenne ou analyse du bouton cornéen prélevé lors d’une greffe de cornée. Le tissu cornéen est coupé et traité par différents colorants (hématoxyline-éosine-safran ou HAS, Grocott, Wright, MGG modifié, periodic acid Schiff ou PAS) qui révèlent la présence de kystes et de cellules inflammatoires (polynucléaires neutrophiles, macrophages) au sein du stroma.
Les amibes doivent être également recherchées au niveau des lentilles, du boîtier ou de la solution d’entretien. Cependant, les résultats sont à interpréter avec prudence dans la mesure où 5 à 14 % des boîtiers des porteurs de lentille asymptomatiques sont contaminés par des kystes d’amibes.

Fig. 6-43 PCR amibes : migration électrophorétique des produits d’amplification PCR dans un gel d’agarose à 2 %.
Produits PCR obtenus avec les amorces JDP (521 pb) et Nelson (229 pb) ; T+ et T− correspondent aux témoins positifs et négatifs ; 1, 2 et 3 correspondent aux produits de PCR d’ADN extraits de grattage cornéen humain. M : marqueur de poids moléculaire d’ADN ; 1 et 2 : réaction PCR négative ; 3 : réaction PCR positive.
La microscopie confocale et le module cornée de l’HRT (Heidelberg retina tomograph) permettent, pour un opérateur entraîné à la technique, d’effectuer un véritable diagnostic in situ en identifiant sur des coupes coronales au niveau de l’épithélium et du stroma cornéen des images rondes ou ovales hyperréflectives de 20 à 30 μm de diamètre (fig. 6-44) [33]. Ces images correspondent vraisemblablement aux différentes formes d’amibes (kystes ou trophozoïtes) présentes au milieu des kératocytes activés du stroma cornéen [34]. Il s’agit d’une technique non invasive permettant un diagnostic rapide et précoce. Toutefois son rendement diagnostique est moindre que celui de la PCR. L’HRT cornéen doit être considéré comme un moyen de dépistage chez les patients suspects. Cet appareil est également utile afin de suivre l’évolution de l’infection sous traitement anti-amibien, notamment en cas de persistance ou de récurrence de l’inflammation cornéenne afin de vérifier la persistance des amibes sous leur forme trophozoïte.

Fig. 6-44 HRT II de la cornée d’une patiente atteinte de KA.
Le plan de coupe est situé 11 μm sous la surface épithéliale cornéenne. On note plusieurs kystes hyperréflectifs situés au sein de l’épithélium cornéen (flèches) dont certains possèdent une double paroi. Leur diamètre est de 20 à 30 μm.
Le traitement de la KA comporte plusieurs objectifs : destruction des trophozoïtes et des kystes d’amibes ; prise en charge de l’inflammation, de la douleur, d’une éventuelle hyper- ou hypotonie oculaire ; cicatrisation cornéenne ; réhabilitation visuelle.
Le traitement anti-amibien doit être actif sur les kystes et les trophozoïtes. Le tableau 6-13 résume l’ensemble des molécules disponibles et détaille leur niveau d’activité sur les trophozoïtes et les kystes [35]. La sensibilité d’une souche d’amibe isolée aux molécules amœbicides peut en effet être évaluée in vitro (détermination de la concentration minimale kysticide ou CMK). Les kystes protégés par leur paroi sont beaucoup plus résistants que les trophozoïtes. Une molécule doit donc être kysticide pour être efficace. L’évaluation de la viabilité des kystes, après contact avec les molécules testées, peut se faire par dénombrement ou PCR quantitative.
In vitro, les biguanides (chlorhexidine, polyhexaméthylène biguanide ou PHMB) ont l’activité antitrophozoïte et kysticide la plus importante de toutes les molécules étudiées. La chlorhexidine 0,02 % et le PHMB 0,02 % sont cliniquement efficaces de façon identique et constituent le traitement de première intention [16, 36, 37]. Ces collyres sont exclusivement fabriqués et délivrés par les pharmacies hospitalières. D’autres molécules telles que la miltefosine, l’acriflavine, le voriconazole ont une activité anti-amibienne in vitro, mais ne sont pas encore employées en clinique [38–41].
La plupart des protocoles anti-amibiens actuels comportent une bithérapie diamidine–biguanide (encadré 6-4) [42].
Seul un traitement local par collyres anti-amibiens est prescrit en cas d’atteinte superficielle. Un traitement général est ajouté en cas d’atteinte cornéenne profonde, de sclérite ou de complications intraoculaires.
Traitement local
1. PHMB 0,02 % ou chlorhexidine 0,02 % :
■ 1 goutte/heure, y compris la nuit, le 1er et le 2e jour
■ puis 1 goutte/heure le jour, du 3e au 5e jour
■ puis 1 goutte toutes les 2 heures, du 6e au 13e jour
■ puis 1 goutte 4 fois/jour, du 14e au 20e jour
■ à poursuivre 2 à 4 mois
2. Hexamidine (Désomédine® 0,1 %) :
■ 1 goutte/heure, y compris la nuit le 1er et le 2e jour
■ puis 1 goutte 4 fois/jour, pendant 2 à 4 mois
Traitement général
Fluconazole (Triflucan®) : 800 mg le premier jour (dose de charge), puis 400 mg/jour pendant 4 à 6 mois
Bilan hépatique avant et pendant le traitement
Il n’existe pas de consensus sur la durée idéale du traitement anti-amibien. Même si le délai de guérison microbiologique a été estimé récemment à 44 jours [43], des récurrences sont possibles en cas d’arrêt précoce. La durée moyenne de traitement est d’environ 2 mois en cas d’atteinte épithéliale et peut se prolonger plusieurs mois en cas d’atteinte cornéenne profonde [42, 44].
Le traitement nécessaire de l’inflammation associée à la KA repose sur les corticoïdes. Cette option thérapeutique est cependant controversée en raison de l’immunosuppression qu’elle induit. Des études in vitro ont montré que la dexaméthasone inhibe la conversion trophozoïte–kyste, accélère la prolifération des trophozoïtes, augmente le nombre d’infiltrats cornéens et la nécrose stromale [45, 46]. Dans une étude clinique rétrospective, Park et al. ont montré que les corticoïdes collyres n’induisaient pas plus d’échecs thérapeutiques [47]. En revanche, la durée moyenne du traitement anti-amibien était plus importante dans le groupe traité par corticoïdes que dans le groupe non traité. Une étude canadienne en 2012 a confirmé que l’instillation de corticoïdes préalablement au traitement anti-infectieux était un facteur de mauvais pronostic de la KA [48]. En pratique clinique, il est donc conseillé de ne pas les utiliser avant 2 semaines de traitement anti-amibien et de ne réserver leur prescription qu’à certaines indications spécifiques : néovascularisation cornéenne, opacités sous-épithéliales persistantes, sclérite, uvéite. Il est également recommandé de continuer les anti-amibiens au moins 1 mois après l’arrêt des corticoïdes en raison du risque de récurrence de l’infection amibienne.
Les hypertonies oculaires secondaires sont à traiter dans la mesure du possible médicalement et pour les cas réfractaires par cyclodestruction au laser diode ou implant de drainage. Une hypotonie oculaire sévère peut être observée.
Les douleurs sont traitées au mieux par la prescription de collyres cycloplégiques, d’antalgiques de niveau II ou III. Certains anti-inflammatoires non stéroïdiens (AINS), notamment le flurbiprofène ou l’ibuprofène, peuvent être prescrits à la dose de 50 à 100 mg/jour avec une bonne efficacité antalgique. Les collyres AINS sont également efficaces mais leur tolérance épithéliale est à surveiller. Dans les cas sévères de sclérokératite, la prescription de prednisone (1 mg/kg/jour) ou d’autres immunosuppresseurs tels que la ciclosporine ou l’azathioprine sont à envisager pour les cas de gravité extrême. Un traitement antidépresseur et le soutien psychologique des patients sont souvent nécessaires dans les cas sévères marqués par une évolution douloureuse et très prolongée [49].
Tableau 6-13 Efficacité in vitro des différents traitements anti-amibiens* [35].
Récemment, le crosslinking cornéen a été présenté comme une option alternative au traitement des kératites infectieuses, et notamment amibiennes, résistantes aux traitements médicaux conventionnels (fontes stromales). Après l’application de riboflavine 0,1 % (B2), une irradiation aux rayons ultraviolets A (370 nm) de 3 mW/cm2 est réalisée pendant 30 minutes. Des résultats préliminaires intéressants ont été rapportés par différentes équipes mais ils concernent de faibles nombres de patients et ne comportent pas de groupes contrôles [50, 51]. Si l’effet stabilisateur du crosslinking sur les fibres de collagène de la cornée infectée est vraisemblable, les données issues de modèles expérimentaux de KA ne démontrent pas d’efficacité anti-infectieuse du traitement, ni sur les trophozoïtes, ni sur les kystes [52–54].
Une greffe de cornée thérapeutique peut être envisagée à chaud en cas d’échec du traitement médical. Les techniques de kératoplastie lamellaire profonde ou de kératoplastie transfixiante (KT) peuvent être employées. Toutefois Kitzmann et al. ont montré que le pourcentage de greffes multiples pour KA était de 55 % en cas de KT thérapeutique à chaud contre 11 % pour les patients opérés à distance de l’infection, à titre optique [55]. Risque de récurrence amibienne, glaucome, retard de cicatrisation, ulcère épithélial chronique, endophtalmie étaient les principales causes d’échec dans le groupe des patients avec KT thérapeutique. En outre, la moyenne des acuités visuelles finales (5/10e contre 8/10e) et les taux de survie du greffon à 1, 5 et 10 ans (37,5 % contre 66 % à 10 ans) étaient significativement meilleurs en cas de greffe optique qu’en cas de greffe thérapeutique. Il paraît donc souhaitable d’éviter un geste sur un œil inflammatoire. Dans tous les cas, la greffe doit être accompagnée d’un traitement anti-amibien, anti-inflammatoire compte tenu du risque de récurrence infectieuse (dans les semaines suivant la greffe) et d’une possible exacerbation de l’inflammation cornéenne. Les gestes associés (phako-exérèse, chirurgie du glaucome) sont fréquents [56].
La greffe de membrane amniotique peut se révéler efficace en cas d’inflammation de la surface oculaire et d’ulcère épithélial persistant [57].
Kératectomie, recouvrement conjonctival, cryoapplication cornéenne, injections latérobulbaires de xylocaïne/chlorpromazine (Largactil®) ont été proposés dans les KA sévères. L’énucléation est parfois nécessaire [25].
Le traitement médical doit être prolongé et adapté à l’évolution clinique des paramètres de surveillance habituels : infection, inflammation, cicatrisation. La réponse au traitement est généralement lente (10–15 jours). Une majoration des signes inflammatoires (œdème stromal, inflammation de chambre antérieure) est d’ailleurs souvent observée 1 semaine après le début du traitement. Cette aggravation clinique est souvent due aux antigènes et toxines produits par la lyse des amibes mortes et peut durer jusqu’à 3 semaines [58]. De même, les kystes du stroma profond peuvent être réactivés vers le 90e jour. La toxicité locale de la chlorhexidine et des diamidines est fréquente, ce qui oblige parfois à diminuer la posologie des collyres plus rapidement que ne le prévoit le protocole. Les retards de cicatrisation épithéliale sont fréquents à la phase post-infectieuse.
Le pronostic de la KA dépend avant tout de la précocité du diagnostic permettant la mise en œuvre du traitement adapté. Il s’est globalement amélioré ces dernières années [59]. La récupération visuelle est beaucoup plus importante pour les formes superficielles épithéliales diagnostiquées et traitées de façon appropriée dans le premier mois d’évolution (> 5/10e pour 90 à 100 % des patients) que pour les formes profondes diagnostiquées au-delà de ce délai (> 5/10e pour 53 % de patients) [60]. Dans la récente série du Wills, les KA avec atteintes épithéliales (pseudo-dendrites, kératonévrites) avaient une acuité visuelle finale supérieure à 6,3/10e dans 89 % des cas, tandis que les patients avec atteinte stromale (anneau) avaient une acuité inférieure à compter les doigts dans 62,5 % des cas [17]. À l’inverse, un délai de diagnostic supérieur à 1 mois par rapport au début de l’infection et/ou une atteinte stromale et/ou une acuité visuelle basse lors de la prise en charge sont reconnus, dans de très nombreuses séries, comme facteurs de mauvais pronostic [7, 15, 44, 61–63]. Une greffe de cornée est nécessaire dans 10 à 35 % des cas de KA [16, 28, 44, 61, 64, 65].
Les KA post-traumatiques semblent associées à un retard diagnostique, à la nécessité de gestes chirurgicaux et à un plus mauvais résultat visuel (> 5/10e pour seulement 56 % de patients) que les KA liées aux lentilles de contact [65].
La KA est probablement la plus sévère de toutes les kératites infectieuses du fait de son caractère douloureux, de son évolution prolongée et des séquelles anatomiques et fonctionnelles qu’elle engendre. Ainsi, la reconnaissance des signes cliniques précoces de KA, comportant une atteinte exclusive de l’épithélium cornéen, est très importante car il s’agit du facteur pronostique essentiel. Pourtant la majorité des cas sont encore diagnostiqués tardivement. C’est pourquoi, le diagnostic de KA doit être suspecté en cas de kératite traumatique ou chez tout porteur de lentilles de contact dont la kératite ne réagit pas complètement au traitement antibiotique empirique. De la même façon, le diagnostic d’herpès cornéen chez un porteur de lentilles de contact, bien que possible d’un point de vue théorique, doit être considéré comme un diagnostic d’élimination ; en d’autres termes tout herpès cornéen survenant chez un porteur de lentilles de contact est une amibe jusqu’à preuve du contraire. Le diagnostic positif de KA repose désormais en 2015, sur un faisceau d’arguments non seulement cliniques mais également sur des examens microbiologiques (PCR Acanthamœba) et morphologiques (microscopie confocale).
[1] Goldschmidt P, Degorge S, Benallaoua D, et al. New tool for the simultaneous detection of 10 different genotypes of Acanthamoeba available from the American Type Culture Collection. Br J Ophthalmol 2009 ; 93 : 1096-100.
[2] Ferreira GA, Magliano AC, Pral EM, Alfieri SC. Elastase secretion in Acanthamoeba polyphaga. Acta Trop 2009 ; 112 : 156-63.
[3] McClellan K, Howard K, Mayhew E, et al. Adaptive immune responses to Acanthamoeba cysts. Exp Eye Res 2002 ; 75 : 285-93.
[4] Yera H, Zamfir O, Bourcier T, et al. The genotypic characterisation of Acanthamoeba isolates from human ocular samples. Br J Ophthalmol 2008 ; 92 : 1139-41.
[5] Kao PM, Hsu BM, Chen NH, et al. Molecular detection and comparison of Acanthamoeba genotypes in different functions of watersheds in Taiwan. Environ Monit Assess 2012 ; 184 : 4335-44.
[6] Jones BR, McGill JI, Steele AD. Recurrent suppurative kerato-uveitis with loss of eye due to infection by Acanthamoeba castellani. Trans Ophthalmol Soc UK 1975 ; 95 : 210-3.
[7] Bharathi JM, Srinivasan M, Ramakrishnan R, et al. A study of the spectrum of Acanthamoeba keratitis : a three-year study at a tertiary eye care referral center in South India. Indian J Ophthalmol 2007 ; 55 : 37-42.
[8] Ibrahim YW, Boase DL, Cree IA. Epidemiologic characteristics, predisposing factors and microbiological profile of infectious corneal ulcers : the Portsmouth corneal ulcer study. Br J Ophthalmol 2009 ; 93 : 1319-24.
[9] Saeed A, D’Arcy F, Stack J, et al. Risk factors, microbiological findings, and clinical outcomes in cases of microbial keratitis admitted to a tertiary referral center in Ireland. Cornea 2009 ; 28 : 285-92.
[10] Kilvington S, Gray T, Dart J, et al. Acanthamoeba keratitis : the role of domestic tap water contamination in the United Kingdom. Invest Ophthalmol Vis Sci 2004 ; 45 : 165-9.
[11] Radford CF, Minassian DC, Dart JK. Acanthamoeba keratitis in England and Wales : incidence, outcome, and risk factors. Br J Ophthalmol 2002 ; 86 : 536-42.
[12] Shoff ME, Joslin CE, Tu EY, et al. Efficacy of contact lens systems against recent clinical and tap water Acanthamoeba isolates. Cornea 2008 ; 27 : 713-9.
[13] Foulks GN. Acanthamoeba keratitis and contact lens wear : static or increasing problem ? Eye Contact Lens 2007, 33 : 412-4 ; discussion 424-5.
[14] McAllum P, Bahar I, Kaiserman I, et al. Temporal and seasonal trends in Acanthamoeba keratitis. Cornea 2009 ; 28 : 7-10.
[15] Chew HF, Yildiz EH, Hammersmith KM, et al. Clinical outcomes and prognostic factors associated with acanthamoeba keratitis. Cornea 2011 ; 30 : 435-41.
[16] Lim N, Goh D, Bunce C, et al. Comparison of polyhexamethylene biguanide and chlorhexidine as monotherapy agents in the treatment of Acanthamoeba keratitis. Am J Ophthalmol 2008 ; 145 : 130-5.
[17] Thebpatiphat N, Hammersmith KM, Rocha FN, et al. Acanthamoeba keratitis : a parasite on the rise. Cornea 2007 ; 26 : 701-6.
[18] Seal DV. Acanthamoeba keratitis update-incidence, molecular epidemiology and new drugs for treatment. Eye 2003 ; 17 : 893-905.
[19] Verani JR, Lorick SA, Yoder JS, et al. National outbreak of Acanthamoeba keratitis associated with use of a contact lens solution, United States. Emerg Infect Dis 2009 ; 15 : 1236-42.
[20] Shi W, Liu M, Gao H, et al. Perioperative treatment and prognostic factors for penetrating keratoplasty in Acanthamoeba keratitis unresponsive to medical treatment. Graefes Arch Clin Exp Ophthalmol 2009 ; 247 : 1383-8.
[21] Slade DS, Johnson JT, Tabin G. Acanthamoeba and fungal keratitis in a woman with a history of Intacs corneal implants. Eye Contact Lens 2008, 34 : 185-7.
[22] Rama P, Di Matteo F, Matuska S, et al. Acanthamoeba keratitis with perforation after corneal crosslinking and bandage contact lens use. J Cataract Refract Surg 2009 ; 35 : 788-91.
[23] Carvalho FR, Foronda AS, Mannis MJ, et al. Twenty years of acanthamoeba keratitis. Cornea 2009 ; 28 : 516-9.
[24] Perry HD, Donnenfeld ED, Foulks GN, et al. Decreased corneal sensation as an initial feature of Acanthamoeba keratitis. Ophthalmology 1995 ; 102 : 1565-8.
[25] Awwad ST, Heilman M, Hogan RN, et al. Severe reactive ischemic posterior segment inflammation in acanthamoeba keratitis : a new potentially blinding syndrome. Ophthalmology 2007 ; 114 : 313-20.
[26] Tomita M, Shimmura S, Tsubota K, Shimazaki J. Dacryoadenitis associated with Acanthamoeba keratitis. Arch Ophthalmol 2006 ; 124 : 1239-42.
[27] Goldschmidt P, Rostane H, Saint-Jean C, et al. Effects of topical anaesthetics and fluorescein on the real-time PCR used for the diagnosis of Herpesviruses and Acanthamoeba keratitis. Br J Ophthalmol 2006 ; 90 : 1354-6.
[28] Bourcier T. ZO, Chaumeil C. Kératites amibiennes. Issy-les-Moulineaux : Elsevier Masson ; 2007.
[29] Boggild AK, Martin DS, Lee TY, et al. Laboratory diagnosis of amoebic keratitis : comparison of four diagnostic methods for different types of clinical specimens. J Clin Microbiol 2009 ; 47 : 1314-8.
[30] Goldschmidt P, Degorge S, Saint-Jean C, et al. Resistance of Acanthamoeba to classic DNA extraction methods used for the diagnosis of corneal infections. Br J Ophthalmol 2008 ; 92 : 112-5.
[31] Yera H, Zamfir O, Bourcier T, et al. Comparison of PCR, microscopic examination and culture for the early diagnosis and characterization of Acanthamoeba isolates from ocular infections. Eur J Clin Microbiol Infect Dis 2007 ; 26 : 221-4.
[32] Maubon D, Dubosson M, Chiquet C, et al. A one-step multiplex PCR for acanthamoeba keratitis diagnosis and quality samples control. Invest Ophthalmol Vis Sci 2012 ; 53 : 2866-72.
[33] Bourcier T, Dupas B, Borderie V, et al. Heidelberg retina tomograph II findings of Acanthamoeba keratitis. Ocul Immunol Inflamm 2005 ; 13 : 487-92.
[34] Rezaei Kanavi M, Naghshgar N, Javadi MA, Sadat Hashemi M. Various confocal scan features of cysts and trophozoites in cases with Acanthamoeba keratitis. Eur J Ophthalmol 2012 ; 22 Suppl 7 : S46-50.
[35] Elder MJ, Kilvington S, Dart JK. A clinicopathologic study of in vitro sensitivity testing and Acanthamoeba keratitis. Invest Ophthalmol Vis Sci 1994 ; 35 : 1059-64.
[36] Larkin DF, Kilvington S, Dart JK. Treatment of Acanthamoeba keratitis with polyhexamethylene biguanide. Ophthalmology 1992 ; 99 : 185-91.
[37] Varga JH, Wolf TC, Jensen HG, et al. Combined treatment of Acanthamoeba keratitis with propamidine, neomycin, and polyhexamethylene biguanide. Am J Ophthalmol 1993 ; 115 : 466-70.
[38] Walochnik J, Obwaller A, Gruber F, et al. Anti-Acanthamoeba efficacy and toxicity of miltefosine in an organotypic skin equivalent. J Antimicrob Chemother 2009 ; 64 : 539-45.
[39] Polat ZA, Karakus G. Cytotoxic effect of acriflavine against clinical isolates of Acanthamoeba spp. Parasitol Res 2012 ; 112 : 259-33.
[40] Kowalski RP, Abdel Aziz S, Romanowski EG, et al. Development of a practical complete-kill assay to evaluate anti-acanthamoeba drugs. JAMA Ophthalmol 2013 ; 131 : 1459-62.
[41] Cabello-Vilchez AM, Martin-Navarro CM, Lopez-Arencibia A, et al. Voriconazole as a first-line treatment against potentially pathogenic Acanthamoeba strains from Peru. Parasitol Res 2014 ; 113 : 755-9.
[42] Oldenburg CE, Acharya NR, Tu EY, et al. Practice patterns and opinions in the treatment of acanthamoeba keratitis. Cornea 2011 ; 30 : 1363-8.
[43] Oldenburg CE, Keenan JD, Cevallos V, et al. Microbiological cure times in acanthamoeba keratitis. Eye (Lond) 2011 ; 25 : 1155-60.
[44] Por YM, Mehta JS, Chua JL, et al. Acanthamoeba keratitis associated with contact lens wear in Singapore. Am J Ophthalmol 2009 ; 148 : 7-12.e2.
[45] McClellan K, Howard K, Niederkorn JY, Alizadeh H. Effect of steroids on Acanthamoeba cysts and trophozoites. Invest Ophthalmol Vis Sci 2001 ; 42 : 2885-93.
[46] John T, Lin J, Sahm D, Rockey JH. Effects of corticosteroids in experimental Acanthamoeba keratitis. Rev Infect Dis 1991 ; 13 : S440-442.
[47] Park DH, Palay DA, Daya SM, et al. The role of topical corticosteroids in the management of Acanthamoeba keratitis. Cornea 1997 ; 16 : 277-83.
[48] Kaiserman I, Bahar I, McAllum P, et al. Prognostic factors in Acanthamoeba keratitis. Can J Ophthalmol 2012 ; 47 : 312-7.
[49] Lee GA, Gray TB, Dart JK, et al. Acanthamoeba sclerokeratitis : treatment with systemic immunosuppression. Ophthalmology 2002 ; 109 : 1178-82.
[50] Muller L, Thiel MA, Kipfer-Kauer AI, Kaufmann C. Corneal cross-linking as supplementary treatment option in melting keratitis : a case series. Klin Monbl Augenheilkd 2012 ; 229 : 411-5.
[51] Khan YA, Kashiwabuchi RT, Martins SA, et al. Riboflavin and ultraviolet light a therapy as an adjuvant treatment for medically refractive Acanthamoeba keratitis : report of 3 cases. Ophthalmology 2011 ; 118 : 324-31.
[52] Kashiwabuchi RT, Carvalho FR, Khan YA, et al. Assessing efficacy of combined riboflavin and UV-A light (365 nm) treatment of Acanthamoeba trophozoites. Invest Ophthalmol Vis Sci 2011 ; 52 : 9333-8.
[53] del Buey MA, Cristobal JA, Casas P, et al. Evaluation of in vitro efficacy of combined riboflavin and ultraviolet a for Acanthamoeba isolates. Am J Ophthalmol 2012 ; 153 : 399-404.
[54] Berra M, Galperin G, Boscaro G, et al. Treatment of Acanthamoeba keratitis by corneal cross-linking. Cornea 2013 ; 32 : 174-8.
[55] Kitzmann AS, Goins KM, Sutphin JE, Wagoner MD. Keratoplasty for treatment of Acanthamoeba keratitis. Ophthalmology 2009 ; 116 : 864-9.
[56] Herz NL, Matoba AY, Wilhelmus KR. Rapidly progressive cataract and iris atrophy during treatment of Acanthamoeba keratitis. Ophthalmology 2008 ; 115 : 866-9.
[57] Bourcier T, Patteau F, Borderie V, et al. Amniotic membrane transplantation for the treatment severe acanthamoeba keratitis. Can J Ophthalmol 2004 ; 39 : 621-31.
[58] Seal D. Treatment of Acanthamoeba keratitis. Expert Rev Anti Infect Ther 2003 ; 1 : 205-8.
[59] Awwad ST, Petroll WM, McCulley JP, Cavanagh HD. Updates in Acanthamoeba keratitis. Eye Contact Lens 2007 ; 33 : 1-8.
[60] Bacon AS, Dart JK, Ficker LA, et al. Acanthamoebakeratitis. The value of early diagnosis. Ophthalmology 1993 ; 100 : 1238-43.
[61] Tu EY, Joslin CE, Sugar J, et al. Prognostic factors affecting visual outcome in Acanthamoeba keratitis. Ophthalmology 2008 ; 115 : 1998-2003.
[62] Bouheraoua N, Gaujoux T, Goldschmidt P, et al. Prognostic factors associated with the need for surgical treatments in Acanthamoeba keratitis. Cornea 2012 ; 32 : 130-6.
[63] Yamazoe K, Yamamoto Y, Shimazaki-Den S, Shimazaki J. Visual outcome in Japanese patients with Acanthamoeba keratitis. Eye (Lond) 2012 ; 26 : 517-22.
[64] Illingworth CD, Cook SD. Acanthamoeba keratitis. Surv Ophthalmol 1998 ; 42 : 493-508.
[65] Radford CF, Lehmann OJ, Dart JK. Acanthamoeba keratitis : multicentre survey in England 1992-6. National Acanthamoeba Keratitis Study Group. Br J Ophthalmol 1998 ; 82 : 1387-92.
T. Bourcier, A. Sauer, V. Letscher-Bru, E. Candolfi, M. Labetoulle
Les kératites fongiques représentent en Europe une cause rare, mais souvent grave, d’infection cornéenne. Traumatismes végétaux, usage de corticoïdes et port de lentilles de contact représentent les principaux facteurs de risque. Le diagnostic clinique doit être évoqué en cas d’abcès cornéen à bords flous irréguliers, en présence d’infiltrat satellites, en cas de résistance à un traitement antibiotique bien conduit ou d’aggravation des lésions secondaires à l’instillation de corticoïdes. Un diagnostic microbiologique à partir du grattage cornéen est essentiel afin de proposer au patient un traitement antifongique adapté. Un geste chirurgical est exceptionnellement nécessaire. Le très mauvais pronostic de ces infections est dû à la virulence des champignons qui infectent souvent des cornées déjà pathologiques mais aussi à des retards diagnostiques.
Les kératites fongiques (ou kératomycoses), cause rare mais grave d’infection cornéenne, ont une incidence constante liée à l’usage intensif des corticoïdes, des immunosuppresseurs et des lentilles de contact. Les champignons responsables sont souvent opportunistes et envahissent des cornées pathologiques, mais des kératomycoses peuvent également survenir sur cornées normales après traumatisme le plus souvent par un végétal. Le très mauvais pronostic de ces infections est dû à la virulence des champignons qui infectent souvent des cornées déjà pathologiques mais aussi à des retards diagnostiques. Néanmoins, les nouveaux traitements antifongiques apparus ces dernières années ont contribué à améliorer sensiblement la prise en charge et le pronostic des kératomycoses.
Les champignons peuvent être classés en champignons filamenteux et en levures (tableau 6-14). Les champignons filamenteux sont des organismes multicellulaires tandis que les levures sont unicellulaires. Un troisième groupe constitué par les champignons dimorphiques (comportant à la fois une phase filamenteuse et une phase de levure) est responsable de mycoses profondes mais rarement de kératites. Plus de 70 espèces de champignons filamenteux et de levures ont été identifiées dans le cadre de kératites fongiques [1]. Les champignons filamenteux impliqués sont ubiquitaires dans l’environnement en étant présents sur les plantes, dans la terre et dans l’air (spores). Les levures sont elles aussi largement répandues dans l’environnement (sol, objets, nourriture). Candida albicans est un saprophyte du tube digestif, de la sphère urogénitale et de la peau. En outre, certains champignons peuvent être isolés dans la flore normale des paupières et de la conjonctive, tout particulièrement chez des personnes travaillant en extérieur dans des conditions de forte chaleur et d’humidité importante.
Les infections dues à des champignons filamenteux surviennent essentiellement sous des climats tropicaux : sud des États-Unis, Amérique centrale, Amérique du Sud, Afrique, Moyen-Orient, Chine, Inde (où les kératomycoses représentent 40 à 80 % des kératites infectieuses), Asie du Sud-Est. Les champignons filamenteux pigmentés (Dematiaceae) sont plus rares que les non pigmentés (Monilaceae).
Les kératomycoses liées à des levures sont, dans la très grande majorité des cas, dues à des Candida ou des Cryptococcus. L’immunodépression locale ou générale constitue le principal facteur de risque. Il n’existe que peu d’influence des facteurs environnementaux. Candida albicans est le plus fréquemment en cause mais d’autres espèces (C. parapsilosis, C. guilliermondii, C. tropicalis, C. krusei) ont été identifiées au niveau de la cornée. Les levures représentent environ 50 à 60 % des kératomycoses observées dans les pays à climat tempéré (Europe, nord des États-Unis) [2–5].
Tableau 6-14 Trois groupes de champignons peuvent être à l’origine de kératomycoses.
* Champignons les plus fréquemment isolés et rapportés dans la littérature.
Bien que l’œil soit continuellement exposé à ces micro-organismes, la surface oculaire constitue normalement une protection efficace. La survenue d’une infection mycotique implique l’altération d’un ou de plusieurs systèmes de défense anti-infectieux de la cornée (barrière épithéliale, film lacrymal, clignement palpébral). La réaction inflammatoire créée par l’infection dépend de la réplication des champignons, des mycotoxines, des enzymes protéolytiques sécrétées et des antigènes fongiques. La réponse de l’hôte s’accompagne généralement du relarguage de cytokines telles que MIP-2, KC, IL-1β, IL-6, dectin-1, TLR-2, TLR-4, TLR-9 et NOD-like receptor protein, IL-8, IL-17, TNF-α par les cellules inflammatoires [6, 7]. Les champignons peuvent pénétrer les lamelles stromales, attaquer la membrane de Descemet, diffuser en chambre antérieure et provoquer une endophtalmie. La formation d’un biofilm est un important facteur de pathogénicité notamment pour le Fusarium [8].
Les corticoïdes et autres agents immunosuppresseurs facilitent le développement des infections mycotiques en inhibant la transcription des cytokines pro-inflammatoires et des chimiokines. Ils diminuent également l’activité anti-infectieuse des macrophages ainsi que la capacité d’adhésion des polynucléaires neutrophiles [9].
Les kératomycoses à champignon filamenteux surviennent fréquemment après un traumatisme cornéen végétal (ou tellurique) concernant une cornée saine. Il peut s’agir d’une plante d’intérieur ou d’extérieur ou d’autres types de végétaux (branches d’arbres, légumes, fruits). Certaines professions comportant des activités extérieures (fermier, agriculteur, pépiniériste) sont donc plus particulièrement concernées, ce qui explique la prépondérance masculine des infections à champignons filamenteux [10]. Il existe également des variations saisonnières, les cas étant plus fréquents au printemps et à l’automne, au moment des récoltes.
Les Candida et autres levures sont des champignons opportunistes qui infectent les surfaces oculaires déjà compromises (immunodépression localisée) par des kératoconjonctivites, atopiques ou sèches, des herpès stromaux (souvent traités par corticoïdes), des pemphigoïdes, des kératites neurotrophiques, des kératites d’exposition.
Des kératites fongiques peuvent occasionnellement se déclarer chez des porteurs de lentilles de contact, notamment avec des lentilles cosmétiques ou d’aphake, pour les champignons filamenteux, lentilles pansement pour les levures. Entre 2004 et 2006, une importante épidémie mondiale de kératites à Fusarium a été reliée au produit d’entretien pour lentilles, Renu Moisture Loc® [11, 12]. Aucun moyen de nettoyage des lentilles ne protège totalement de la contamination fongique des lentilles et du boîtier.
Des cas de kératites fongiques ont été rapportés après chirurgie cornéenne (principalement greffe de cornée mais aussi Lasik, kératotomies, anneaux, crosslinking) ou chirurgie de la cataracte [13].
Certaines causes d’immunodépression systémique peuvent être associées aux kératomycoses : infections à VIH, hémopathies, cancers, endocrinopathies, lupus, déficits en IgA.
L’interrogatoire précise le mode d’apparition de la kératite. Le début est généralement insidieux lorsqu’il s’agit de cornées pathologiques. Les premiers signes se manifestent quelques heures ou jours après le traumatisme ou le port infestant de lentilles de contact, mais peuvent parfois apparaître plus tardivement. La cinétique de l’infection dépend de la virulence du champignon, de la taille de l’inoculum et des résistances de l’hôte. Des facteurs de risque sont généralement relevés : traumatisme cornéen, pathologie chronique ou chirurgie de surface oculaire, port de lentilles de contact, immunodépression systémique, utilisation de corticoïdes. Les traitements déjà administrés au patient seront notés.
Les signes fonctionnels désignent une atteinte cornéenne (douleur, larmoiement, photophobie, blépharospasme) mais sont aspécifiques. La baisse d’acuité visuelle est variable.
L’examen biomicroscopique (fig. 6-45 à 6-49) révèle des signes d’inflammation non spécifiques (hyperhémie conjonctivale, cercle périkératique), et parfois la présence de sécrétions conjonctivales. Au niveau de l’épithélium cornéen, la surface est typiquement « grise », « sale », « rugueuse » et comporte quelques infiltrats. Elle peut également être intacte, surélevée ou occasionnellement ulcérée avec des bords soulevés en regard de l’infiltrat inflammatoire stromal. Ces ulcérations, initialement récurrentes, deviennent permanentes au stade tardif de l’infection. Au niveau du stroma cornéen, il existe un infiltrat à bords irréguliers comportant peu ou pas d’inflammation, ce qui permet parfois de visualiser au fort grossissement les bords des champignons filamenteux et explique l’aspect « duveteux » des bords de l’infiltrat. Des micro-abcès ou lésions satellites peuvent être disséminés dans toute la cornée. Des dépôts de pigments sur le fond d’un ulcère sont parfois observés en cas d’infection par champignons filamenteux pigmentés. L’infection peut prendre l’aspect d’une kératopathie microcristalline (Candida). Un anneau immunitaire de Wessely peut être observé autour de l’infiltrat central. Au niveau de l’endothélium cornéen et en chambre antérieure, l’atteinte est variable : effet Tyndall, hypopion, fibrine, plaque endothéliale, plis de Descemet.
L’évolution des kératomycoses est en général plus lente que celle des kératites bactériennes. Toutefois, les infections à champignons filamenteux (Aspergillus, Fusarium) peuvent évoluer de façon très rapide vers la perforation cornéenne et l’endophtalmie, notamment lorsque des corticoïdes ont été prescrits. À l’inverse, les levures causent souvent de petites ulcérations ovales blanc-jaune superficielles associées à un œdème stromal ressemblant à un abcès à bactérie à Gram positif. Cependant, des infections suppuratives très graves peuvent également se développer lors d’infections à levures.
Les complications évolutives des kératomycoses sont nombreuses à type de fonte stromale, descemétocèle, ectasie ou perforation cornéenne, sclérite, endophtalmie, fonte purulente du globe, cellulite orbitaire.

Fig. 6-45 Kératite à Aspergillus chez un patient porteur de lentilles de contact.
Noter la présence d’infiltrats satellites.

Fig. 6-46 Kératite à Fusarium chez une patiente porteuse de lentilles de contact.
Infiltrat cornéen à bords flous, irréguliers.

Fig. 6-47 Volumineux abcès à Fusarium consécutif à un traumatisme végétal (plante d’intérieur) et instillation de collyre corticoïde.

Fig. 6-48 Abcès à Fusarium chez une patiente traitée par corticoïde topique pour une conjonctivite aiguë.

Fig. 6-49 Abcès à Candida albicans survenu 30 ans après une kératotomie radiaire.
La microscopie confocale in vivo permet parfois de détecter précocement les kératomycoses en visualisant au sein de la cornée des structures linéaires avec embranchements (filamenteux) ou des points ronds hyperréflectifs (levures). Cet examen permet de différencier les champignons des autres micro-organismes (amibes notamment) [14] et de suivre l’efficacité des traitements antimycotiques [15].
La recherche d’un diagnostic de certitude par examen microbiologique est impérative devant toute suspicion clinique de kératomycose compte tenu des implications pronostiques et thérapeutiques. Il repose sur un grattage cornéen profond, réalisé à la lampe à fente au niveau de la base et des berges de l’infiltrat cornéen, si possible avant tout traitement anti-infectieux, et après rinçage de la surface oculaire au NaCl 0,9 % stérile. Le produit de grattage est étalé puis fixé sur lame puis coloré par coloration Gram, MGG (lent) ou Grocott pour examen direct (fig. 6-50). Un milieu de culture fongique avec antibiotique et sans inhibiteurs est ensemencé. Celle-ci est généralement « positive » après 3 à 4 jours, mais certains champignons peuvent nécessiter plusieurs semaines de culture (fig. 6-51). Un milieu de Sabouraud liquide peut être utile si un traitement anti-infectieux a déjà été débuté. L’analyse morphologique et les tests biochimiques permettent l’identification du champignon. Des antifongigrammes peuvent être réalisés. Cependant, l’interprétation des concentrations minimales inhibitrices (CMI) obtenues est difficile, car il existe des différences entre ces tests in vitro et l’efficacité clinique des molécules antifongiques [16]. Le diagnostic mycologique par PCR est encore en cours d’évaluation : sa sensibilité apparaît toutefois intéressante (93 %), notamment lorsque les cultures sont négatives [17–19]. Un examen bactériologique doit être systématiquement pratiqué car il existe 30 % de co-infections bactériennes. La recherche d’amibes et d’herpès est demandée en fonction du contexte clinique.
Le diagnostic de kératomycose peut également être réalisé en anatomopathologie sur biopsie de cornée, lorsque le grattage cornéen n’est pas contributif et l’évolution clinique défavorable, ou encore sur bouton cornéen, en cas de greffe à chaud (fig. 6-52). Les colorations MGG, PAS, HES et Grocott sont les plus contributives.

Fig. 6-50 Grattage cornéen, examen direct coloré au Gram : nombreux filaments mycéliens septés parmi les cellules épithéliales. Grossissement × 100.
La culture de ce prélèvement a permis l’identification de Fusarium proliferatum.
Fig. 6-51 Grattage cornéen, isolement de Fusarium proliferatum après culture de 7 jours sur milieu chromID Candida.

Fig. 6-52 Bouton cornéen.
Coloration de Gomori, grossissement × 20. De multiples particules mycotiques (noires) sont disséminées au sein de la cornée.
Le tableau 6-15 récapitule les principaux agents antifongiques actuellement disponibles.
L’expérience la plus importante en ophtalmologie concerne les polyènes plus que les azolés dont l’efficacité a été démontrée in vitro et sur de petites séries cliniques [20]. L’association de polyènes et d’azolés semble synergique in vitro. Les polyènes et azolés attaquent la membrane cellulaire (stérols) tandis que la 5-fluorocytosine interfère avec la synthèse protéique et les échinocandines inhibent la synthèse de la paroi des champignons.
Aucun collyre antifongique n’est disponible en pharmacie d’officine en France. À l’exception de la natamycine, les collyres sont préparés par les pharmacies hospitalières à partir de solutions ou de poudres d’antimycotiques destinées à l’usage systémique.
L’amphotéricine B (Fungizone®) a in vitro une activité antifongique large contre les levures, variable sur les filaments : Aspergillus régulièrement sensible, Fusarium de sensibilité inconstante. L’usage de l’amphotéricine B par voie intraveineuse est à éviter en raison d’une importante toxicité systémique (rénale) et d’une faible pénétration intraoculaire. L’utilisation de la suspension buvable est inutile, car celle-ci n’est pas absorbée par le tube digestif. Sous forme de collyre, l’amphotéricine B est peu soluble, instable, ce qui lui confère une faible capacité de pénétration cornéenne et provoque de nombreux effets indésirables (kératite ponctuée superficielle, retard de cicatrisation épithéliale, chémosis, coloration jaune-vert de la cornée et de la conjonctive). Néanmoins, le collyre amphotéricine B à 0,15 ou 0,25 % (1,5 à 2,5 mg/ml) représente le meilleur compromis efficacité/tolérance. Il est exclusivement fabriqué par les pharmacies hospitalières et se conserve 15 jours au réfrigérateur dans un flacon opaque. L’Ambisome® (amphotéricine B liposomale) collyre est mieux toléré mais onéreux.
La natamycine est active in vitro vis-à-vis des champignons filamenteux (Aspergillus, Acremonium, Fusarium, Penicillium) ainsi que sur certaines levures [21]. Elle est disponible aux États-Unis sous forme de suspension à 5 % (Pimaricin®). Elle peut être obtenue en France dans le cadre d’une procédure d’autorisation temporaire d’utilisation (ATU). Ce collyre est stable et relativement peu toxique pour la cornée et la surface oculaire ; ses principaux effets indésirables sont une hyperhémie conjonctivale, des follicules, des ulcérations épithéliales.
Le groupe des azolés comporte les imidazolés qui sont peu solubles, peu efficaces et relativement toxiques. Ils sont actuellement supplantés par les triazolés, moins toxiques et dont le spectre est plus large. Ces derniers ont en outre une bonne biodisponibilité systémique et diffusent bien dans la cornée après administration orale. Ils sont efficaces sur les champignons filamenteux (itraconazole – Sporanox®, voriconazole – Vfend®) et les levures (fluconazole – Triflucan®). Itraconazole et fluconazole sont disponibles sous forme de collyres à respectivement 1 % et 0,3 %, préparés par les pharmacies hospitalières. Le voriconazole (Vfend®) a un spectre étendu à Aspergillus, Scedosporium et Fusarium. Candida krusei (résistant au fluconazole) y est habituellement sensible mais des résistances croisées avec le fluconazole sont possibles pour toutes les espèces, particulièrement Candida glabrata. Il peut être administré par voie orale (biodisponibilité excellente) ou intraveineuse. Un collyre est disponible dans certaines pharmacies hospitalières à la concentration de 10 mg/ml (1 %) [22, 23]. Des injections intrastromales de voriconazole (50 μg/0,1 ml) ou intracamérulaires (100 μg) ont été proposées en cas de kératomycoses résistantes [24, 25] ou compliquées d’endophtalmie [26].
La caspofungine (Cancidas®) est active sur les Aspergillus et les Candida. Elle peut être utilisée par voie veineuse ou sous forme de collyre à 0,1 mg/ml fabriqué par une pharmacie hospitalière. Récemment, la micafungine a été utilisée avec succès dans le traitement des kératites à Candida [27].
La flucytosine ou 5-fluorocytosine (Ancotil®) est principalement active sur les levures (Candida, Cryptococcus) et certaines souches d’Aspergillus, Penicillium, Cladosporium. L’acquisition de résistances secondaires est rapide de sorte qu’une association avec l’amphotéricine B est nécessaire lors d’un traitement prolongé. Un collyre à 1 % est disponible, mais il pénètre mal l’épithélium cornéen.
En pratique, le traitement médical est déterminé en fonction de l’identification du champignon pathogène, de ses CMI et de l’aspect clinique initial (tableau 6-16). Il n’existe pas de consensus international sur la molécule ou l’association de molécules à utiliser [28].
Les corticoïdes sont contre-indiqués à la phase précoce de l’infection. L’hospitalisation est nécessaire dans la plupart des cas comportant une atteinte stromale. Dans tous les cas, le traitement est administré à raison d’une goutte toutes les 5 minutes la première heure, puis une goutte par heure y compris la nuit pendant 48 heures. La posologie et le choix des antifongiques sont ensuite adaptés en fonction de l’évolution des paramètres infectieux, inflammatoires et de la toxicité liée aux collyres renforcés. La tolérance des traitements systémiques sera au mieux surveillée par un médecin infectiologue. La durée minimale de traitement recommandée est comprise entre 6 semaines (atteinte épithéliale) et plusieurs mois (atteinte stromale).
Tableau 6-15 Principales molécules antifongiques utilisées pour le traitement des kératomycoses.
DCI : dénomination commune internationale.
Tableau 6-16 Exemple de protocole antifongique utilisé pour le traitement des kératomycoses.
Le débridement régulier de l’ulcère, quotidien au début puis 2 fois par semaine, permet de diminuer la charge infectieuse, d’éliminer le matériel nécrotique et d’augmenter l’efficacité des antifongiques. Un traitement véritablement chirurgical peut être envisagé en urgence :
-
greffe lamellaire antérieure ou kératectomie afin de diminuer la charge infectieuse [29] ;
-
greffe de cornée transfixiante en cas de progression de l’infection (greffe thérapeutique), de perforation imminente ou avérée (greffe architectonique) ;
-
colle cyanoacrylate en cas de perforation de petite taille ;
-
recouvrement conjonctival en cas d’atteinte extensive ;
-
énucléation en cas d’endophtalmie résistante au traitement médical ;
-
le crosslinking cornéen est en cours d’évaluation dans la prise en charge des kératomycoses à la phase aiguë de l’infection [30–32].
Toutefois, la kératoplastie lamellaire ou transfixiante permettant la réhabilitation visuelle sera idéalement réalisée à distance de l’infection.
Les paramètres cliniques à surveiller de façon quotidienne ou biquotidienne sont : l’acuité visuelle, les signes fonctionnels, l’infiltrat principal (taille, profondeur), les lésions satellites, l’état de cicatrisation épithéliale. L’inflammation intraoculaire peut être fluctuante même en cas d’amélioration (libération d’antigènes fongiques sous l’influence du traitement).
L’évolution est toujours très lente sur plusieurs semaines à plusieurs mois. Des photographies répétées de la cornée sont utiles pour déterminer l’existence ou non d’une amélioration. Les levures sont difficiles à traiter en raison de l’atteinte cornéenne sous-jacente et les champignons filamenteux du fait de leur virulence naturelle. Le pronostic des kératomycoses est habituellement mauvais : l’évolution est favorable grâce au traitement médical dans 50 à 70 % des cas. Cependant, ces infections peuvent entraîner la perte du globe oculaire (10–25 %). Lorsque ce n’est pas le cas, une greffe de cornée est nécessaire dans environ 30 à 50 % des cas, mais cette proportion varie en fonction des centres et des pays [4, 33–36]. Les facteurs de mauvais pronostic incluent : l’âge élevé du patient, la taille de l’infiltrat, la taille du défect épithélial, l’importance de la baisse de vision lors de la prise en charge initiale, une pigmentation de l’ulcère [37], la présence de lésions satellites ou d’un hypopion [38], des CMI élevées [39].
[1] Thomas PA. Fungal infections of the cornea. Eye (Lond) 2003 ; 17 : 852-62.
[2] Gower EW, Keay LJ, Oechsler RA, et al. Trends in fungal keratitis in the United States, 2001 to 2007. Ophthalmology 2010 ; 117 : 2263-7.
[3] Gaujoux T, Borsali E, Goldschmidt P, et al. Fungal keratitis in France. Acta Ophthalmol 2011 ; 89 : e215-216.
[4] Jurkunas U, Behlau I, Colby K. Fungal keratitis : changing pathogens and risk factors. Cornea 2009 ; 28 : 638-43.
[5] Thomas PA, Kaliamurthy J. Mycotic keratitis : epidemiology, diagnosis and management. Clin Microbiol Infect 2013 ; 19 : 210-20.
[6] Zhong W, Yin H, Xie L. Expression and potential role of major inflammatory cytokines in experimental keratomycosis. Mol Vis 2009 ; 15 : 1303-11.
[7] Karthikeyan RS, Leal SM, Jr., Prajna NV, et al. Expression of innate and adaptive immune mediators in human corneal tissue infected with Aspergillus or fusarium. J Infect Dis 2011 ; 204 : 942-50.
[8] Mukherjee PK, Chandra J, Yu C, et al. Characterization of fusarium keratitis outbreak isolates : contribution of biofilms to antimicrobial resistance and pathogenesis. Invest Ophthalmol Vis Sci 2012 ; 53 : 4450-7.
[9] Sauer A, Abry F, Lhermitte B, et al. Purulent corneal melting secondary to multidrug-resistant Fusarium oxysporum aggravated by topical corticosteroid therapy. J Fr Ophtalmol 2008 ; 31 : 534e1-5.
[10] Ganguly S, Salma KC, Kansakar I, et al. Pattern of fungal isolates in cases of corneal ulcer in the western periphery of Nepal. Nepal J Ophthalmol 2011 ; 3 : 118-22.
[11] Bullock JD, Khamis HJ. A retrospective statistical analysis of the Fusarium keratitis epidemic of 2004-2006. Ophthalmic Epidemiol 2010 ; 17 : 179-84.
[12] Bullock JD, Warwar RE, Elder BL, Northern WI. Temperature instability of ReNu With MoistureLoc : a new theory to explain the worldwide Fusarium keratitis epidemic of 2004-2006. Arch Ophthalmol 2008 ; 126 : 1493-8.
[13] Yildiz EH, Abdalla YF, Elsahn AF, et al. Update on fungal keratitis from 1999 to 2008. Cornea 2010 ; 29 : 1406-11.
[14] Labbe A, Khammari C, Dupas B, et al. Contribution of in vivo confocal microscopy to the diagnosis and management of infectious keratitis. Ocul Surf 2009 ; 7 : 41-52.
[15] Takezawa Y, Shiraishi A, Noda E, et al. Effectiveness of in vivo confocal microscopy in detecting filamentous fungi during clinical course of fungal keratitis. Cornea 2010 ; 29 : 1346-52.
[16] Shapiro BL, Lalitha P, Loh AR, et al. Susceptibility testing and clinical outcome in fungal keratitis. Br J Ophthalmol 2010 ; 94 : 384-5.
[17] Tananuvat N, Salakthuantee K, Vanittanakom N, et al. Prospective comparison between conventional microbial work-up vs PCR in the diagnosis of fungal keratitis. Eye (Lond) 2012 ; 26 : 1337-43.
[18] Goldschmidt P, Degorge S, Che Sarria P, et al. New strategy for rapid diagnosis and characterization of fungal infections : the example of corneal scrapings. PLoS One 2012 ; 7 : e37660.
[19] He D, Hao J, Zhang B, et al. Pathogenic spectrum of fungal keratitis and specific identification of Fusarium solani. Invest Ophthalmol Vis Sci 2011 ; 52 : 2804-8.
[20] Li L, Wang Z, Li R, et al. In vitro evaluation of combination antifungal activity against Fusarium species isolated from ocular tissues of keratomycosis patients. Am J Ophthalmol 2008 ; 146 : 724-8.
[21] Prajna NV, Krishnan T, Mascarenhas J, et al. The mycotic ulcer treatment trial : a randomized trial comparing natamycin vs voriconazole. JAMA Ophthalmol 2013 ; 131 : 422-9.
[22] Arora R, Gupta D, Goyal J, Kaur R. Voriconazole versus natamycin as primary treatment in fungal corneal ulcers. Clin Experiment Ophthalmol 2011 ; 39 : 434-40.
[23] Troke P, Obenga G, Gaujoux T, et al. The efficacy of voriconazole in 24 ocular Fusarium infections. Infection 2013 ; 41 : 15-20.
[24] Prakash G, Sharma N, Goel M, et al. Evaluation of intrastromal injection of voriconazole as a therapeutic adjunctive for the management of deep recalcitrant fungal keratitis. Am J Ophthalmol 2008 ; 146 : 56-9.
[25] Sharma N, Chacko J, Velpandian T, et al. Comparative evaluation of topical versus intrastromal voriconazole as an adjunct to natamycin in recalcitrant fungal keratitis. Ophthalmology 2013 ; 120 : 677-81.
[26] Shen YC, Wang CY, Tsai HY, Lee HN. Intracameral voriconazole injection in the treatment of fungal endophthalmitis resulting from keratitis. Am J Ophthalmol 2010 ; 149 : 916-21.
[27] Matsumoto Y, Murat D, Kojima T, et al. The comparison of solitary topical micafungin or fluconazole application in the treatment of Candida fungal keratitis. Br J Ophthalmol 2011 ; 95 : 1406-9.
[28] FlorCruz NV, Peczon IV, Evans JR. Medical interventions for fungal keratitis. Cochrane Database Syst Rev 2012 ; 2 : CD004241.
[29] Lin HC, Lin JL, Lin-Tan DT, et al. Early keratectomy in the treatment of moderate Fusarium keratitis. PLoS One 2012 ; 7 : e42126.
[30] Sauer A, Letscher-Bru V, Speeg-Schatz C, et al. In vitro efficacy of antifungal treatment using riboflavin/UV-A (365 nm) combination and amphotericin B. Invest Ophthalmol Vis Sci 2010 ; 51 : 3950-3953.
[31] Price MO, Tenkman LR, Schrier A, et al. Photoactivated riboflavin treatment of infectious keratitis using collagen cross-linking technology. J Refract Surg 2012 ; 28 : 706-13.
[32] Galperin G, Berra M, Tau J, et al. Treatment of fungal keratitis from Fusarium infection by corneal cross-linking. Cornea 2012 ; 31 : 176-180.
[33] Prajna NV, Mascarenhas J, Krishnan T, et al. Comparison of natamycin and voriconazole for the treatment of fungal keratitis. Arch Ophthalmol 2010 ; 128 : 672-8.
[34] Tuft SJ, Tullo AB. Fungal keratitis in the United Kingdom 2003-2005. Eye (Lond) 2009 ; 23 : 1308-13.
[35] Oechsler RA, Yamanaka TM, Bispo PJ, et al. Fusarium keratitis in Brazil : genotyping, in vitro susceptibilities, and clinical outcomes. Clin Ophthalmol 2013 ; 7 : 1693-701.
[36] Rogers GM, Goins KM, Sutphin JE, et al. Outcomes of treatment of fungal keratitis at the University of Iowa Hospitals and Clinics : a 10-year retrospective analysis. Cornea 2013 ; 32 : 1131-6.
[37] Prajna NV, Krishnan T, Mascarenhas J, et al. Predictors of outcome in fungal keratitis. Eye (Lond) 2012 ; 26(9) : 1226-31.
[38] Ramakrishnan T, Constantinou M, Jhanji V, Vajpayee RB. Factors affecting treatment outcomes with voriconazole in cases with fungal keratitis. Cornea 2013 ; 32 : 445-9.
[39] Lalitha P, Prajna NV, Oldenburg CE, et al. Organism, minimum inhibitory concentration, and outcome in a fungal corneal ulcer clinical trial. Cornea 2012 ; 31 : 662-7.















